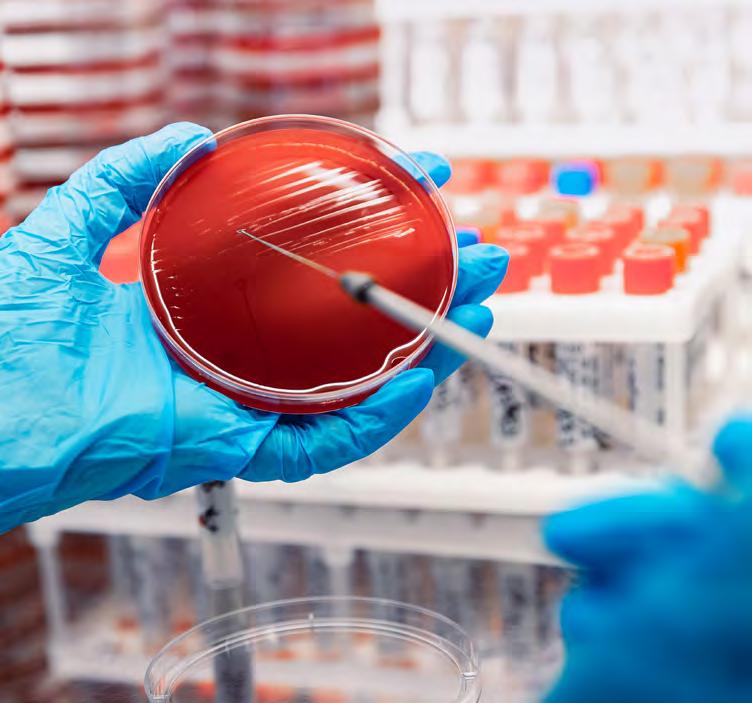

Prifysgol Bangor - Adroddiad Blynyddol a Datganiadau Ariannol Y flwyddyn yn diweddu 31 Gorffennaf 2022


Prifysgol Bangor - Adroddiad Blynyddol a Datganiadau Ariannol Y flwyddyn yn diweddu 31 Gorffennaf 2022
Rwy’n hynod falch o’r hyn y llwyddwyd i’w gyflawni ym Mhrifysgol Bangor yn ystod cyfnod y pandemig Covid-19 ac, ar ran y Cyngor, hoffwn ddiolch i’n holl staff am eu proffesiynoldeb, eu cadernid a pha mor gadarnhaol y buont, a diolch i hefyd i’n myfyrwyr am eu gwytnwch a’u hymrwymiad wrth i ni ymgyfarwyddo bellach â gweithredu yn y byd ‘normal newydd’.
Cafwyd dathlu llwyddiant gwerth tair blynedd o fyfyrwyr mewn gŵyl dair wythnos o seremonïau graddio ym mis Gorffennaf 2022, ac roedd yn ddathliad nid yn unig i’n cyn-fyfyrwyr newydd ond hefyd i holl gymuned y Brifysgol a gefnogodd y myfyrwyr hynny i lwyddo. Ac wrth i ni ddechrau ar flwyddyn academaidd newydd, mae’n galonogol gweld bywiogrwydd yn dychwelyd i’n campysau.
Er gwaethaf cynnwrf Covid-19, mae’r Brifysgol wedi wynebu pob her, gan weithio gyda phwrpas cyffredin i gefnogi’r cyfeiriad a nodir yn Strategaeth 2030. Mae ein cynlluniau i sefydlu ysgol feddygol annibynnol yng Ngogledd Cymru gyda chefnogaeth Llywodraeth Cymru yn mynd rhagddynt yn dda wrth i’r Brifysgol baratoi i gwblhau ei hachos i gael ei hachredu gan y Cyngor Meddygol Cyffredinol. Fel y nodir yng nghynllun hirdymor y Llywodraeth ar gyfer iechyd a gofal cymdeithasol – Cymru Iachachmae angen i ni sicrhau newid sylweddol yn iechyd ein poblogaeth trwy weithredu dull gydol oes sy’n canolbwyntio ar iechyd ataliol. Bu sefydlu ysgol feddygol ryngddisgyblaethol ym Mhrifysgol Bangor yn uchelgais ers diwedd yr Ail Ryfel Byd. Heddiw, bydd Ysgol Feddygol Gogledd Cymru, mewn partneriaeth â Bwrdd Iechyd Betsi Cadwaladr, yn cyflawni rôl bwysicach nag erioed o’r blaen, gan fynd i’r afael â heriau recriwtio meddygol ar draws y rhanbarth drwy hyfforddi gweithlu’r dyfodol.

Mae safle Bangor yn y Fframwaith Rhagoriaeth
Ymchwil (2021) yn
tanlinellu ein perfformiad
rhagorol gydag 85% o’n
hymchwil gyda’r gorau yn y byd neu’n rhagorol yn
rhyngwladol.
Rydym yn falch o fod yn brifysgol ddwyieithog mewn
rhanbarth a chenedl ddwyieithog ac mae ein Prifysgol yn parhau i wneud ei marc ar fywyd deallusol a diwylliannol Cymru, y Deyrnas Unedig a’r byd. Mae safle Bangor yn y Fframwaith Rhagoriaeth Ymchwil
(2021) yn tanlinellu ein perfformiad rhagorol gydag 85%
o’n hymchwil gyda’r gorau yn y byd neu’n rhagorol yn rhyngwladol. Mae’n gryn lwyddiant cael ein cydnabod ymhlith y 30 uchaf yn y Deyrnas Unedig am effaith
gymdeithasol ein hymchwil, gyda Systemau Daear a Gwyddorau’r Amgylchedd yn gyntaf yn y Deyrnas
Unedig am effaith eu hymchwil. Mae bod yn ail yn gyffredinol yng Nghymru ac yn y 50 uchaf yn y Deyrnas
Unedig yn newyddion rhagorol. Mae’n amlwg fod
Prifysgol Bangor yn darparu buddion cymdeithasol, diwylliannol ac amgylcheddol sy’n newid y byd, o ddatblygiadau mewn gofal iechyd i ymgodymu â newid amgylcheddol byd-eang, a dod o hyd i atebion ynni’r dyfodol.
Mae’r Brifysgol wedi gwneud cynnydd da yng
nghanlyniadau diweddaraf yr Arolwg Cenedlaethol
Myfyrwyr, ac wedi ei gosod yn yr 20 uchaf trwy’r
Deyrnas Unedig, yn safle 19, i fyny 54 safle o gymharu â’r llynedd, gan gyflawni cyfradd boddhad cyffredinol o 81%, sy’n gynnydd o 6%. Mae gennym ragor o waith i’w wneud i sicrhau ein bod yn cyrraedd y safonau uchel yr ydym wedi eu gosod i ni’n hunain er mwyn sicrhau bod myfyrwyr yn parhau i gael y profiad myfyrwyr y maent yn ei ddisgwyl pan fyddant yn ymuno â’n cymuned.
Yn sgil y rhyfel yn Wcráin, ymunodd y Brifysgol â chynllun uwch-noddwr Llywodraeth Cymru gan ailbwrpasu un o’n neuaddau preswyl yn llety tymor byr. Gan weithio mewn partneriaeth â Chyngor Gwynedd, Bwrdd Iechyd Prifysgol Betsi Cadwaladr a’r darparwr tai cymdeithasol, Clwyd Alyn, rydym wedi croesawu mwy nag 80 o Wcrainiaid i’r campws. Yn unol â’r hanes balch sydd gennym yng Nghymru fel Cenedl Noddfa bu’n fraint i ni groesawu’r ffoaduriaid hyn ar adeg o ddirfawr angen.
Er bod ein datganiadau ariannol yn adrodd am gyfres gref o ganlyniadau, nid ydynt yn adlewyrchu heriau chwyddiant uchel, a chostau uwch ynni a benthyca a fydd yn rhoi pwysau ychwanegol ar y Brifysgol yn y blynyddoedd nesaf. Ar hyn o bryd rydym yn cynnal adolygiad o Gyngor y Brifysgol ac o effeithiolrwydd ei strwythurau llywodraethu i sicrhau ein bod yn gallu cefnogi cynaliadwyedd a dyfodol hirdymor y sefydliad yn effeithiol.
Dros y flwyddyn ddiwethaf, mae’r Cyngor wedi ceisio sicrhau bod gweledigaeth a nodau cynllun strategol y Brifysgol yn parhau’n berthnasol. Mae’r Brifysgol wedi elwa’n fawr o arweinyddiaeth gadarn a llawn gweledigaeth yr Athro Iwan Davies a wnaeth ymddeol fel Is-ganghellor ym mis Medi 2022.
Bu i mi arwain ar benodi olynydd iddo, proses a gafodd ei rheoli gan y cwmni o ben-helwyr annibynnol, Perret Laver. Mae’n bleser mawr gennyf groesawu’r Isganghellor newydd ac edrychaf ymlaen at weithio gyda’r Athro Edmund Burke i ategu’r cyfeiriad y bydd ef yn ei osod ar gyfer y sefydliad dros y cyfnod nesaf. Rwy’n hyderus bod gennym y strategaeth, yr arweinyddiaeth a’r drefn lywodraethu i wireddu ein nodau uchelgeisiol gyda’n gilydd, fel Prifysgol ac iddi galon Gymreig ac agwedd ranbarthol, cenedlaethol a byd-eang.
Marian Wyn Jones Cadeirydd y CyngorY Cyngor yw corff llywodraethol y Brifysgol. Mae’n gyfrifol am gyllid, ystadau, buddsoddiadau a busnes cyffredinol y brifysgol ac am bennu cyfeiriad strategol y sefydliad. Mae’r Cyngor yn ceisio gwneud ei waith yn unol â’r saith egwyddor a nodwyd gan y Pwyllgor Safonau mewn Bywyd Cyhoeddus (anhunanoldeb, uniondeb, gwrthrychedd, atebolrwydd, bod yn agored, gonestrwydd ac arweinyddiaeth).
Mae pob un o aelodau’r Cyngor yn ymddiriedolwyr y Brifysgol, sy’n elusen, ac maent i gyd yn rhoi o’u hamser yn ddi-dâl, gan gyfrannu at drafodaethau a phenderfyniadau’r sefydliad.
Mae’r Cyngor yn parhau i nodi gofynion y cod ymarfer ar lywodraethu fel y nodir yng Nghod
Llywodraethu Addysg Uwch y Pwyllgor
Cadeiryddion Prifysgolion (Medi 2020) a gofynion Adolygiad Camm o Lywodraethu
Prifysgolion yng Nghymru (Rhagfyr 2019).
Mae’r Cyngor yn adolygu’r materion hyn yn rheolaidd fel rhan o fusnes y Pwyllgor
Enwebiadau a Llywodraethu. Derbyniodd y Pwyllgor gynllun gweithredu wedi’i ddiweddaru i nodi cynnydd ym mhob cyfarfod yn ystod 2021/22. Mae’r Brifysgol bellach wedi gweithredu argymhellion Adolygiad
Camm (lle nad oedd y Brifysgol eisoes yn cydymffurfio a phan fo o fewn pwerau’r Brifysgol i wneud hynny). Fodd bynnag, bydd yn parhau i adolygu’r materion hyn.
Mae’r Cyngor yn ceisio sicrhau gwelliannau parhaus wrth lywodraethu ac yn adolygu effeithiolrwydd y drefn lywodraethu’n rheolaidd. Cwblhawyd yr adolygiad effeithiolrwydd llywodraethu diweddaraf

yn 2018/19 a rhoddwyd cynllun gweithredu ar waith gyda’r holl gamau gweithredu yn cael eu cwblhau a’u hadrodd i’r Cyngor. Mae adolygiad effeithiolrwydd pellach eisoes
wedi’i drefnu ar gyfer 2022/23. Bydd hyn yn cael ei oruchwylio gan y Pwyllgor Enwebiadau a Llywodraethu, ac yn ystod yr Adolygiad ei hun gan Grŵp Strategaeth llai ei faint.
Nodir y materion a neilltuir yn arbennig i’w penderfynu gan y Cyngor yn Siarter a Statudau’r Brifysgol, trwy arfer ac o dan y Cod Rheolaeth Ariannol gyda Chyngor Cyllido Addysg Uwch Cymru.
Mae swyddogaethau’r Canghellor, Cadeirydd y Cyngor, y Dirprwy Ganghellor yn rhai ar wahân i swyddogaeth Prif Weithredwr y Brifysgol, sef yr Is-ganghellor. Daw mwyafrif aelodau’r Cyngor o’r tu allan i’r Brifysgol (disgrifir hwy fel aelodau annibynnol). Rhaid dewis Cadeirydd y Cyngor o blith yr aelodau lleyg. Mae aelodau annibynnol yn rhoi o’u hamser i’r Brifysgol yn ddi-dâl. Hefyd ymhlith yr aelodau mae aelodau o’r Senedd, ac aelodau o staff academaidd ac anacademaidd, yn ogystal ag aelodau’n cynrychioli Undeb y Myfyrwyr.
Mae’r Cyngor yn cyfarfod bum gwaith y flwyddyn ond ymdrinnir â llawer o’i waith manwl gan bwyllgorau sefydlog y Cyngor yn y lle cyntaf. Mae gan y Cyngor bum pwyllgor sefydlog (Cyllid a Strategaeth, Archwilio a Risg, Enwebiadau a Llywodraethu, Iechyd a Diogelwch a Phobl a Diwylliant), ac mae pob Pwyllgor wedi’i gyfansoddi’n ffurfiol â chylch gorchwyl ac aelodaeth sy’n cynnwys aelodau annibynnol o’r Cyngor. Mae’r Pwyllgor Enwebiadau a Llywodraethu yn gofyn am sicrwydd blynyddol gan bob Pwyllgor eu bod wedi gweithredu o dan ofynion eu Cylch Gorchwyl yn ystod y flwyddyn academaidd flaenorol.
Nodir isod aelodaeth y Cyngor, ac aelodaeth y Pwyllgorau ynghyd â’r ffigurau presenoldeb ar gyfer blwyddyn academaidd 2021/22.
Enw a Swydd Pwyllgorau Cyfredol
Cadeirydd y Cyngor
Mrs Marian Wyn Jones (tan 8 Chwefror 2025)
Dirprwy Ganghellor a Dirprwy
Gadeirydd
Yr Athro Gareth Roberts (tan 31 Rhagfyr 2022)
Aelodau Ex officio o’r Cyngor
Yr Is-ganghellor
Yr Athro Iwan Davies (tan 31 Awst 2022)
Yr Athro Edmund Burke (o 1 Medi 2022)
Dirprwy i’r Is-ganghellor
Yr Athro Oliver Turnbull
Llywydd, Undeb y Myfyrwyr
Mr James Avison (tan 30 Mehefin 2022)
Ms Nyah Lowe (o 1 Gorffennaf 2022)
Llywydd, UMCB
Mr Mabon Dafydd (tan 30 Mehefin 2022)
Mr Celt John (o 1 Gorffennaf 2022)
Penodwyd gan y Senedd
Pwyllgor Enwebiadau a Llywodraethu (Cadeirydd), Fforwm Ymgysylltu ar y Cyd (Cadeirydd)
Pwyllgor Pobl a Diwylliant
Pwyllgor Cyllid a Strategaeth
Pwyllgor Taliadau
Pwyllgor Iechyd a Diogelwch (Cadeirydd), Pwyllgor Materion y Gymraeg (Cadeirydd)
Pwyllgor Archwilio a Risg
Pwyllgor Enwebiadau a Llywodraethu
Fforwm Ymgysylltu ar y Cyd
Pwyllgor Materion y Gymraeg
Pwyllgor Enwebiadau a Llywodraethu
Pwyllgor Cyllid a Strategaeth
Fforwm Ymgysylltu ar y Cyd
Pwyllgor Enwebiadau a Llywodraethu
Fforwm Ymgysylltu ar y Cyd
Pwyllgor Cyllid a Strategaeth
Pwyllgor Cyllid a Strategaeth
Pwyllgor Enwebiadau a Llywodraethu
Pwyllgor Materion y Gymraeg Pwyllgor Archwilio a
Presenoldeb yn y Cyngor (5 cyfarfod fesul blwyddyn galendr)
Enw a Swydd Pwyllgorau Cyfredol Presenoldeb yn y Cyngor (5 cyfarfod fesul blwyddyn galendr)
Aelodau Annibynnol
Ms Julie Perkins (tan 31 Hydref 2024)
Yr Athro Timothy Wheeler (o 4 Mai 2022)
Dr Griff Jones (tan 30 Tachwedd 2021)
Mrs Alison Lea-Wilson MBE (tan 31 Gorffennaf 2023)
Dr Ian Rees (tan 31 Gorffennaf 2023)
Syr Paul Lambert (tan 31 Awst 2024)
Pwyllgor Cyllid a Strategaeth
Pwyllgor Enwebiadau a Llywodraethu
Pwyllgor Cyllid a Strategaeth
Pwyllgor Archwilio a Risg
Pwyllgor Archwilio a Risg
Pwyllgor Enwebiadau a Llywodraethu
Pwyllgor Materion y Gymraeg
Pwyllgor Archwilio a Risg
Pwyllgor Enwebiadau a Llywodraethu
Pwyllgor Materion y Gymraeg
Pwyllgor Pobl a Diwylliant (Cadeirydd)
Pwyllgor Cyllid a Strategaeth (Cadeirydd)
Pwyllgor Pobl a Diwylliant
Fforwm Ymgysylltu ar y Cyd
Pwyllgor Taliadau
5/5
2/2
2/2
5/5
Dr Llion Jones (hyd 31 Awst 2023) Pwyllgor Enwebiadau a Llywodraethu
Dr Lynne Williams (tan 31 Gorffennaf 2022)
Penodwyd gan Staff
Dr Myfanwy Davies (tan 30 Medi 2023)
Mr Paul Wood (o 12 Ebrill 2022)
Pwyllgor Cyllid a Strategaeth
Pwyllgor Enwebiadau a Llywodraethu
Pwyllgor Iechyd a Diogelwch
Pwyllgor Pobl a Diwylliant
Mr Marc P. Jones (tan 31 Awst 2024)
Mr Eric Hepburn CBE (tan 31 Hydref 2024)
Mr Atul Devani (tan 31 Hydref 2024)
Mr Kailesh Karavadra (tan 31 Hydref 2024)
Yr Athro Jean White (o 31 Hydref 2021)
Ysgrifennydd y Cyngor: Mrs Gwenan Hine
Pwyllgor Cyllid a Strategaeth
Is-bwyllgor Buddsoddi (Cadeirydd)
Pwyllgor Archwilio a Risg (Cadeirydd)
Pwyllgor Iechyd a Diogelwch
Pwyllgor Taliadau
Pwyllgor Archwilio a Risg
Pwyllgor Cyllid a Strategaeth (tan 04 Mai 2022)
Pwyllgor Pobl a Diwylliant
Pwyllgor Archwilio a Risg
Pwyllgor Iechyd a Diogelwch
Pwyllgor Pobl a Diwylliant
Pwyllgor Enwebiadau a Llywodraethu (Ysgrifennydd)
Pwyllgor Materion y Gymraeg (Ysgrifennydd)
Pwyllgor Pobl a Diwylliant (Ysgrifennydd)
Fforwm Ymgysylltu ar y Cyd (Ysgrifennydd)
Pwyllgor Iechyd a Diogelwch (Ysgrifennydd)
Aelodau Annibynnol y Cyngor / Amrywiaeth a Chynwysoldeb y Corff Llywodraethol
Daw aelodau annibynnol y Cyngor o’r sectorau preifat a chyhoeddus gan ddod â chyfoeth o brofiad ac arbenigedd proffesiynol i’r Cyngor. Mae’r Cyngor wedi ymrwymo i hyrwyddo cydraddoldeb ac amrywiaeth a chaiff pob hysbyseb am aelodau annibynnol eu hysbysebu’n allanol a chroesawir ceisiadau’n arbennig gan grwpiau sydd heb gynrychiolaeth ddigonol.
Ystyrir ceisiadau gan y Pwyllgor Enwebiadau a Llywodraethu a chânt eu hystyried yn erbyn yn y matrics sgiliau cyfredol a gwnaed hynny ddiwethaf yn haf 2022. Nid yw’r un o’r aelodau annibynnol yn derbyn unrhyw dâl am y gwaith a wnânt i’r Brifysgol, ac eithrio ad-daliad o’r treuliau. Mae’r holl aelodau a benodir i’r Cyngor yn gwasanaethu am gyfnod o 4 blynedd, ond gellir eu hailbenodi am gyfnod o 8 mlynedd ar y mwyaf.
Cwblheir archwiliad sgiliau gan bob aelod o’r Cyngor yn flynyddol, gan alluogi’r Pwyllgor Enwebiadau a Llywodraethu i fapio sgiliau’r aelodau yn erbyn ehangder yr arbenigedd sydd ei angen o fewn aelodaeth y Cyngor, gyda’r gwaith o recriwtio am swyddi gwag wedyn yn seiliedig ar y sgiliau y mae’r Cyngor eu hangen.
Cynhaliwyd gweithdy Cydraddoldeb, Amrywiaeth a Chynhwysiant gan Advance HE yn rhithiol i holl aelodau’r Cyngor ar 28 Mawrth 2022. Nod y gweithdy oedd datblygu cyd-ddealltwriaeth ynglŷn â sut i greu Cyngor amrywiol sy’n goruchwylio ac yn ymgysylltu’n effeithiol â materion yn ymwneud â chydraddoldeb, amrywiaeth a chynhwysiant yn y sector addysg uwch drwy asesu cryfderau presennol a’r meysydd y mae angen i’r Cyngor eu datblygu. Caiff gwaith ar faterion yn ymwneud â chydraddoldeb, amrywiaeth a chynhwysiant ei oruchwylio, ar ran y Cyngor, gan y Pwyllgor Pobl a Diwylliant.
Cynefino Aelodau’r Cyngor
Mae’n ofynnol i aelodau newydd y Cyngor fynychu sesiwn gynefino fanwl gydag Ysgrifennydd y Brifysgol a Chadeirydd y Cyngor. Mae’r sesiwn gynefino honno’n cynnwys gwybodaeth am hanes Prifysgol Bangor, gwerthoedd y Brifysgol a’r fframwaith Llywodraethu a Rheoleiddio. Yn ogystal, gwahoddir aelodau newydd i arsylwi cyfarfod o’r Cyngor cyn ymuno fel aelod.
Adolygiadau datblygu blynyddol
Bydd Cadeirydd y Cyngor yn gweithio gyda phob aelod o’r Cyngor ar adolygiadau datblygu blynyddol unigol er mwyn sicrhau datblygiad parhaus a gwella effeithiolrwydd, yn ogystal â nodi gofynion a / neu gyfleoedd datblygu ychwanegol.
Yn A Review of Governance of the Universities in Wales, argymhellodd yr awdur Gillian Camm y dylid codi’r bar o ran annibyniaeth llywodraethwyr o gymharu â’r sefyllfa a fodolai pan gynhaliwyd yr adolygiad (2019) ac y dylid llunio a chyhoeddi canllawiau o ran yr hyn a olygir wrth annibyniaeth a’r materion hynny a allai gyfaddawdu annibyniaeth llywodraethwyr. Mae’r Brifysgol wedi mabwysiadu’r Guide on Independence for Lay Members a ddatblygwyd ac y cytunwyd arno gan Ysgrifenyddion a Chlercod Cymru ym mis Mehefin 2020 fel ymateb i’r argymhelliad hwn. Rhannwyd y Canllaw gydag aelodau’r Cyngor ac mae’n cael ei adolygu gan yr Pwyllgor Enwebiadau a Llywodraethu.
Fel corff llywodraethu’r Brifysgol, mae’r Cyngor yng ngofal arian cyhoeddus ac felly mae ganddo ddyletswydd arbennig i fodloni safonau uchaf llywodraethu corfforaethol bob amser. Cafodd prifysgolion eu cynnwys ymhlith y cyrff cyhoeddus sy’n cael eu harchwilio gan y ‘Pwyllgor Safonau mewn Bywyd Cyhoeddus’ (Pwyllgor Nolan) ac o ganlyniad mae’n rhaid i aelodau’r Cyngor gadw at Saith Egwyddor Bywyd Cyhoeddus a luniwyd gan y Pwyllgor, sef anhunanoldeb, uniondeb, gwrthrychedd, bod yn agored, gonestrwydd ac arweinyddiaeth.
Rhaid i aelodau’r Cyngor beidio â chaniatáu iddynt eu hunain gael eu dal na’u dylanwadu’n ormodol gan fuddiannau eraill sy’n gysylltiedig â’r Brifysgol megis staff, myfyrwyr, cyn-fyfyrwyr neu undebau llafur. Mae angen i aelodau’r Cyngor allu herio mewn modd effeithiol ac adeiladol ac ni allant wneud hynny os oes ganddynt fuddiant mewn mater sy’n cael ei drafod.
Datgan Buddiant
Mae’n ofynnol i aelodau’r Cyngor ddilyn gweithdrefn ffurfiol i ddatgan buddiant ar ddechrau pob blwyddyn academaidd, ac mae’r gofrestr ar gael ar-lein yma: https://www.bangor.ac.uk/cy/amdanom-ni/rheolaeth-a-llywodraethiant
Yn ychwanegol, gofynnir i aelodau ddatgan unrhyw wrthdaro buddiannau mewn perthynas ag eitemau ar yr agenda ar ddechrau pob cyfarfod o’r Cyngor a nodir y rhain yn ffurfiol yn y cofnodion.
Gwybodaeth Fywgraffyddol: Aelodau annibynnol o’r Cyngor
Gellir gweld manylion bywgraffyddol Aelodau Cyngor Prifysgol Bangor ar dudalennau gwe’r Brifysgol yma: https://www.bangor.ac.uk/cy/about/biogs
Ymgysylltu â Rhanddeiliaid
Mae’r Brifysgol yn gweithio’n agos gyda’r Cyngor i ymgysylltu â rhanddeiliaid ac yn ystod 2021/22 ail-gyfansoddwyd y pwyllgor ymgysylltu â rhanddeiliaid yn Fwrdd Cymunedol. Mae’r Bwrdd yn disodli’r Grŵp Cyswllt blaenorol, ac mae’n gweithredu fel llwyfan i ddwyn ynghyd ystod eang o randdeiliaid ym Mangor a Gogledd Orllewin Cymru. Mae’r Bwrdd newydd yn rhoi llwyfan i’r Brifysgol drafod materion strategol allweddol gyda rhanddeiliaid allanol, codi materion brys, nodi meysydd ar gyfer cydweithredu a dyfnhau a chryfhau cysylltiadau â phartneriaid yn y gymuned. Mae’r Bwrdd yn rhan allweddol o Genhadaeth Ddinesig y Brifysgol, gan helpu i wella a hyrwyddo lles ein cymunedau. Ymhellach, mae gan y Brifysgol ddull hyblyg o weithio gyda’r Cyngor i ymgysylltu â rhanddeiliaid, gan ddarparu diweddariadau a derbyn arweiniad ar brojectau a mentrau ad hoc sy’n cynnwys partneriaid penodol.
Yn ogystal, sefydlodd y Brifysgol Fforwm Ymgysylltu ar y Cyd ag Undebau Llafur y Campws yn gynnar yn 2021 i alluogi uwch aelodau annibynnol Cyngor y Brifysgol i ymgysylltu’n effeithiol ag Undebau Llafur y Campws ar bob agwedd o gylch gorchwyl a chyfrifoldebau’r Cyngor ac i rannu gwybodaeth a dealltwriaeth ynglŷn â materion strategol a gweithredol. Yn ogystal, mae’r Fforwm yn gyfle i drafod materion strategol allweddol, galluogi cynrychiolwyr Undebau Llafur y Campws i gael eu briffio ynglŷn â materion sy’n cael eu trafod ar hyn o bryd gan y Cyngor, a chaniatáu i gynrychiolwyr gyflwyno barn eu haelodau am y materion hynny cyn i unrhyw benderfyniadau gael eu gwneud gan y Cyngor.
Pwyllgor Enwebiadau a Llywodraethu - Cadeirydd
Mrs Marian Wyn Jones
Cadeirydd y Pwyllgor Enwebiadau a Llywodraethu yw Cadeirydd y Cyngor ac mae’n cynnwys tri aelod annibynnol o’r Cyngor, ynghyd â’r aelod Senedd sydd wedi gwasanaethu hwyaf ar y Cyngor a’r aelod staff academaidd ar y Cyngor. Mae Llywydd Undeb y Myfyrwyr yn ogystal ag uwch swyddogion y brifysgol hefyd yn aelodau.
Mae’r pwyllgor, ar ran y Cyngor, yn goruchwylio pedwar maes allweddol: Llywodraethiant y Brifysgol, Pwyllgorau’r Cyngor a’u haelodaeth, Cymrodoriaethau a Graddau er Anrhydedd a’r Adolygiad Effeithiolrwydd.
— Yn ystod blwyddyn academaidd 2021/22 cyfarfu’r Pwyllgor ar bedwar achlysur gan roi ystyriaeth ym mhob cyfarfod i aelodaeth y Cyngor, presenoldeb yng nghyfarfodydd y Cyngor, cynllunio olyniaeth mewn perthynas ag uwch-aelodau staff, aelodaeth o Isbwyllgorau’r Cyngor a’r cynnydd a wnaed gyda chynlluniau gweithredu mewn perthynas ag Adolygiad Camm, yr Adolygiad Effeithiolrwydd
Llywodraethu a Chod Llywodraethu Addysg Uwch y Pwyllgor Cadeiryddion Prifysgol. Yn ogystal, ystyriwyd yr eitemau canlynol yn ystod y flwyddyn:
• Cylch Gorchwyl Is-bwyllgorau’r Cyngor
• Adroddiadau Adolygiad Sicrwydd Blynyddol Is-bwyllgorau’r Cyngor
• Adolygiadau Datblygu Blynyddol: Aelodau’r Cyngor
• Diweddariadau am y cynllun gweithredu
• Trefniadau a diweddariadau’n ymwneud
â phenodi Is-ganghellor newydd;
• Trefniadau a diweddariad ar y trefniadau i enwebu Canghellor newydd
• Diweddariadau i’r Ordinhadau
• Y Cynllun Dirprwyo a Phwerau Gwneud
Penderfyniadau
Pwyllgor Taliadau – Cadeirydd
Yr Athro Gareth Roberts
Cadeirydd y Pwyllgor Taliadau yw Dirprwy Ganghellor y Brifysgol / Dirprwy Gadeirydd ac mae ei aelodaeth yn cynnwys Cadeirydd y Cyngor, Llywydd Undeb y Myfyrwyr, Cadeirydd y Pwyllgor Cyllid a Strategaeth, cynrychiolydd staff academaidd a thri aelod annibynnol o’r Cyngor. Mae ei gylch gorchwyl wedi ei bennu yn unol â Chod y Cyngor Cadeiryddion Prifysgol
(CUC). Mae’r pwyllgor yn penderfynu ac yn adolygu
tâl yr Is-ganghellor, aelodau’r Bwrdd Gweithredu a staff sydd ar gyflog o £100,000 a mwy, yn pennu’r strategaeth ar gyfer taliadau diswyddo i uwch-aelodau
staff y brifysgol ac yn ystyried adroddiadau ar gyflog cyfartal a chyflog yn ôl rhyw yn y brifysgol.
Yn ystod blwyddyn academaidd 2021/22 cyfarfu’r Pwyllgor ar ddau achlysur gan roi ystyriaeth i’r eitemau
canlynol:
Cylch gorchwyl y Pwyllgor
Cyflog yr Is-ganghellor
— Polisi Cyflogau Blynyddol
Adroddiad Taliadau
Cyflogau Uwch-aelodau Staff
Pwyllgor Iechyd a Diogelwch – Cadeirydd
Yr Athro Gareth Roberts
Mae’r Pwyllgor Iechyd a Diogelwch yn gyfrifol am gyflawni rhwymedigaethau cyfreithiol y Brifysgol mewn
perthynas â materion iechyd a diogelwch, am sicrhau bod camau rhesymol yn cael eu cymryd i hyrwyddo
iechyd a diogelwch staff, myfyrwyr, ymwelwyr
awdurdodedig ac aelodau’r cyhoedd sy’n dod i mewn
i’r Brifysgol yn gyfreithlon. Mae hefyd yn cynghori’r Brifysgol ar gwestiynau polisi iechyd a diogelwch, yn goruchwylio gweithrediad Polisi Iechyd a Diogelwch cymeradwy’r Brifysgol ac yn argymell i’r Cyngor unrhyw newidiadau sydd eu hangen. Cadeirir y Pwyllgor gan y Dirprwy Ganghellor / Dirprwy Gadeirydd, ac mae’n cynnwys aelod staff sydd ar y Cyngor, Llywydd Undeb y Myfyrwyr, yr Is-ganghellor a’r Dirprwy i’r Is-ganghellor yn ogystal â nifer o uwch swyddogion gweithredol a chynrychiolwyr iechyd a diogelwch o’r Colegau a’r Gwasanaethau Proffesiynol.
Yn ystod blwyddyn academaidd 2021/22 cyfarfu’r Pwyllgor ar ddau achlysur a thrafodwyd yr eitemau canlynol:
— Adroddiad Damweiniau, Digwyddiadau ac Achosion Arwyddocaol
— Adroddiad Covid-19 gan gynnwys asesiad risg a threfniadau lliniaru
— Adroddiad gan Undeb y Myfyrwyr
Adroddiad Blynyddol Iechyd a Diogelwch 2020/21
Adroddiad gan y Grŵp Tasg Iechyd, Diogelwch a Rheoli Argyfyngau
Adolygiad o Bolisi Iechyd a Diogelwch y Brifysgol
Yn ogystal, mae’r Is-bwyllgor Iechyd a Diogelwch
Ymbelydrol, a’r Is-bwyllgor Iechyd a Diogelwch
Cemegol a Biolegol yn adrodd i’r Pwyllgor Iechyd a Diogelwch.
Pwyllgor Materion y Gymraeg – Cadeirydd Professor Gareth Roberts
Mae Pwyllgor Materion y Gymraeg yn gyfrifol am hyrwyddo dwyieithrwydd ar ran y Cyngor, yn y Brifysgol, a hefyd mewn perthynas ag unrhyw un o amcanion y Brifysgol. Mae hefyd yn sicrhau y cydymffurfir â fframwaith deddfwriaethol y Gymraeg a Pholisi Iaith y Brifysgol. Mae’r Pwyllgor yn adrodd i’r Cyngor ac yn paratoi Adroddiad Blynyddol i’r Cyngor.
Cadeirir y pwyllgor gan y Dirprwy Ganghellor, ac mae’n cynnwys aelod annibynnol o’r Cyngor, Llywydd UMCB, aelod staff sydd ar y Cyngor yn ogystal ag uwch swyddogion perthnasol eraill o’r Brifysgol.
Yn ystod blwyddyn academaidd 2021/22 cyfarfu’r Pwyllgor ar dri achlysur a thrafodwyd yr eitemau canlynol:
Diweddariadau ynglŷn â Strategaeth 2030: Strategaeth y Gymraeg
Cyfleoedd Dysgu Cymraeg i Staff
Adroddiad Blynyddol Safonau’r Gymraeg
Data Cymraeg yr Asiantaeth Ystadegau Addysg Uwch
Adroddiad Blynyddol yr Uned Gyfieithu
Adroddiad gan Dysgu Cymraeg: Y Gogledd Orllewin
Yn ogystal, derbyniodd y Pwyllgor ddiweddariad gan Lywydd Undeb Myfyrwyr Cymraeg Bangor (UMCB), a Chofnodion Grŵp Strategaeth y Gymraeg ym mhob cyfarfod.
Pwyllgor Pobl a Diwylliant –
Dr Ian ReesPwyllgor Cyllid a Strategaeth – Cadeirydd
Syr Paul Lambert Mr Eric Hepburn Mrs Marian Wyn JonesRoedd y Pwyllgor Pobl a Diwylliant yn bwyllgor newydd o’r Cyngor yn 2021/22 ac mae’n gyfrifol am oruchwylio datblygiad a gweithrediad y themâu pobl a diwylliant yng Nghynllun Strategol y Brifysgol, gan dderbyn sicrwydd ynghylch cydymffurfiaeth â’r holl ddeddfwriaeth berthnasol, sicrhau bod gweithdrefnau trylwyr a thryloyw ar waith fel rhan o bolisïau’n ymwneud â chyflogeion a bod systemau ar waith a’u bod yn cael eu hadolygu’n barhaus a monitro sut y caiff strategaeth y Brifysgol ei chyflawni mewn perthynas ag amrywiaeth a chynwysoldeb, gan gynnwys cydraddoldeb hil a rhoi ystyriaeth i’r Cynllun Gweithredu Cydraddoldeb Hil. Yn ogystal, caiff y Pwyllgor ei ddiweddaru ynghylch hyfforddiant sy’n ymwneud â themâu pobl a diwylliant yn ogystal â derbyn diweddariadau ynglŷn â chyfraddau cwblhau adolygiadau datblygu perfformiad ac asesu effaith ar brofiad myfyrwyr. Mae’r Pwyllgor yn goruchwylio’r broses mewn perthynas â staff ar gontractau cyfnod penodol ac yn monitro gweithrediad arolygon staff a chynlluniau gweithredu cysylltiedig.
Caiff y Pwyllgor ei gadeirio gan aelod annibynnol o’r Cyngor, ac mae hefyd yn cynnwys Cadeirydd y Cyngor, Cadeirydd y Pwyllgor Cyllid a Strategaeth, yr Is-ganghellor, yr aelod staff anacademaidd sydd ar y Cyngor, Llywydd Undeb y Myfyrwyr a dau aelod annibynnol ychwanegol o’r Cyngor.
Yn ystod blwyddyn academaidd 2021/22 cyfarfu’r Pwyllgor ar ddau achlysur a thrafodwyd y materion canlynol:
Aelodaeth a chylch gorchwyl y Pwyllgor
Diweddariad am y Strategaeth: Strategaeth Pobl yn Gyntaf
Adroddiad Blynyddol: Yr Adain Pobl a Diwylliant
Morâl Staff
Diweddariad am yr Arolwg Staff
Yn ogystal, trafodwyd yr eitemau canlynol ym mhob cyfarfod:
Cofnodion a Diweddariadau gan y Grŵp Tasg
Adnoddau Dynol
Log deddfwriaeth a diweddariad am
ddeddfwriaeth berthnasol
Adroddiad ar recriwtio, trosiant a gwaith achos
Ceisiadau am statws Athro Emeritws
Adolygu contractau cyfnod penodol
Mae’r Pwyllgor Cyllid a Strategaeth yn cwrdd chwe gwaith y flwyddyn ac mae’n gyfrifol am adolygu, ar ran y Cyngor, iechyd ariannol cyffredinol y sefydliad a pherfformiad y Brifysgol yn erbyn ei strategaethau
arfaethedig yn ogystal â chadw trosolwg a gwneud argymhellion ar gyfeiriad strategol a strategaeth
ariannol y Brifysgol. Caiff y Pwyllgor ei gadeirio gan
aelod annibynnol o’r Cyngor, ac mae hefyd yn cynnwys
Cadeirydd y Cyngor, yr Is-ganghellor, y Dirprwy i’r Isganghellor, Llywydd Undeb y Myfyrwyr, aelod staff sydd ar y Cyngor a thri aelod annibynnol ychwanegol o’r Cyngor.
Mae dau is-grŵp sy’n adrodd i’r Pwyllgor: yr Isbwyllgor Buddsoddi sy’n cadw trosolwg dros bortffolio buddsoddiadau’r Brifysgol, a’r Bwrdd Craffu Rhaglenni Cyfalaf sy’n cadw trosolwg dros brif raglenni cyfalaf y Brifysgol.
Mae busnes y Pwyllgor yn cynnwys:
adolygiad blynyddol o strategaeth y Brifysgol
derbyn adroddiad perfformiad blynyddol ynglŷn
â’r dangosyddion perfformiad allweddol yng
nghynllun strategol y Brifysgol
adolygiad o ganlyniadau cylch cynllunio busnes
blynyddol y Brifysgol
monitro perfformiad ariannol y Brifysgol fesul
chwarter
adolygu cyfrifon blynyddol y Brifysgol ar ran y Cyngor
trosolwg o raglen gyfalaf y Brifysgol
trosolwg dros gyflwyniadau i gyrff statudol: cynllun ffioedd a mynediad HEFCW, rhagolygon ariannol HEFCW, ffurflen TRAC
gwneud argymhellion i’r Cyngor fel y prif
gyflogwr mewn materion sy’n ymwneud â phob
cynllun pensiwn
ystyried a phenderfynu ar yswiriant y Brifysgol, penodi bancwyr ac ymgynghorwyr ariannol eraill
Caiff y Pwyllgor Archwilio a Risg ei gadeirio gan aelod annibynnol o’r Cyngor ac mae’n cyfarfod bob chwarter. Mae’n cynnwys pum aelod lleyg o’r Cyngor a bydd archwilwyr mewnol ac allanol y Brifysgol yn
bresennol yn y cyfarfodydd. Mae’r pwyllgor yn ystyried adroddiadau ac argymhellion ar gyfer gwella systemau
rheoli mewnol y Brifysgol, ynghyd ag ymatebion y rheolwyr a chynlluniau gweithredu. Bydd aelodau’r
Bwrdd Gweithredu ac uwch-aelodau staff eraill yn
mynd i gyfarfodydd y Pwyllgor Archwilio a Risg, yn ôl yr angen.
Mae’r Pwyllgor yn cynghori’r Cyngor ar reoli risgiau a phenodi a thalu’r archwilwyr mewnol ac allanol. Yn unol
â’r Polisi Rheoli Risg, mae gan y Brifysgol brosesau ffurfiol ar waith i werthuso a rheoli risgiau sylweddol sy’n wynebu’r sefydliad. Bydd yn derbyn adroddiadau sy’n nodi dangosyddion perfformiad a risg allweddol ac yn ystyried materion posibl yn ymwneud â chamau rheoli y tynnir sylw atynt gan fecanweithiau rhybuddio cynnar sydd wedi eu hymgorffori o fewn unedau gweithredol y Brifysgol ac a atgyfnerthir gan hyfforddiant ymwybyddiaeth risg. Mae’r pwyslais ar gael mesur addas o sicrwydd ac nid ar adrodd yn ôl eithriadau yn unig. Mae’r pwyllgor yn ystyried dogfennaeth prosesau rheoli risg ac archwilio mewnol y Brifysgol, ac yn ystyried y pethau a ddigwyddodd ers diwedd y flwyddyn flaenorol.
Mae’r Fforwm Ymgysylltu ar y Cyd yn galluogi uwch aelodau annibynnol Cyngor y Brifysgol i ymgysylltu’n effeithiol ag Undebau Llafur y Campws ar bob agwedd o gylch gorchwyl a chyfrifoldebau’r Cyngor ac i rannu gwybodaeth a dealltwriaeth ynglŷn â materion strategol a gweithredol. Mae’r Fforwm hefyd yn gyfle i drafod materion strategol allweddol, galluogi cynrychiolwyr Undebau Llafur y Campws i gael eu briffio ynglŷn â materion sy’n cael eu trafod ar hyn o bryd gan y Cyngor, a chaniatáu i gynrychiolwyr gyflwyno barn eu haelodau am y materion hynny cyn i unrhyw benderfyniadau gael eu gwneud gan y Cyngor. Yn olaf, mae’r Fforwm yn darparu gwybodaeth, ac yn casglu sylwadau ac adborth ynglŷn â gweledigaeth, gwerthoedd, strategaeth a diwylliant y Brifysgol ynghyd â’r prif risgiau sy’n wynebu’r sefydliad.
Yn ystod 2021/22 cyfarfu’r Fforwm bum gwaith a thrafodwyd y materion a ganlyn:
Diweddariad ynglŷn â Chynllun Pensiwn yr USS
Diweddariad ynglŷn â Phleidlais yr UCU i Weithredu’n Ddiwydiannol;
Diweddariad ynglŷn â moderneiddio’r Ordinhadau / Statud;
Porthladd Rhydd Ynys Môn; Newidiadau i Yswiriant Gwladol a’r effaith ar gyllid y Brifysgol;
Y Polisi Dyrchafiadau.
Y Cyngor sy’n gyfrifol am y system camau rheoli mewnol sy’n cefnogi’r gwaith o gyflawni nodau ac amcanion y Brifysgol, gan ddiogelu cyllid cyhoeddus a chyllid arall. Cynlluniwyd systemau’r camau rheoli mewnol hyn i reoli, yn hytrach na dileu, risgiau sylweddol sy’n bygwth amcanion busnes y Brifysgol; felly dim ond sicrwydd rhesymol yn hytrach na sicrwydd absoliwt a geir rhag camddatganiad neu golled faterol berthnasol.
Mae’r Cyngor yn derbyn adroddiad blynyddol ar waith yr archwiliwr mewnol gan y Pwyllgor Archwilio a Risg. Mae hyn yn darparu sicrwydd ynglŷn ag effeithiolrwydd system camau rheoli mewnol a phrosesau rheoli risg a llywodraethu’r Brifysgol.
Ar gyfer y flwyddyn yn gorffen 31 Gorffennaf 2022 mae’r adroddiad yn mynegi barn foddhaol bod gan y brifysgol fframwaith digonol ac effeithiol ar gyfer rheoli risgiau, llywodraethu, camau rheoli a darbodaeth fewnol, effeithlonrwydd ac effeithiolrwydd, yn amodol ar nodi gwelliannau pellach i sicrhau ei fod yn parhau i fod yn ddigonol ac yn effeithiol. Mae’r Cyngor yn fodlon y bu hyn ar waith yn y flwyddyn yn gorffen 31 Gorffennaf 2021 a hyd at ddyddiad cymeradwyo’r adroddiad blynyddol, ei fod yn unol â chanllawiau HEFCW; a’i fod yn cael ei adolygu’n rheolaidd gan y Pwyllgor Archwilio a Risg ar ran y Cyngor. Ni chafodd unrhyw wendidau sylweddol eu nodi mewn perthynas â chamau rheoli yn y cyfnod.
Mae’r Cyngor yn fodlon bod gan y Brifysgol brosesau digonol ac effeithiol ar waith mewn perthynas â rheoli risgiau, camau rheoli a llywodraethiant; darbodaeth, effeithlonrwydd ac effeithiolrwydd; a rheoli a sicrhau ansawdd y data a gyflwynir i gyrff statudol - gan gofio na all unrhyw system camau rheoli mewnol ond darparu sicrwydd rhesymol, eithr nid diamod, rhag camddatganiad neu golled.
Mae elfennau allweddol system reoli gyllidol fewnol y Brifysgol, a gynlluniwyd i gyflawni’r cyfrifoldebau a nodwyd uchod, yn cynnwys y canlynol: diffiniadau eglur o gyfrifoldebau penaethiaid adrannau academaidd a gweinyddol a’r awdurdod a ddirprwywyd iddynt proses gynllunio gynhwysfawr tymor canolig a byr, wedi ei hategu â chyllidebau incwm, gwariant a chyfalaf blynyddol manwl
— adolygiadau rheolaidd o berfformiad academaidd ac adolygiadau chwarterol o ganlyniadau ariannol gan gynnwys adrodd ar amrywiant a diweddaru canlyniadau a ragwelwyd
gofynion a ddiffiniwyd ac a ffurfiolwyd yn eglur ar gyfer cymeradwyo a rheoli gwariant, gyda’r penderfyniadau buddsoddi sy’n cynnwys gwariant cyfalaf neu refeniw yn cael eu gwerthuso’n ffurfiol ac yn fanwl a’u hadolygu yn unol â lefelau cymeradwyo a bennir gan y Cyngor
— rheoliadau ariannol cynhwysfawr, yn nodi manylion am gamau rheoli a gweithdrefnau ariannol, wedi eu cymeradwyo gan y Pwyllgor
Archwilio a Risg a’r Pwyllgor Cyllid a Strategaeth swyddogaeth archwilio fewnol broffesiynol a drefnir trwy gontract allanol, y caiff ei rhaglen flynyddol ei chymeradwyo gan y Pwyllgor
Archwilio a Risg.
Y Senedd yw awdurdod academaidd y brifysgol a daw ei haelodaeth yn gyfan gwbl o blith staff academaidd a myfyrwyr y sefydliad. Yn ystod blwyddyn academaidd 2021/22 cyfarfu’r Senedd bedair gwaith. Mae aelodaeth y Senedd wedi ei bennu yn Ordinhad 12 a’r Is-ganghellor yw’r cadeirydd. Mae’r aelodaeth hefyd yn cynnwys y Dirprwy i’r Is-ganghellor, y Dirprwy Is-gangellorion, y Deoniaid, pob Pennaeth Ysgol, Pennaeth pob Sefydliad rhyngddisgyblaethol, dau gynrychiolydd pellach o bob Ysgol academaidd, pum cynrychiolydd myfyrwyr a benodir gan Undeb y Myfyrwyr, hyd at bum aelod cyfetholedig a hyd at ddeng aelod academaidd annibynnol.
Mae’r is-bwyllgorau canlynol yn adrodd i’r Senedd: Panel Apeliadau’r Senedd, Byrddau Arholi, y Pwyllgor Gwobrau a Dyfarniadau, y Pwyllgor Rheoliadau ac Achosion Arbennig, y Pwyllgor Llywodraethu Ymchwil a Moeseg, Pwyllgor Enwebiadau’r Senedd a’r Bwrdd Disgyblu.
Y Llys
Corff mawr, ffurfiol yn bennaf yw’r Llys sydd ychydig yn debyg i gyfarfod rhanddeiliaid. Mae’n gyfrwng i gysylltu’r sefydliad â’r buddiannau ehangach y mae’r Brifysgol yn eu gwasanaethu, ac mae’n fforwm cyhoeddus lle gall aelodau’r Llys godi unrhyw faterion yn ymwneud â’r Brifysgol.
Fel rheol mae’r Llys yn cyfarfod unwaith y flwyddyn i dderbyn adroddiad blynyddol a chyfrifon y Brifysgol. Daw mwyafrif aelodau’r Llys o’r tu allan i’r Brifysgol, gan gynrychioli cymunedau Gogledd Cymru a chyrff penodol eraill sydd â diddordeb yng ngwaith y Brifysgol. Mae’r aelodaeth hefyd yn cynnwys cynrychiolwyr o staff academaidd ac o Wasanaethau Proffesiynol y Brifysgol a’r corff myfyrwyr. Adolygwyd aelodaeth y Llys yn ystod 2021/22 ac mae wedi’i nodi yn Ordinhad 13.
Y Bwrdd Gweithredol
Y Bwrdd Gweithredol yw uwch grŵp rheoli’r Brifysgol, ac mae’n gyfrifol am reolaeth a gweinyddiad cyffredinol y Brifysgol. Cadeirir y Bwrdd Gweithredol gan yr Is-ganghellor. Gellir gweld aelodaeth y Bwrdd Gweithredol yma: https://www.bangor.ac.uk/cy/amdanom-ni/bwrdd-gweithredu.
Mae Prifysgol Bangor mewn sefyllfa gref fel Prifysgol ddwyieithog Gogledd Cymru ac ar gyfer Gogledd Cymru, sy’n entrepreneuraidd ac yn cael ei harwain gan ymchwil. Wrth ddatblygu Strategaeth 2030: byd cynaliadwy i genedlaethau’r dyfodol, ein nod yw ysbrydoli’r gymuned academaidd, timau’r Gwasanaethau Proffesiynol, a’r myfyrwyr i greu byd mwy cynaliadwy sy’n cyd-daro â’r weledigaeth sydd gennym i sbarduno llwyddiant trwy ymchwil ac addysgu trawsnewidiol ac arloesol ac sydd wedi eu sbarduno gan effaith.
Mae gan y Brifysgol ran i’w chwarae mewn cymdeithas, gan feithrin y ffocws sydd gennym ar ddarganfod, cynaliadwyedd, diogelu’r amgylchedd, a hyrwyddo ffyniant yr economi, cymdeithas, dwyieithrwydd a diwylliant.
Fel Prifysgol a arweinir gan ymchwil ac fel unigolion sy’n poeni’n fawr am y byd yr ydym yn byw ynddo, rydym am gyfrannu at ddatrys heriau’r byd, megis y newid yn yr hinsawdd, anghydraddoldebau iechyd, a datblygu’r gweithlu.
I weld manylion llawn Strategaeth 2030 ewch i’r wefan: https://www.bangor.ac.uk/cy/strategaeth-2030
Cipolwg ar Strategaeth 2030:
Prifysgol Gogledd Cymru ac ar gyfer Gogledd Cymru, sy’n cael ei harwain gan ymchwil ac yn meithrin effaith gadarnhaol ar gymdeithas yn rhanbarthol, yn genedlaethol ac yn rhyngwladol.
Prifysgol ac iddi gysylltiadau byd-eang, sy’n gwireddu cyfleoedd ar gyfer llwyddiant trwy ymchwil ac addysgu trawsnewidiol ac arloesol a sbardunir gan effaith, gyda ffocws ar gynaliadwyedd
- diogelu’r amgylchedd, adfywio iechyd cymdeithas, a hyrwyddo ffyniant economaidd, cymdeithasol, dwyieithog, a diwylliannol.
• Uchelgais
• Cynwysoldeb
• Uniondeb
• Parch
• Cynaliadwyedd
• Trawsnewid
Rhagoriaeth Ymchwil Profiadau dysgu trawsnewidiol Profiad Rhagorol i fyfyrwyr Amgylchedd dwyieithog lle ma e’r gymraeg yn ffynnu
• Gwella enw da byd-eang
• Cyflymu ymchwil rhyngddisgyblaethol
• Effaith gymdeithasol drawsnewidiol
• Datblygu sgiliau
• Cydweithio a phartneriaethau
• Cwricwlwm sy’n seiliedig ar ymchwil ac ymarfer
• Symudedd a dysgu hyblyg
• Gwell gallu digidol
• Amgylchedd dysgu sy’n arwain y sector
• Cyfoethogi canlyniadau myfyrwyr
• Gwireddu potensial myfyrwyr: Graddedigion
Bangor
Effaith economaidd, cymdeithasol a dinesig Cyrhaeddiad byd-eang
• Gwella ffyniant cymdeithasol ac economaidd
• Cefnogi sgiliau a busnesau rhanbarthol
• Meithrin cymunedau cydlynol, gwydn
• Prifysgol hygyrch yn ein cymunedau lleol
• Cwricwlwm yn adlewyrchu materion a safbwyntiau rhyngwladol
• Cynnydd yn y boblogaeth myfyrwyr rhyngwladol
• Cydweithio a phartneriaethau rhyngwladol
• Denu talent fyd-eang
• Amgylchedd campws ysbrydoledig ac o ansawdd uchel
• Dathlu amrywiaeth
• Myfyrwyr fel partneriaid
• Hyrwyddo gweithle dwyieithog
• Cyfraniad parhaus i fywyd Cymru
• Trawsnewid cymdeithasol, economaidd a diwylliannol
• Cryfhau’r berthynas
â chymunedau ledled Gogledd Cymru
Iechyd a lles
• Amgylchedd gwaith a dysgu iach i staff a myfyrwyr
• Datblygu ysgol feddygol a gwyddorau iechyd ar gyfer Gogledd Cymru
• Ymchwil ac ymarfer ym maes atal ac ymyrraeth gynnar
• Gweithgarwch corfforol a chwaraeon i gefnogi gwell lles
Pobl a thalent
• Yr amgylchedd a chyfleusterau i gefnogi ein pobl
• Safonau proffesiynol
• Amrywiaeth a chynhwysiant
• Cefnogi twf arweinyddiaeth effeithiol
• Gwobrwyo dawn
Gwasanaethau, adnoddau a seilwaith galluogi cynaliadwy
Gwytnwch ariannol Marchnata ar sail tystiolaeth ac adeiladu brand
Gwasanaethau Proffesiynol Modern
Digidol yn gyntaf
Roedd yn anrhydedd cael fy rhoi yng ngofal y gwaith o arwain y cam nesaf yn nhwf a datblygiad y brifysgol arbennig hon. Rwy’n teimlo’n gyffrous am y dyfodol wrth i ni barhau i fwrw ymlaen â Strategaeth 2030 – ein glasbrint ar gyfer gweithio tuag at fyd cynaliadwy i genedlaethau’r dyfodol. Wrth siarad â’n rhanddeiliaid – gan gynnwys staff, myfyrwyr, cyn-fyfyrwyr a phartneriaid a dylanwadwyr allanol – er mwyn dysgu am fusnes y Brifysgol yn ystod ail flwyddyn y pandemig Covid-19, rwyf wedi gallu adfyfyrio ar lwyddiannau niferus ein Prifysgol yn 202122 a phenderfynu hefyd ar ffyrdd y gallwn adeiladu ar y gwaith rhagorol a wnaed ar draws y sefydliad.
Y weledigaeth sydd gen i ar gyfer Prifysgol Bangor yw bod yn brifysgol dan arweiniad ymchwil, sy’n canolbwyntio ar fyfyrwyr ac yn darparu profiad eithriadol iddynt, sydd ag enw rhagorol yn rhyngwladol, tra, ar yr un pryd, ei bod wedi ei gwreiddio yn y gymuned leol, ac yn niwylliant Cymru a’r iaith Gymraeg.
Ein prif rôl yw addysg ac mae’n bwysig bod ein myfyrwyr yn cael eu haddysgu gan staff addysgu ysbrydoledig ac ymchwilwyr blaenllaw. Mae hefyd yn bwysig bod gan ein myfyrwyr sgiliau trosglwyddadwy fel y gallant ragori ar ôl iddynt adael y Brifysgol. Mae creu amgylchedd cadarnhaol i’n myfyrwyr, sy’n gwella bywydau, yn hanfodol i’r profiad myfyrwyr ac rydym yn dechrau gweld ein campysau’n ffynnu unwaith yn rhagor yn y byd ôl-bandemig.
Roedd canlyniadau’r Fframwaith Rhagoriaeth Ymchwil diweddar yn eithriadol o dda i Brifysgol Bangor. Ystyrir bod 85% o’n hymchwil gyda’r gorau yn y byd neu’n rhagorol yn rhyngwladol. Mae’r Brifysgol yn y 30 uchaf yn y Deyrnas Unedig am effaith ei hymchwil ar gymdeithas, ac, am y tro cyntaf mewn cenhedlaeth, mae Bangor wedi ei gosod yn ail yn gyffredinol yng Nghymru.

Mae’r canlyniadau trawiadol hyn yn gosod Bangor ar flaen y gad o ran datblygu ymatebion o bwys i heriau’r byd sydd ohoni, o ran cynaliadwyedd, cynhyrchu ynni carbon isel, iechyd ataliol, hyrwyddo technoleg ac arloesedd, a diwylliant a’r celfyddydau. Bydd canlyniadau’r Fframwaith Rhagoriaeth Ymchwil yn cael effaith gadarnhaol ar ein henw da mewn amrywiol dablau cynghrair a fydd yn eu tro yn effeithio ar ganfyddiadau myfyrwyr ac ar recriwtio. Yn fwy na hynny, mae ein safle yng Nghymru yn dangos yn glir ein hymrwymiad i gefnogi ymchwil cydweithredol, arbenigedd mewn diwydiant, llywodraeth a chysylltiadau dinesig, sy’n rhoi budd i’r economi a chymdeithas yng Ngogledd Cymru a thu hwnt.
Menter bwysig sydd yn yr arfaeth i’r Brifysgol yw sefydlu Ysgol Feddygol Gogledd Cymru, gyda chefnogaeth Llywodraeth Cymru ac mewn partneriaeth â Bwrdd Iechyd Prifysgol Betsi Cadwaladr. Fel rhanbarth a Phrifysgol ddwyieithog, mae’n hanfodol i’n cymunedau ein bod yn sicrhau cynnydd parhaus yn y gweithlu sy’n siarad Cymraeg. Mae’r Brifysgol a’n partneriaid mewn sefyllfa unigryw i ymateb i’r her honno. Bydd yr ysgol feddygol newydd yn cyflwyno gweledigaeth ffres a newydd ar gyfer gweithio yn y proffesiynau meddygol, iechyd a gofal, gan gynnig llwybrau i’r proffesiynau hyn i bobl o bob cymuned ledled Gogledd Cymru. Bydd yn cynyddu capasiti lleoliadau ar draws ein cymunedau, a thrwy hynny’n adeiladu gwytnwch a chreu ecosystem iechyd gref.
Ceir perthynas gyd-ddibynnol rhwng y byd academaidd, cleifion, y GIG, cyllidwyr ymchwil feddygol a chwmnïau gwyddorau bywyd. Er bod y rhwydwaith hwn o wahanol ddiddordebau yn gymhleth ac yn eang, mae gofal cleifion yn greiddiol iddo. Mae’r sector gwyddorau bywyd yn cyfrannu £70 biliwn i economi’r Deyrnas Unedig yn flynyddol. Mae hyn yn cyfateb i £2.7 biliwn yng Nghymru, a gallai hyn olygu £760 i Ogledd Cymru ar sail y pen.
Byddwn yn manteisio ar y sylfaen asedau gref yn y sector ac ym meysydd Gwyddoniaeth, Technoleg, Peirianneg a Mathemateg er mwyn cryfhau’r economi ranbarthol. Bydd hyn yn cynyddu gallu ymchwil, effaith ac yn trosi hynny i roi gwell canlyniadau i gymdeithas.
Mae’r Brifysgol wedi parhau i weithio’n agos gyda’i phartneriaid yng Ngogledd Cymru ac mae ein
Canolfan Ragoriaeth Prosesu Signalau Digidol yn ganolfan ymchwil gwerth miliynau o bunnoedd sy’n gwneud ymchwil tra arbenigol i systemau cyfathrebu digidol megis rhwydweithiau ac ecosystemau 5G.
Y Ganolfan Prosesu Signalau Digidol yw’r unig safle ymchwil yn y Deyrnas Unedig sy’n ymroddedig i fynd
i’r afael â thechnoleg prosesu signalau digidol ar gyfer cymwysiadau’r dyfodol ac mae’n gweithio ochr yn ochr
â mwy na 30 o bartneriaid mewn diwydiant i ddarparu atebion sy’n torri tir newydd ar gyfer amrywiol sectorau. Yn haf 2022, y Ganolfan Prosesu Signalau Digidol oedd project cyntaf Bargen Twf y Gogledd, sef rhaglen gwerth £240m sydd wedi’i neilltuo i ddarparu buddsoddiad yn y rhanbarth gyda’r nod penodol o ysgogi twf economaidd.
Gydag agenda hyderus ac eangfrydig, mae Prifysgol Bangor yn sefydliad angori yng Nghymru ac, o’r herwydd, rydym yn rhan allweddol o’r gymuned yr ydym yn gweithredu ynddi. Er mwyn archwilio tirwedd economaidd-gymdeithasol Gogledd Cymru a helpu i lywio trafodaethau am ei ddyfodol, sefydlwyd partneriaeth tair blynedd gyda’r Sefydliad Materion Cymreig i ddylanwadu ar yr agenda polisi cyhoeddus ar draws ystod o faterion gan gynnwys canfyddiadau a gwirioneddau Gogledd Cymru; cysylltiadau cymdeithasol, economaidd a gwleidyddol y rhanbarth â gweddill y wlad; a buddsoddi, arloesi ac agenda Codi’r Gwastad.
Yn ystod 2021-22, lles, diogelwch a gwytnwch cymuned Bangor - yn cynnwys myfyrwyr, staff ac ymwelwyr - oedd y brif flaenoriaeth wrth gwrs a dilynodd y Brifysgol arweiniad Llywodraeth Cymru air am air er mwyn sicrhau ei bod yn parhau i ffynnu yn ystod y pandemig. Dywedodd ein myfyrwyr wrthym, er gwaethaf y pandemig, iddynt barhau i ffynnu a gosodwyd y Brifysgol yn safle 19 trwy’r Deyrnas Unedig yn yr Arolwg Cenedlaethol Myfyrwyr blynyddol, gan adlewyrchu ein hymrwymiad i addysgu ysbrydoledig.
Gan fod cyfleoedd cyflogadwyedd i fyfyrwyr yn rhan bwysig o strategaeth y Brifysgol, mae ein parc gwyddoniaeth, M-SParc, wedi cefnogi mentrau entrepreneuriaeth i fyfyrwyr yn ogystal â llawer o bartneriaethau â diwydiant ac mae ein Hysgolion academaidd yn parhau i weithio’n agos gyda chyflogwyr ledled Cymru a thu hwnt.
Mae cynaliadwyedd yn greiddiol i’r sefydliad, boed hynny’n diogelu’r amgylchedd, adfywio iechyd cymdeithas neu hyrwyddo ffyniant economaidd, cymdeithasol, dwyieithog a diwylliannol. Mae’n hymrwymiadau yn cefnogi dyheadau a nodir yn
Neddf Llesiant Cenedlaethau’r Dyfodol (Cymru) ac 17
Nod Datblygiad Cynaliadwy’r Cenhedloedd Unedig. Rydym yn falch o fod ar y brig yng Nghymru, yn 11eg
trwy’r Deyrnas Unedig ac yn safle 53 trwy’r byd yng nghynghrair effaith y Times Higher Education am ein gwaith gyda’r Nodau Datblygu Cynaliadwy.
Mae gwreiddiau Prifysgol Bangor yn ddwfn yn y gymuned hon ac rydym yn ymhyfrydu yn ein treftadaeth unigryw fel canolfan ddysg a sefydlwyd yn 1884 trwy ymrwymiad a rhoddion chwarelwyr y rhanbarth a oedd am roi gwybodaeth yn rhodd i genedlaethau’r dyfodol. Heddiw, mae ein hymwneud yn fawr â maes hyrwyddo’r Gymraeg a’i diwylliant ac rydym wedi bod ar flaen y gad wrth ddatblygu addysg ddwyieithog yng Nghymru ers blynyddoedd lawer. Mae gan lawer o’n rhaglenni gradd opsiwn Cymraeg i alluogi myfyrwyr i astudio trwy gyfrwng y Gymraeg.
Dyma ran yn unig o’r hyn sy’n ein gwneud yn gampws amlieithog gyda dros 2,000 o fyfyrwyr rhyngwladol yn cynrychioli dros 70 o wledydd. Mae strategaeth recriwtio a symudedd ryngwladol newydd a gyflwynwyd yn 2022 yn cryfhau ymgysylltiad Bangor yn fyd-eang, gan ganolbwyntio ar recriwtio myfyrwyr, datblygu partneriaethau a symudedd myfyrwyr. Mae ein strategaeth yn cyd-fynd â strategaethau addysg uwch rhyngwladol llywodraeth Cymru a’r Deyrnas Unedig, yn enwedig o ran ymgysylltu a hyrwyddo’r cynlluniau symudedd rhyngwladol – y cynllun ‘Taith’ a’r cynllun ‘Turing’ – a fydd yn rhoi cyfleoedd newydd i’n myfyrwyr presennol a’n darpar fyfyrwyr.
Wedi’r pandemig, mae Prifysgol Bangor yn parhau i ffynnu ac arloesi. Bydd ein ffocws ar ddarparu profiad cyfoethog i fyfyrwyr gan fod yn ddarbodus mewn perthynas â chynaliadwyedd ariannol yn cyfrannu at wireddu uchelgais y sefydliad i’r dyfodol, gan ddarparu’r gallu i gyflawni’r blaenoriaethau a’r nodau a nodir yn Strategaeth 2030.
Yr Is-Ganghellor, Yr Athro Edmund Burke
Mae ymchwil Prifysgol Bangor yn arloesol ac wedi ei sbarduno gan effaith ac mae’n helpu i fynd i’r afael
â rhai o’r heriau pennaf sy’n wynebu cymdeithas, iechyd, economi ac amgylchedd y byd heddiw.
Ein gweledigaeth o ran ymchwil ac effaith yw bod yn ganolfan ragoriaeth fyd-eang mewn cynaliadwyedd, ac mae’r Brifysgol yn ymdrin â chynaliadwyedd mewn modd unigryw a chyfannol sy’n cyd-daro â Nodau
Datblygu Cynaliadwy’r Cenhedloedd Unedig a Deddf Llesiant Cenedlaethau’r Dyfodol (Cymru).
Trwy ein hymchwil, ein cydweithrediadau a’n partneriaethau rydym ar flaen y gad o ran blaenoriaethau
a heriau cymdeithasol newydd ac rydym yn cyfrannu at bolisïau’r Llywodraeth o ran sut i fynd i’r afael â’r pethau hyn. Yn ystod 2021-22 llwyddodd ein hymchwilwyr i ddenu 210 o grantiau ymchwil newydd gwerth £20.5 miliwn a dyfarnwyd 116 o raddau ymchwil.
Ymhlith ein mentrau blaenllaw, bydd y cynlluniau a gefnogir gan Lywodraeth Cymru i sefydlu Ysgol Feddygol Gogledd Cymru ym Mhrifysgol Bangor yn darparu Ysgol ryngbroffesiynol arloesol sy’n adeiladu ar ein cryfderau ymchwil yn y Gwyddorau Dynol ac yn helpu i ddatblygu iechyd a gofal cymdeithasol cynaliadwy at y dyfodol a fydd yn gynaliadwy, yn seiliedig ar le ac yn cefnogi twf y sector gwyddorau bywyd yn rhanbarthol.
Mae ein hymchwil yn defnyddio dull ‘systemau’ cyfannol, gyda ffocws arbennig ar ystod o weithgareddau ynni carbon isel gan gynnwys systemau ynni niwclear a morol a thechnolegau synwyryddion. Mae ein gwaith yn canolbwyntio ar wella parodrwydd technolegau newydd, wedi’u cryfhau trwy bartneriaethau diwydiannol arwyddocaol.
Mae gan Brifysgol Bangor un o’r grwpiau mwyaf o wyddonwyr amgylcheddol yn y Deyrnas Unedig. Mae ein gwaith ym maes Gwyddorau’r Eigion a’r Gwyddorau Naturiol, y mae iddo enw da yn rhyngwladol, yn amrywio o newid amgylcheddol byd-eang i gynhyrchu bwyd mewn modd cynaliadwy.
Mae’r Sefydliad Dyfodol Niwclear, sy’n fawr ei fri, yn cynnwys cyfleusterau eithriadol sy’n cael eu

defnyddio gan ymchwilwyr a rhanddeiliaid y diwydiant i gynorthwyo’r gwaith o ddatblygu technoleg niwclear, tra bod ein Canolfan Ynni Effeithlon Craff yn datblygu peirianneg, cyfrifiadureg a modelu i gynyddu cynaliadwyedd cyflenwad a defnydd ynni wrth leihau effeithiau amgylcheddol negyddol.
Ym maes busnes a chyllid, mae Ysgol Busnes Bangor ar flaen y gad o ran ymchwil a hyfforddiant ym meysydd cyfrifeg, bancio a chyllid yn y Deyrnas Unedig ac mae wedi ei rhestru ymhlith y 50 sefydliad gorau yn y byd am ymchwil Bancio.
Mae gwyddonwyr chwaraeon yn gwneud ymchwil i wytnwch meddwl, perfformiad elît, perfformiad dynol ac iechyd mewn amgylcheddau eithafol, ymddygiad deietegol a metabolaeth, ac ymarfer corff ac iechyd fasgwlar.
A gyda ffocws ymchwil ar y Gymraeg ac Astudiaethau Celtaidd, Ysgrifennu Creadigol a Pherfformio, ac Ieithyddiaeth rydym yn manteisio ar ddiwylliant Cymreig yr ardal y mae Prifysgol Bangor wedi ei lleoli ynddi ac yn gosod hynny mewn cyd-destun rhyngwladol.
Lle gwelir arbenigedd ymchwil y brifysgol yn cydblethu ag arbenigeddau sectorau diwydiant lleol, mae hyn yn creu ‘canolbwynt’ pwerus ar gyfer gweithgarwch arloesi. Yn bwysig ddigon, rhan o ethos Prifysgol Bangor yw cysylltu ein hymchwil ag amgylchedd rhanbarthol Gogledd Cymru fel y gall effaith yr ymchwil hwnnw helpu i sbarduno adfywiad economaidd a chymdeithasol.
Yn ogystal â bod â’r gyfran uchaf o staff dwyieithog Cymraeg/Saesneg yng Nghymru, ac arbenigedd nodedig yn hanes a diwylliant Cymru a’r Gymraeg, mae ein hymchwilwyr yn dod o 30 o wledydd ledled y byd ac yn cydweithio â chydweithwyr mewn dros 120 o wledydd.
Mae ymwneud â’n cymunedau a dangos gwerth ein hymchwil i gymdeithas yn rhan greiddiol o’r hyn ydym. Rydym wedi ymrwymo i gynnal perthynas gadarnhaol a llwyddiannus â rhanddeiliaid a hynny drwy drefn bedwarplyg sef ymchwil prifysgol, arbenigedd diwydiant, llywodraeth a chymdeithas ddinesig.
grantiau ymchwil newydd gwerth £20.5 miliwn
Cydnabu Fframwaith Rhagoriaeth Ymchwil 2021, a gyhoeddwyd ym mis Mai 2022, fod 85% o ymchwil Prifysgol Bangor naill ai gyda’r gorau yn y byd neu’n rhagorol yn rhyngwladol. Gan ddangos cyfraniad ein hymchwil i’r byd go iawn, mae’r Brifysgol yn y 30 uchaf yn y Deyrnas Unedig am effaith ymchwil.

Mae Gwyddorau Chwaraeon ac Ymarfer ym Mangor yn cael ei restru ymhlith y 5 Uchaf yn y Deyrnas Unedig. Gyda sgôr ragorol o ran effaith gymdeithasol yr ymchwil, mae ein gwyddonwyr chwaraeon blaenllaw yn gwneud ymchwil i wytnwch meddwl, perfformiad elît, ymddygiad deietegol a metabolaeth, ac ymarfer corff ac iechyd fasgwlar.
Ym meysydd Systemau Daear a Gwyddorau’r Amgylchedd mae ymchwil Bangor wedi ei restru yn gyntaf yn y Deyrnas Unedig am effaith yr ymchwil. Gydag un o’r grwpiau mwyaf o wyddonwyr amgylcheddol yn y Deyrnas Unedig, mae ein hymchwil wedi’i restru yn chweched yn y Deyrnas Unedig ac yn gyntaf yng Nghymru am bŵer ymchwil.
Mae ein hymchwil ym maes proffesiynau perthynol i iechyd yn 15fed yn gyffredinol yn y Deyrnas Unedig.
Mae’r gwaith hwn yn cefnogi cynlluniau’r Brifysgol i sefydlu Ysgol Feddygol yng Ngogledd Cymru.
Mae’r Brifysgol yn y 30 uchaf yn y

Colled Net:
Er gwaethaf ymrwymiadau byd-eang, mae coedwigoedd trofannol yn parhau i ddiflannu’n gyflym. Yn aml, mae cwmnïau’n rhoi polisïau gwrthbwyso bioamrywiaeth ar waith, fodd bynnag, hyd yn hyn, mae’r rhain wedi bod yn hynod heriol i’w hasesu.
Mae’r gwerthusiadau effaith cyntaf i fod yn gwbl annibynnol, a’r mwyaf cadarn i’w cynnal hyd yma ym maes gwrthbwyso bioamrywiaeth wedi eu cyhoeddi yn Nature Sustainability. Roedd yr astudiaeth, dan arweiniad y fyfyrwraig PhD Katie Devenish gyda’r Athro Julia Jones a’r Athro Simon Willcock o’r Ysgol Gwyddorau Naturiol yn canolbwyntio ar fwynglawdd
Ambatovy, sy’n cyfrannu’n helaeth at economi Madagascar ac yn arwain ym maes mwyngloddio cynaliadwy.
Mae’r gwerthusiad yn awgrymu bod yr ymdrechion gwrthbwyso ar y trywydd iawn i sicrhau ‘Dim Colled
Net’ o’r cynefin coedwigaeth unigryw a ddinistriwyd gan y mwynglawdd. Er gwaethaf y ffaith fod dros 12,000 o fentrau ar draws y byd sy’n gwrthbwyso bioamry wiaeth, ac mae llai na 0.05% ohonynt wedi cael eu gwerthuso. Mae’r gwaith gwerthuso’n golygu cymharu canlyniadau a arsylwyd gyda’r hyn a fyddai wedi digwydd heb yr ymyriad. Mae’n amlwg yn anodd felly amcangyfrif yn achos senario gwrthffeithiol fel yma. Yn y gwerthusiad aethpwyd ati i archwilio dros 100 o wahanol ffyrdd y gynnal ein dadansoddiad ac mae’r canlyniadau’n glir. Mae’r gallu i werthuso’r polisïau yn rhoi cefnogaeth gref i’w gwneud yn ofynnol i fwyngloddiau, a datblygiadau mawr eraill, wneud eu rhan drwy fuddsoddi mewn ymdrechion cadwraeth.
Darllenwch mwy: Llwyddiant polisi dadleuol i gysoni mwyngloddio a chadwraeth bioamrywiaeth | Bangor University
Bydd buddion hinsoddol bio-nwy yn lleihau wrth i dechnolegau glanach ddod i’r fei:
Mae bio-nwy yn cael ei ddefnyddio fel dewis ynni gwyrdd amgen a chaiff ei greu pan fydd deunyddiau organig gwastraff yn cael eu torri i lawr yn anaerobig gan ddal y nwyon sy’n deillio o hynny ar gyfer eu defnyddio. Fodd bynnag, yn hytrach na chanolbwyntio ar ailddefnyddio gwastraff, mae astudiaeth a gyhoeddwyd yn y Journal of Cleaner Production yn dadlau y dylid rhoi blaenoriaeth i atebion hinsoddol mwy effeithiol megis atal gwastraff, cynhyrchu trydan solar a choedwigo, cyn ystyried bio-nwy, er mwyn cyrraedd y targed allyriadau nwyon tŷ gwydr “sero net” heriol a osodwyd ar gyfer 2050.
Nododd Dr Prysor Williams, sy’n Uwch Ddarlithydd mewn Rheolaeth Amgylcheddol ym Mhrifysgol Bangor, “Er mwyn darparu sylfaen dystiolaeth fwy cadarn ar gyfer buddsoddiad cynaliadwy strategol, roeddem am weld sut mae’r dechnoleg ‘werdd’ hon a hyrwyddir yn eang yn cymharu â’r dewisiadau amgen gorau sydd ar gael, heddiw ac yng nghyd-destunau’r dyfodol, lle mae technolegau glân yn debygol o fod yn bennaf ar y llwybr tuag at allyriadau nwyon tŷ gwydr sero net.”
Er bod bio-nwy ar hyn o bryd yn danwydd cludiant llawer glanach na phetrol neu ddiesel, mae ymdrechion cyflym i drydaneiddio cludiant a datblygu tanwydd
hydrogen gwyrdd yn cynnig mwy o arbedion mewn allyriadau a gallai fod o fwy o fudd i’r hinsawdd na defnyddio bio-nwy fel tanwydd cludiant dros y degawdau nesaf. Yn y cyfamser, efallai mai hylosgi bio-nwy ar raddfa fawr i gynhyrchu trydan neu wres diwydiannol fyddai’r defnydd gorau y gellid ei wneud o fio-nwy i liniaru nwyon tŷ gwydr yn y dyfodol os defnyddir dull o ddal a storio carbon bio-ynni.

Mae’r modelu’n awgrymu, hyd yn oed os bydd technolegau mwy effeithlon i’w cael yn y dyfodol, y bydd lle cynaliadwy o hyd i gyfleusterau treulio anaerobig sy’n creu bio-nwy o wastraff bwyd a thail anifeiliaid, sy’n gynhyrchion anochel.
Darllenwch mwy: Mae atal yn well na gwella: mae trosi gwastraff organig i fio-nwy yn dda i’r hinsawdd, ond mae atal gwastraff yn llawer gwell | Bangor University
Rhywogaethau coed mynydd yn Jamaica yn cael eu gwthio i fyny tuag at ddifodiant:

Mae dwy effaith newid hinsawdd byd-eang yn cyfuno i fygwth ardal sy’n gyfoethog o ran bioamrywiaeth fydeang yn ôl tystiolaeth a gyhoeddwyd yn Ecography.
Mae cynhesu byd-eang yn cynyddu dwyster corwyntoedd cryfaf yr Iwerydd ac, ar yr un pryd, mae’n araf symud yr ystod o rywogaethau planhigion ac anifeiliaid i barthau a oedd gynt yn oerach - tuag at begwn y gogledd a phegwn y de ac i fyny llethrau’r mynyddoedd i uchderau uwch.
Mae ymchwil hirdymor ym Mynyddoedd Gleision Jamaica gan dîm o ymchwilwyr o’r Ysgol Gwyddorau Naturiol yn dangos bod y mudo hwn wedi’i gyflymu gan effaith ddifrifol Corwynt Gilbert ym 1988.
Eglura John Healey, sy’n Athro Gwyddorau Coedwig, “Mae Mynyddoedd Gleision Jamaica yn codi i uchder o 2256m felly, ar hyn o bryd, mae tir coediog yn dal i fod yn uwch i fyny’r llethrau i’r rhywogaethau mynyddig prin fudo iddo. Fodd bynnag, gyda’r broses hon yn parhau wrth i’r atmosffer gynhesu fwy fyth, unwaith y byddant wedi’u cyfyngu i gribau’r mynyddoedd uchaf ni fydd unman arall i’r rhywogaethau hyn fynd. Bydd effaith corwyntoedd cynyddol ddifrifol, megis Corwynt
Gilbert, yn peri i’r bygythiad hwnnw o ddifodiant ddigwydd hyn yn oed ynghynt.”
Achosodd Corwynt Gilbert ddifrod sylweddol i goedwigoedd y Mynyddoedd Gleision, gan dorri canghennau a boncyffion llawer o’r coed mwyaf. Fe wnaeth y rhan fwyaf ailflaguro a goroesi, ond roedd y gyfradd marwolaethau yn arbennig o uchel ar gyfer y rhywogaethau sydd wedi’u cyfyngu i’r coedwigoedd uchder uchaf. Roedd y bylchau yng nghanopi’r goedwig a grëwyd gan farwolaeth y coed hyn yn rhoi’r cyfle i goed newydd adfywio, ond tueddai’r rhain i fod yn rywogaethau o fannau is i lawr llethrau’r mynyddoedd. Y canlyniad yn y pen draw yw bod y goedwig yn cael ei dominyddu fwyfwy gan rywogaethau o’r tir is, gan gyflymu’r broses a oedd eisoes wedi dechrau’n araf oherwydd cynhesu byd-eang.
Darllenwch mwy:
Cynhesu byd-eang a chorwynt cryf yn cyfuno i yrru rhywogaethau coed i fyny mynyddoedd trofannol ar y ffordd i ddifodiant | Bangor University
Tri pheth sy’n cysylltu llygredd plastig a newid hinsawdd:
Oeddech chi’n gwybod bod llygredd plastig a newid hinsawdd yn gysylltiedig â’i gilydd? Dangosodd yr ymchwilydd o Fangor, Helen Ford a’r Gymdeithas Swolegol yn Llundain, mewn cyhoeddiad yn Science of the Total Environment, am y tro cyntaf bod llygredd plastig yn y môr a newid yn yr hinsawdd, sy’n faterion byd-eang, yn gwaethygu ei gilydd, gan greu cylch peryglus.
Mae’r argyfwng hinsawdd a llygredd plastig – sef un o’r prif bethau sy’n ysgogi colli bioamrywiaeth môr –wedi’u cysylltu mewn tair ffordd arwyddocaol: Mae plastig yn cyfrannu at lefelau byd-eang nwyon tŷ gwydr trwy gydol ei gylch bywyd, o’r gynhyrchu’n wreiddiol hyd at ei waredu; bydd tywydd eithafol, megis llifogydd a theiffwnau, sy’n gysylltiedig â newid yn yr hinsawdd yn gwasgaru ac yn gwaethygu llygredd plastig; ac mae rhywogaethau ac ecosystemau’r môr yn arbennig o agored i’r ddau beth.
Dangosodd yr astudiaeth bod newidiadau o ganlyniad i lygredd plastig a newid yn yr hinsawdd eisoes yn effeithio ar organebau’r môr ar draws ecosystemau morol a gweoedd bwyd, o’r plancton lleiaf i’r morfilod mwyaf. Mae angen i ni ddeall sut y bydd y bygythiadau hyn i fywyd y môr yn rhyngweithio â’i gilydd wrth iddynt waethygu ac mae angen i ni annog llunwyr polisi i weithredu i fynd i’r afael â’r bygythiadau bydeang hyn. Mae ymwybyddiaeth y cyhoedd a sylw’r cyfryngau i’r ddwy broblem wedi cynyddu’r aruthrol dros y blynyddoedd, ond mae astudiaethau’n dangos mai ymdrin â nhw fel materion ar wahân a wneir yn aml, gan gystadlu â’i gilydd am adnoddau hyd yn oed.

Darllenwch mwy:
Canlyniadau trychinebus i’n cefnforoedd wrth i argyfyngau newid yn yr hinsawdd a llygredd plastig gyfuno â’i gilydd | Bangor University
Seicolegwyr yn datgelu sut rydym ni’n gweld ein hunain mewn gwirionedd trwy gynhyrchu ‘hunluniau meddyliol’:
Ni fu erioed amser pan fu gennym ni gymaint o obsesiwn ag ymddangosiad na’n hoes ‘hunlunol’ ni heddiw. Dadl llawer yw y gall yr obsesiwn â hunluniau ac addasu delweddau droi rhai ohonom ni yn narsiswyr, tra gall eraill hefyd deimlo’n fwy anfodlon gyda delwedd eu corff. Ond sut ydyn ni’n gweld ein hunain yn ein meddyliau mewn gwirionedd?

Datblygodd seicolegwyr ym Mangor ddull o ddelweddu ‘hunanbortreadau’ meddyliol ac yna datblygu, mewn ail gam, ‘ddelweddau o’r corff’. Fe wnaethant archwilio i ba raddau y gall y delweddau mewnol hyn wyro oddi wrth yr hyn y mae eraill yn ei weld a dangos sut y gallant gael eu heffeithio gan ein credoau am ein personoliaethau a’n hunan-barch.
Eglura Dr Lara Maister, “Fe wnaethom ofyn i’r cyfranogwyr gynhyrchu ‘hunanbortread meddyliol’ yn defnyddio rhaglen gyfrifiadurol, a gofyn hefyd iddyn nhw ateb holiaduron personoliaeth a hunanbarch i ddatgelu pa fath o berson ydynt yn eu barn eu hunain. Gwelsom fod eu barn amdanynt eu hunain yn effeithio’n fawr ar y modd yr oeddent yn darlunio eu hymddangosiad eu hunain. Er enghraifft, os oedd rhywun yn credu ei fod yn allblyg, roeddent yn gweld
eu hwynebau eu hunain yn edrych yn fwy hyderus a chymdeithasol nag yr oeddent yn ymddangos i bobl eraill.”
Canfu’r ymchwilwyr fod ein credoau’n effeithio’n gryf ar y modd yr ydym yn darlunio ein hymddangosiad ein hunain, e.e., os yw person yn credu ei fod yn allblyg, mae’n darlunio ei wyneb ei hun fel un sy’n edrych yn fwy hyderus a chymdeithasol nag y mae’n ymddangos i bobl eraill. Wrth asesu canfyddiadau am siâp y corff, nid yn unig fod gan bobl ddelweddau meddyliol afrealistig o’u cyrff eu hunain, ond roedd y delweddau meddyliol hyn yn cael eu dylanwadu’n gryf gan eu hagweddau tuag atynt eu hunain yn hytrach na chael eu dylanwadu gan eu hymddangosiad gwirioneddol.
Gallai’r hyn y seiliwyd yr ymchwil hwn arno ddarparu teclyn newydd i glinigwyr sy’n cefnogi pobl ag anhwylderau delwedd y corff i fesur a fu therapïau’n llwyddiannus.
Darllenwch mwy: Seicolegwyr yn datgelu sut rydym ni’n gweld ein hunain mewn gwirionedd trwy gynhyrchu ‘hunluniau meddyliol’ | Bangor University
Gwella’r modd y mae sepsis yn cael ei adnabod a’i drin yn yr ysbyty:
Gall adnabod a thrin sepsis yn gynnar, adwaith i haint sy’n peryglu bywyd, arbed bywydau. Aeth Dr Eirian Edwards a Dr Lorelei Jones o’r Ysgol Gwyddorau
Meddygol ac Iechyd ati i ymchwilio i’r modd y mae sepsis yn cael ei adnabod a’i drin mewn cleifion ar wardiau meddygol cyffredinol a wardiau llawfeddygol ac asesu pa effaith a gaiff hyfforddiant ar hynny.
Canfu’r astudiaeth fod nyrsys a oedd wedi derbyn hyfforddiant sepsis yn llawer iawn mwy tebygol o fod ag agwedd gadarnhaol at sgrinio a rheoli sepsis, ac yn fwy hyderus wrth sgrinio am sepsis ac yn fwy tebygol o fod wedi sgrinio claf am sepsis.
Y rhwystr yr adroddwyd amdano amlaf sy’n rhwystro nyrsys rhag adnabod a thrin sepsis mewn modd amserol ar y wardiau oedd llwyth gwaith a staffio annigonol. Mynegodd rhai nyrsys bryder ynghylch
staff dibrofiad neu anghyfarwydd ar y wardiau, megis cynorthwywyr gofal iechyd a staff asiantaeth, pan na chafodd arsylwadau annormal eu cyfeirio ymlaen yn briodol.
Adroddwyd bod hyfforddiant sepsis, offer sepsis (megis meini prawf sgrinio, bwndel sepsis a chyfarwyddeb grŵp cleifion) a chefnogaeth i gydweithwyr i gyd yn helpu i adnabod a thrin sepsis mewn modd amserol. Mae’r awduron yn argymell rhoi hyfforddiant sepsis i bob nyrs ac yn codi cwestiwn ynglŷn â mynediad at hyfforddiant sepsis i staff asiantaethol hefyd.
Darllenwch mwy: Gwella’r modd mae sepsis yn cael ei adnabod a’i drin yn yr ysbyty | Bangor University
Babanod newydd-anedig yn datblygu sgiliau iaith o fewn oriau:
Mae’n hysbys bod babanod yn dechrau dysgu iaith trwy glywed lleferydd hyd yn oed pan fyddant yn y groth, ond ni allant glywed y manylion gan ei fod yn ddryslyd, fel pe bai o dan y dŵr.
Gan weithio gyda babanod newyddanedig - gan ddechrau o fewn ychydig funudau i’r enedigaeth - defnyddiodd ymchwilwyr ym Mangor ddelweddu optegol i fesur newidiadau corff. Chwaraewyd recordiadau o lafariaid yn cael eu dweud, ac yna eu profi i weld a oedd eu hymennydd yn ymateb yn wahanol pan glywsant yr un llafariaid yn cael eu chwarae yn ôl o gymharu â pan chwaraewyd hwy ymlaen.
Ar ôl dim ond pum awr o ddod i gysylltiad â’r cyferbyniad hwn, dangosodd delweddu optegol fod ymennydd y babanod newyddanedig wedi dechrau gwahaniaethu
rhwng y ddwy sain. Ac ar ôl dwy awr arall, pan oedd y babanod newyddanedig yn cysgu’n bennaf, fe wnaeth yr amlygiad i’r cyferbyniad llafariad ysgogi sbardun o gysylltedd, gyda niwronau’n siarad
â’i gilydd ar raddfa fawr, fel pe baent wedi cael eu hysbrydoli gan y synau
iaith a glywsant.
Dywedodd Guillaume Thierry, sy’n Athro Niwrowyddoniaeth
Wybyddol, “Dangosodd ein
hymchwil fod gwahaniaeth cynnil
iawn - hyd yn oed i glust oedolyn -
yn ddigon i sbarduno ymchwydd
gweithgaredd ymennydd sylweddol yn ymennydd y newydd-anedig, gan ddangos bod profiadau cynnar
yn gallu arwain at ganlyniadau mawr o ran datblygiad gwybyddol.”
Ychwanegodd Dr Gary Oppenheim, sy’n Ddarlithydd mewn Seicoleg, “Nid yw’r gwaith y mae clustiau
a system glywedol baban newydd-anedig yn ei wneud mor amlwg i’r llygad noeth, ond mae’r canlyniadau’n dangos bod gennym sensitifrwydd rhyfeddol i wybodaeth iaith o’r union funud y cawn ein geni ac rydym yn mynd ati’n syth i weithio i’w datblygu a’i mireinio mewn ymateb i’n profiadau yn y byd, hyd yn oed pan ymddengys mai dim ond cysgu yr ydym.”
Dangosodd yr ymchwil fod gwahaniaeth cynnil iawn yn ddigon i sbarduno ymchwydd gweithgaredd sylweddol yn ymennydd babanod newydd-anedig, gan ddangos y gall profiadau cynnar gael canlyniadau sylweddol o ran datblygiad gwybyddol.

Darllenwch mwy: Babanod newydd-anedig yn datblygu sgiliau iaith o fewn oriau | Bangor University
Mae cwmnïau sydd â mwy o amrywiaeth rhywedd yn y gwaith yn lleihau CO2:
Y berthynas rhwng amrywiaeth rhywedd yn y gwaith ac allyriadau carbon cwmni oedd y sylfaen ar gyfer ymchwil a wnaed gan
Brifysgol Bangor, The Bank for International Settlements a Banc Canolog Ewrop yn
edrych i weld a oedd bod â merched mewn swyddi rheoli yn gwella perfformiad amgylcheddol cwmni.
Roedd cwmnïau â mwy o amrywiaeth
rhwng y rhywiau yn y gweithle yn llwyddo i ostwng CO2 5% yn fwy na chwmnïau sy’n cyflogi dynion yn bennaf, gan ddangos y gall
amrywiaeth rhwng y rhywiau mewn sefydliad
gael effaith sylweddol wrth frwydro yn erbyn newid yn yr hinsawdd.
Dadansoddwyd y berthynas rhwng canran y merched a benodwyd yn rheolwyr ac allyriadau carbon cwmnïau mewn sampl o 1,951 o gwmnïau rhestredig mewn 24 economi diwydiannol rhwng 2009 a 2019, ac mae cynnydd o 1 pwynt canran mewn rheolwyr sy’n ferched yn arwain at ostyngiad o 0.5% mewn allyriadau CO2.
Mae’r canlyniadau rhwng canran y rheolwyr sy’n ferched ac allyriadau CO2 yn cael eu cefnogi gan fframwaith damcaniaethol cadarn sy’n seiliedig ar nodweddion personoliaeth cadarnhaol merched o ran materion amgylcheddol sy’n dylanwadu ar eu penderfyniadau mewn perthynas â’r amgylchedd wrth roi strategaeth y bwrdd gweithredol ar waith.
Dywedodd Yener Altunbas, sy’n Athro mewn Bancio, “Roedd yn galonogol gweld bod polisïau cwmnïau oedd yn mynnu presenoldeb merched ar lefel reoli nid yn unig yn cael yr effaith gywir ar anghydbwysedd o ran amrywiaeth rhywedd ond hefyd o bosib yn cyfrannu at yr amcanion amgylcheddol.
Mae annog cwmnïau i benodi mwy o reolwyr sy’n ferched a chynnwys gwerthoedd gwyrdd mewn meini prawf recriwtio proffil yn gam i’r cyfeiriad cywir.”
Darllenwch mwy:
Mae cwmnïau sydd â mwy o amrywiaeth rhywedd yn y gwaith yn lleihau CO2 | Bangor University
Adroddiad ‘Towards Justice’ yn galw am ddull cydgysylltiedig o gefnogi dioddefwyr niwed yn y gorffennol:
Mae adroddiad gan Martina Feilzer, sy’n Athro Troseddeg a Chyfiawnder Troseddol yn galw ar yr heddlu, gwleidyddion, a llunwyr polisi i fabwysiadu dull mwy cydgysylltiedig o ymateb i niwed yn y gorffennol ac yn galw am roi anghenion dioddefwyr, goroeswyr a’u teuluoedd wrth wraidd yr ymdrechion hynny.
Mae’r adroddiad yn cydnabod cymhlethdod y sefyllfa y mae dioddefwyr yn ei hwynebu wrth ymgysylltu a nifer o wahanol asiantaethau ac yn cynghori y dylid ystyried gwersi o’r system Eiriolwyr Cyhoeddus a ddefnyddir yn nhaleithiau UDA.
Mae Towards Justice yn cynnig mewnwelediad unigryw traws-sector trwy dynnu ar brofiad ac arbenigedd cyfun swyddogion heddlu, academyddion, cyrff anllywodraethol, llunwyr polisi, ac ymarferwyr yn ogystal â thystiolaeth gan ddioddefwyr, goroeswyr a theuluoedd o niwed a chamdriniaeth sydd wedi digwydd ers tro, gan amrywio o gam-drin plant yn rhywiol o fewn sefydliadau i drychineb Hillsborough a’r sgandal cynhyrchion gwaed wedi eu halogi.

Mae galwadau cynyddol am osod dyletswydd gonestrwydd ar swyddogion heddlu, yn ogystal â chyrff cyhoeddus eraill, yn cael eu hadleisio yn yr adroddiad, sy’n nodi y gall diffyg tryloywder arwain at
ddrwgdybiaeth ac amheuaeth o guddio pethau. Mae’n argymell adolygiad o’r mathau presennol o rwymedi sydd ar gael i ddioddefwyr, goroeswyr niwed a’u teuluoedd, i fynd i’r afael â thensiynau sy’n dod i’r amlwg dros amser a sicrhau eu bod yn diwallu anghenion y rhai yr effeithir arnynt fwyaf.
Mae’n annog archwilio systemau rhwymedi amgen megis cyfiawnder adferol, sydd wedi ennill momentwm mewn meysydd eraill o’r system cyfiawnder troseddol. Mae hefyd yn annog y partïon perthnasol i gydnabod bod niwed sydd wedi digwydd ers tro yn parhau i atseinio yn y presennol a bod angen cymhwyso’r hyn a ddysgwyd o ymatebion diweddar i niwed sydd wedi digwydd ers tro er mwyn gwella’r systemau rhwymedi yn barhaus.
Yn y bôn, mae’r adroddiad yn annog y sefydliadau hynny sy’n gyfrifol am ymateb i honiadau o niwed i gofio eu bod yn ymdrin â bodau dynol sy’n wynebu sefyllfaoedd trawmatig ac emosiynol hynod anodd.
Darllenwch mwy: Adroddiad ‘Towards Justice’ yn galw am gydweithio er mwyn cefnogi dioddefwyr niwed yn y gorffennol | Bangor University
Iaith yn oes y ‘peiriant dynol’: Sut bydd ffurfiau newydd ar dechnoleg iaith yn newid y ffordd rydym yn cyfathrebu, ac yn newid iaith?
Fel rhan o rwydwaith ymchwil newydd, bu academyddion o Fangor yn archwilio sut mae datblygiadau technolegol megis teclynnau clyfar i’r llygaid a’r clustiau yn debygol o newid ein dulliau beunyddiol o gyfathrebu, y gallu i gyfieithu geiriau rhywun arall ac o ganlyniad, iaith ei hun.
Mae gan y rhwydwaith, Iaith yn Oes y Peiriant Dynol, aelodau o 52 o wledydd ac mae’n ceisio pontio’r bwlch rhwng ieithyddion ac arbenigwyr technoleg, fel bod ieithyddion yn gallu elwa o well gwybodaeth dechnolegol a bod arbenigwyr technoleg yn gallu elwa o well dealltwriaeth o ganlyniadau ieithyddol a chymdeithasol posib technolegau newydd.
Fel cam cyntaf pwysig, mae’r rhwydwaith wedi cyhoeddi adroddiad mynediad agored sy’n dwyn ynghyd fewnwelediadau gan ddwsinau o arbenigwyr ym meysydd technoleg iaith ac ymchwil ieithyddol.
Mae datblygiadau mewn cyfathrebu digidol dros y degawd diwethaf wedi chwyldroi sut rydym yn cyfathrebu ac yn cyrchu gwasanaethau. Mae hyn wedi cael ei gyflymu gan y pandemig Covid-19 a’r newidiadau
cymdeithasol sydd wedi dod yn ei sgil. Gyda datblygiad technoleg y gellir ei gwisgo a deallusrwydd artiffisial, rydym bellach ar drothwy newidiadau pellach fydd yn newid y ffordd yr ydym yn cyrchu gwybodaeth ac yn rhyngweithio ag eraill. Bydd gan y datblygiadau hyn oblygiadau pellgyrhaeddol i hawliau ieithyddol ac iaith mewn cymdeithas amlieithog.

Wrth i dechnolegau newydd effeithio ar bron bob agwedd o’n bywydau beunyddiol, gwyddom nad yw pob iaith, na phob grŵp, yn cael eu trin yn gyfartal o fewn y chwyldro digidol hwn, ac erys pryder ynghylch sut y gallai rhai cymunedau iaith heb ddigon o adnoddau a grwpiau ymylol gael eu gadael ar ôl gan y chwyldro digidol hwn yn oes y peiriant dynol, meddai Dr Cynog Prys o’r Ysgol Hanes, y Gyfraith a Gwyddorau Cymdeithas.
Darllenwch mwy:
Iaith yn oes y ‘peiriant dynol’: Sut bydd ffurfiau newydd ar dechnoleg iaith yn newid y ffordd rydym yn cyfathrebu, ac yn newid iaith? | Bangor University
Lleihau’r defnydd o ynni a dŵr
Hyrwyddo mentrau trafnidiaeth gynaliadwy
Sicrhau cydymffurfiaeth â’r holl ddeddfwriaeth a rhwymedigaethau perthnasol sy’n gysylltiedig â’n gweithgareddau
Lleihau ein cyfraniad at newid hinsawdd byd-eang drwy wneud gostyngiadau o flwyddyn i flwyddyn yn ein hallyriadau nwyon tŷ gwydr
Mynd ati i rwystro’r yr amgylchedd naturiol rhag cael ei lygru
Nod Prifysgol Bangor yw bod yn brifysgol y bydd y rhai sydd am wneud y ddaear yn blaned fwy cynaliadwy yn ei dewis. Mae arnom eisiau i’r Brifysgol gael ei hadnabod am gynaliadwyedd ac mae ein hymrwymiadau yn cefnogi’r dyheadau a nodir yn Neddf Llesiant Cenedlaethau’r Dyfodol (Cymru) ac yn 17 Nod Datblygiad Cynaliadwy’r Cenhedloedd Unedig.
Mae ein gwyddonwyr yn mynd i’r afael â newid yn yr hinsawdd ac yn rhoi sylw i rai o faterion amgylcheddol pennaf y blaned, ar y tir ac ar y môr, megis gorddefnyddio plastigion untro, a diogelu amrywiaeth rhywogaethau ac ecosystemau trwy ymchwil i gadwraeth bioamrywiaeth.
Mae Prifysgol Bangor wedi cael ei chydnabod â gwobrau amrywiol am ei hymrwymiad i yn cynnwys bod y brifysgol orau yng Nghymru a’r 11eg yn y Deyrnas Unedig yng Nghynghrair Effaith y Times Higher Education yn 2022.
Rydym ar flaen y gad o ran mynd i’r afael â heriau bydeang allweddol trwy ymchwil i faterion sy’n cynnwys newid yn yr hinsawdd, cadwraeth ac ecoleg, cynhyrchu pŵer a defnyddio ynni, diwylliannau lleol cynaliadwy, cynhyrchu bwyd a diogelwch dŵr, colli bioamrywiaeth a llygredd. Mae ein hymchwil yn cyfrannu hefyd at heriau cynaliadwyedd yn nes adref, gan weithio mewn partneriaeth â sefydliadau yng Ngogledd Cymru i helpu i wella ansawdd ein hamgylchedd a bywydau pobl.
Mae’n huchelgeisiau yn seiliedig ar dystiolaeth amlddisgyblaethol gadarn, yn tynnu oddi ar arbenigedd academaidd ac arbenigedd sylweddol arall y Brifysgol, ar draws pob agwedd ar gynaliadwyedd. Mae gwybodaeth yr arbenigwyr hyn eisoes yn cael ei chyhoeddi mewn cyfnodolion ac adroddiadau gwyddonol, ac mae aelodau staff unigol ac adrannau eisoes yn ymgorffori gweithredoedd cadarnhaol sy’n gysylltiedig â chynaliadwyedd ledled y brifysgol. Yn ogystal â sicrhau bod cynaliadwyedd yn cael sylw penodol fel rhan o brosesau strategol a chynllunio busnes y Brifysgol, mae’r Brifysgol yn sefydlu rhwydwaith o hyrwyddwyr cynaliadwyedd ac yn gweithio gydag Undeb y Myfyrwyr i hyrwyddo cynaliadwyedd ymhellach ar gyfer y myfyrwyr.
Rydym wedi ymrwymo i wella cynaliadwyedd ein campws trwy amrywiaeth o bolisïau penodol sy’n rhoi sylw i deithio, gwastraff ac ailgylchu, ynni a charbon, adeiladu, bioamrywiaeth, caffael bwyd o ffynonellau cynaliadwy a bod yn brifysgol Masnach Deg. Yn
ogystal ag uwchraddio systemau seilwaith trydanol a nwy a gosod offer mwy effeithiol o ran ynni, mae’r tîm
Gwasanaethau Campws yn rhan annatod o gefnogi
ymrwymiad y Brifysgol i leihau allyriadau carbon
gan 25% erbyn 2025. Ein nod cyffredinol yw bod
cynaliadwyedd yn cael ei ymgorffori i’r fath raddau
ym Mhrifysgol Bangor nes yn syml mai dyna’r ‘ffordd
rydym ni’n gwneud pethau yma’.
Gwreidio datblygiad cynaliadwy ac ymwybyddiaeth o faterion
amgylcheddol yn ein cwricwla ar draws y brifysgol
Hybu a chynyddu cadwraeth a gwella bioamrywiaeth ar draws ystad y brifysgo
Codi ymwybyddiaeth amgylcheddol ac ymwybyddiaeth o’r nodau datblygu cynaladwy ymhlith staff a myfyrwyr trwy wella cyfathrebu a chyfranogi
Gwreiddio cynaliadwyedd o fewn y gweithdrefnau caffael
Sefydlu amcanion a thargedau
amgylcheddol ac adrodd cynnydd bob blwyddyn
Rheoli gwastraff trwy leihau, ailddefnyddio, a hyrwyddo ailgylchu
Fel sefydliad mawr a phartner strategol yng Ngogledd Cymru, mae’r Brifysgol
wedi gweithio ar y cyd â phartneriaid
rhanbarthol i rannu arweiniad syniadol ac ymchwil ac arloesedd pwysig
i gefnogi effaith economaidd a chymdeithasol ehangach.
Mewn byd ôl-bandemig, bydd yr Ysgol Feddygol arfaethedig ar gyfer Gogledd Cymru yn cyflawni rôl bwysicach nag y gellid bod wedi’i dychmygu erioed drwy hyfforddi gweithlu’r dyfodol.
Mae angen gweithredu ar frys yn y rhanbarth i fynd i’r afael â nifer o broblemau rhyng-gysylltiedig, gan gynnwys prinder meddygon - yn enwedig meddygon dwyieithog. Ar ben hyn, mae angen i arloesi, mabwysiadu technolegau newydd ac atebion digidol a datblygu gwasanaeth newydd ddigwydd yn gyflymach ac ar raddfa fwy, gan adeiladu ar y gwersi a ddysgwyd yn ystod y pandemig coronafeirws.
Gan weithio mewn partneriaeth â Bwrdd Iechyd Prifysgol Betsi Cadwaladr a chyda chymorth gan Lywodraeth Cymru a Phrifysgol Caerdydd - sef ein partner wrth gyflwyno ein rhaglen feddygol israddedig

bresennol - mae’r cynlluniau cydweithredol hyn ar gyfer yr Ysgol Feddygol newydd yn arwydd o ddull ‘Cymru
gyfan’ o gyflawni rhaglen addysg feddygol lawn yng
Ngogledd Cymru ac yn fodd o gefnogi Llywodraeth Cymru i gyflawni ei Rhaglen Lywodraethu.
Ein nod yw system iechyd, gofal a lles integredig sy’n addas at y diben. Rydym yn anelu at sefydlu ecosystem i yrru ymchwil ac ymarfer blaengar ym maes atal ac ymyrraeth gynnar. Byddwn yn gweithio gyda diwydiant i ddatblygu capasiti a chyfleusterau i lywio gwaith ymchwil a datblygu a chymwysiadau addysg feddygol.
Ym mis Medi 2021, cymeradwyodd Llywodraeth Cymru fod modd dyblu nifer y myfyrwyr a dderbynnir i’r rhaglen FeddygaethC21NW bresennol a chadarnhau ei haddewid i sefydlu Ysgol Feddygol annibynnol newydd yng ngogledd Cymru i gynyddu niferoedd graddedigion meddygaeth yn lleol, ehangu mynediad at yrfa feddygol a gwella gofal i siaradwyr Cymraeg. Nod y rhaglen yw tyfu o’r mewnlif presennol o 25 o fyfyrwyr i 160 erbyn 2027, gan roi hwb mawr i anghenion staffio meddygol y rhanbarth.
Bydd Ysgol Feddygol newydd Gogledd Cymru yn helpu i fynd i’r afael â her swyddi gweigion meddygon ymgynghorol, lleihau dibyniaeth ar staff locwm, a rhoi profiad rhyngbroffesiynol sylweddol i bob myfyriwr o weithio mewn cymunedau a chyda meddygon teulu.

Mae Prifysgol Bangor a’r Labordy Niwclear
Cenedlaethol, sef labordy cenedlaethol y Deyrnas
Canolfan ymchwil gwerth miliynau o bunnoedd o fewn yr Ysgol Cyfrifiadureg a Pheirianneg Electronig yw’r Ganolfan Ragoriaeth Prosesu Signalau Digidol. O dan arweiniad yr Athro Jianming Tang mae’r ganolfan yn gwneud ymchwil tra arbenigol i systemau cyfathrebu digidol megis rhwydweithiau ac ecosystemau 5G. Mae ymgorffori algorithmau arloesol sy’n prosesu signalau digidol yn rhan o ddyfeisiau rhwydwaith yn ffordd gost-effeithiol o gyflymu rhwydweithiau, rhannu adnoddau rhwydwaith mewn modd deinamig ac optimaidd a gweithredu dyfeisiau y rheolir eu pŵer ar gyfer rhwydweithiau carbon isel.
Y Ganolfan Prosesu Signalau Digidol yw’r unig safle ymchwil yn y Deyrnas Unedig sy’n ymroddedig i fynd i’r afael â thechnoleg prosesu signalau digidol ar gyfer cymwysiadau’r dyfodol ac mae’n gweithio ochr yn ochr â mwy na 30 o bartneriaid mewn diwydiant i ddarparu atebion sy’n torri tir newydd ar gyfer amrywiol sectorau.
Y ganolfan hon oedd y cyntaf o’i math, ac ym mis Gorffennaf 2022 hwn oedd yr unig broject oedd yn weithredol fel rhan o Fargen Twf y Gogledd. Bydd yn derbyn £3m i’w fuddsoddi mewn offer o’r radd flaenaf i adeiladu prototeipiau i ddangos mewn modd effeithiol y gwahanol ffyrdd y gellir defnyddio’r arloesedd technolegol blaengar ac algorithmau unigryw hyn mewn sefyllfaoedd yn y byd go iawn.
Ers derbyn cyflenwad y flwyddyn gyntaf o offer, mae’r Ganolfan wedi sefydlu arddangoswyr mewn pedwar maes allweddol: Pensaernïaeth rhwydweithiau; Cydgyfeirio rhwydweithiau; Systemau trosglwyddo; a dyfeisiau trawsdderbynyddion a rhwydweithio.
Yn bresennol yn lansiad swyddogol project Canolfan Prosesu Signalau Digidol Bargen Twf y Gogledd ym mis Gorffennaf 2022 roedd y Prif Weinidog, Mark Drakeford, Aelod o’r Senedd, ac Is-ysgrifennydd Gwladol Seneddol Cymru, David TC Davies, Aelod Seneddol, Amlygodd y digwyddiad botensial enfawr technolegau prosesu signalau digidol gan gynnwys synwyryddion, rheoli traffig, trosglwyddo data’n ddiogel, rhithrealiti, delweddu ac ar ei lefel fwyaf syml gwella’n sylweddol gapasiti data a gallu ein rhwydweithiau ffibr.
Dywedodd y Cynghorydd Dyfrig Siencyn, Cadeirydd
Bwrdd Uchelgais Economaidd Gogledd Cymru, “Gyda bod technolegau o bwysigrwydd byd-eang yn cael eu datblygu yma, mae’r Ganolfan Prosesu Signalau Digidol yn rhoi Gogledd Cymru ar y map ac ar flaen y gad yn y sector cyffrous hwn.”

Yn ogystal ag ymchwil ac arloesi sy’n arwain yn rhyngwladol, mae’r Ganolfan hefyd yn darparu hyfforddiant ac yn datblygu sgiliau mewn cydweithrediad
â phartneriaid a thrwy raglenni meistr a PhD.
Rhaglen gwerth £240m yw Bargen Twf y Gogledd, a fydd yn darparu buddsoddiad yn y rhanbarth gyda’r nod penodol o ysgogi twf economaidd. Mae’r rhaglen, a reolir gan Fwrdd Uchelgais Economaidd Gogledd Cymru mewn partneriaeth ag awdurdodau lleol a phartneriaid mewn addysg uwch ac addysg bellach, yn canolbwyntio ar adeiladu economi mwy bywiog, cynaliadwy a gwydn yng Ngogledd Cymru yn seiliedig ar y cryfderau presennol.
Unedig ar gyfer ymholltiad niwclear, wedi arwyddo memorandwm cyd-ddealltwriaeth a fydd yn eu gweld yn cydweithio i hyrwyddo addysg ac ymchwil ym maes ynni niwclear, gan gynnwys sgiliau a hyfforddiant ar gyfer y diwydiant niwclear. Mae’r memorandwm cyd-ddealltwriaeth hefyd yn amlinellu ymrwymiad i weithio ar brojectau ymchwil ar y cyd ac yn rhannu seilwaith, cyfleusterau ac offer a fydd yn datblygu technolegau niwclear.
Dywedodd Dr Paul Howarth, Prif Swyddog Gweithredol y Labordy Niwclear Cenedlaethol: “Wrth inni geisio sicrhau dyfodol ynni glân i’r Deyrnas Unedig drwy dechnolegau niwclear mwy newydd a datblygedig, rydym yn cydnabod effaith a gwerth Cymru fel canolfan wyddoniaeth ac arloesi niwclear. Mae datblygu’r berthynas hon gyda Phrifysgol Bangor
Mae partneriaeth y Brifysgol â Santander wedi’i hymestyn am dair blynedd trwy ddyfarnu £58,500 ar gyfer amrywiaeth o fentrau gan gynnwys mentrau cyflogadwyedd a chynyddu entrepreneuriaeth.
Ymhlith llwyddiannau’r bartneriaeth flaenorol roedd rhoi cymorth i 62 o fusnesau newydd a mentrau llawrydd gan fyfyrwyr a chynnal 68 o interniaethau i fyfyrwyr.
yn dangos ein hymrwymiad i ddatblygu’r ymchwil, y sgiliau a’r galluoedd y bydd eu hangen yma ac ar draws y Deyrnas Unedig.”
Bydd y bartneriaeth yn ein galluogi i ehangu a chryfhau ein gallu ar y cyd mewn hydroleg thermol niwclear, tanwyddau newydd ac arloesol, systemau ynni niwclear a chyd-gynhyrchu. Bydd i’r gwaith hwn ran bwysig yng ngallu’r Deyrnas Unedig i ddatblygu’r gyfres nesaf o dechnolegau niwclear carbon isel, yn ogystal â chefnogi datblygiadau eraill er budd y cyhoedd megis iechyd trawsnewidiol a meddygaeth niwclear. Trwy fanteisio ar gyfleusterau a galluoedd o fri y Labordy Niwclear Cenedlaethol a Phrifysgol Bangor, byddwn nid yn unig yn cryfhau ac yn cynnal yr arbenigedd sydd gennym ni eisoes yn y sector niwclear ond hefyd yn sicrhau bod gennym ni’r bobl a’r sgiliau ar gyfer dyfodol clir newydd y Deyrnas Unedig.
Dywedodd Matt Hutnell, Cyfarwyddwr, Santander Universities UK, “Mae Santander wedi ymrwymo i gefnogi addysg uwch yn ogystal â chymunedau lleol ledled y Deyrnas Unedig. Rydym yn falch o barhau â’n partneriaeth gyda Phrifysgol Bangor i sicrhau y gallwn gydweithio i ddarparu hyd yn oed mwy o gyfleoedd a fydd o fudd i fyfyrwyr a’r gymuned leol.”

Mae M-Sparc, gan Brifysgol Bangor, sef parc gwyddoniaeth cyntaf Cymru, yn darparu ystod o fanteision a buddion i fusnesau arloesol ac yn cefnogi dyhead y Brifysgol i weld ychwaneg o gyflogadwyedd, busnesau newydd a masnacheiddio ar draws Gogledd Cymru. Mae’n rym sy’n sbarduno arloesedd yn y rhanbarth a’i nod yw arallgyfeirio’r economi, creu cyfleoedd gyrfa newydd a helpu busnesau i ffynnu.

Lansiodd M-SParc raglen recriwtio uchelgeisiol yn 202122 a oedd yn cynnig bron i 50 o gyfleoedd cyflogaeth yn y sector gwyddoniaeth a thechnoleg. Mae rhaglen yr Academi Sgiliau yn darparu cyfleoedd i raddedigion, pobl sydd wedi eu tangyflogi neu sy’n dymuno uwchsgilio a’r rhai y mae arnynt eisiau newid gyrfa i gael eu lleoli gyda chwmnïau yn M-SParc a’r ecosystem o’i gwmpas, gan gynnig profiad gwaith gwerthfawr a chyfle i ddatblygu eu sgiliau.
Gan barhau i ddatblygu llwyddiant nodedig wrth gefnogi busnesau newydd mwyaf arloesol y rhanbarth, dyfarnodd rhaglen cyflymydd M-Sparc, y Lefel Nesaf, £110,000 o gefnogaeth i bedwar busnes yn y rhanbarth. Drwy helpu perchnogion busnes uchelgeisiol i ddatblygu’r sgiliau, y ffocws a’r hyder sydd eu hangen i arwain busnes newydd llwyddiannus, cynigiodd y Lefel Nesaf becyn cynhwysfawr o gefnogaeth, arweiniad a chyfleoedd i naw o fusnesau newydd blaenllaw yng Ngogledd Cymru.
Rhaglen pum mis yw’r Lefel Nesaf, sy’n rhoi mynediad unigryw i sylfaenwyr uchelgeisiol at fentora arbenigol, cymuned o sylfaenwyr o’r un anian a nhw, bwrdd ymgynghorol byd-eang a rhwydweithiau pwerus a chyfleoedd unigryw ar gyfer twf. Mae prif gefnogwyr y rhaglen yn cynnwys rhai o gyn-fyfyrwyr proffil uchel Prifysgol Bangor sy’n darparu cyngor mentora. Gan adeiladu ar ei llwyddiant mae’r rhaglen yn parhau i roi cymorth heb ei ail i fusnesau newydd arloesol, ac mae ceisiadau bellach yn cael eu hystyried ar gyfer ail garfan y rhaglen.
Cafodd grant Cyllid ar gyfer Llwyddiant o £14,000, sef grant a sefydlwyd i roi cyllid ychwanegol i denantiaid a thenantiaidrhithioligefnogitwfadatblygullwybraunewydd i’r farchnad, ei ddyfarnu i denantiaid gan gynnwys: Pellyi greu cytundebau i gyfranddalwyr a derbyn cefnogaeth gyda nodau masnach, sy’n waith hanfodol a fyddai wedi bod yn faich ariannol i fusnes newydd; PlantSea - i brofi eu ffilmiau gwymon ar linellau diwydiannol, gan fynd â nhw gam yn nes at fasnacheiddio; Fortytwable - i brynu drôn, gan alluogi ffocws amaethdechnoleg newydd i’r busnes; a Bleeper Services - i greu swydd amser llawn yn rheoli eu gwefan e-fasnach newydd.
Bu gwelliant sylweddol yn lefelau boddhad myfyrwyr Prifysgol Bangor mewn meysydd allweddol o addysgu a dysgu yn 2021-22. Cafodd y gwelliant hwnnw ei adlewyrchu gan sgôr oedd ymhell uwchlaw cyfartaledd y sector ar gyfer meysydd addysgu a dysgu yn yr Arolwg Cenedlaethol Myfyrwyr diweddaraf, gyda boddhad myfyrwyr ar gyfer yr addysgu ar fy nghwrs bellach yn 83%, i fyny 19% ers y flwyddyn flaenorol, ac i fyny eto ers y flwyddyn flaenorol ar gyfer cyfleoedd dysgu, sydd bellach yn 80%. Rydym yn hynod falch o’r canlyniadau hyn.
Llwyddiant arall yw’r gwelliant o ran ein safle yn The Times and Sunday Times Good University Guide lle dringodd Prifysgol Bangor 48 safle i fod yn 20fed yn y Deyrnas Unedig ar gyfer ansawdd addysgu.
Yn ystod y flwyddyn academaidd hon bu’r Brifysgol yn gweithio ar brojectau allweddol ac yn gwneud hyd yn oed yn rhagor i wella’r amgylchedd dysgu i fyfyrwyr. Roedd hyn yn cynnwys integreiddio gweithgarwch wyneb yn wyneb ar y campws â’r arlwy dysgu ar-lein i gynnig profiad addysgu a dysgu o’r ansawdd uchaf.
Gyda budd y mewnwelediadau unigryw a’r cyfle dysgu a ddaeth yn sgil troi i addysgu ar-lein yn ystod pandemig Covid-19, fe wnaethom ganolbwyntio ar gynnal a gwella ein dysgu digidol trwy ddatblygu ymhellach allu digidol ein myfyrwyr a’n staff academaidd a’n hamgylchedd dysgu ac addysgu digidol yn y sefydliad.
Cafodd ein project dysgu digidol ei wella ar draws y Brifysgol, gyda chefnogaeth Cronfa Adfer a Buddsoddi mewn Addysg Uwch (HEIR)
Cyngor Cyllido Addysg Uwch Cymru (HEFCW) a grëwyd i alluogi prifysgolion Cymru i gynnal capasiti hanfodol a chynorthwyo adferiad economaidd yng nghyd-destun effaith y pandemig.
Er mwyn llywio’r ffocws hwn ar y digidol, casglwyd ymatebion y myfyrwyr i arolwg Mewnwelediadau Profiad Digidol Jisc yn 2021 a 2022. Cawsom adborth cadarnhaol, gyda myfyrwyr yn canmol gallu digidol y sefydliad, ansawdd y gefnogaeth a ddarperir, a’r hyblygrwydd a gânt trwy ddysgu ar-lein.

Amlygwyd meysydd i’w datblygu hefyd, ac fe wrandawom ar y galw gan fyfyrwyr am hyfforddiant ac arweiniad ar-lein, ar yr awydd am sesiynau ar-lein mwy deniadol a rhyngweithiol a gwell cyfathrebu digidol. Rhoddwyd nifer o ymyriadau ar waith gan gynnwys y canlynol:
datblygu’r llwyfan pontio BOD YN BAROD I FANGOR sy’n cynnwys gwybodaeth ac arweiniad am ein prosesau a llwyfannau ar-lein i fyfyrwyr sy’n cyrraedd i’w cefnogi i bontio i addysg uwch
— prynu Jisc Discovery Tool, a gynlluniwyd i rymuso staff a myfyrwyr i adfyfyrio ar eu gallu digidol a nodi meysydd i’w datblygu
— archwiliad o’n mannau addysgu i sicrhau eu bod yn addas ar gyfer addysgu ar-lein ac i hwyluso gallu croesawu’r holl fyfyrwyr yn ôl i’r campws
— canllawiau ychwanegol i staff a myfyrwyr ar sut orau i ddefnyddio
technolegau digidol wrth addysgu a dysgu, moeseg y we, a buddsoddi mewn cyrsiau hyfforddi allanol i gefnogi datblygiad proffesiynol parhaus staff
Gwahoddwyd ysgolion academaidd y Brifysgol i wneud cais am grantiau Addysgu a Dysgu digidol a gyllidwyd gan HEFCW i gefnogi project arloesol a fyddai’n gwella profiad staff a myfyrwyr. Dyfarnwyd chwe grant a galluogodd y rhain sawl gwelliant i addysgu digidol.
Cafodd llwyddiant yr ymyriadau hyn ei fonitro ar lefel pob ymyriad unigol a thrwy gymharu â chanlyniadau arolygon Mewnwelediadau Profiad Digidol (DEI) 2021 a 2022 gan ddangos y cynnydd a wnaed:
Yn gyffredinol, beth yw eich barn am ansawdd dysgu ar-lein a dysgu digidol ar eich cwrs?
% y myfyrwyr a oedd yn cytuno â’r gosodiad ‘Y gorau y gellid ei ddychmygu i Dda’: 2021- 69%, 2022- 81% (Cymru, 78%, Sector, 74%)
% y myfyrwyr a gytunodd â’r gosodiad ‘Mae eich deunyddiau dysgu ar-lein yn ennyn diddordeb ac yn ysgogol’:2021- 36% (Cymru 39%, sector 35%); 2022 - 52% (Cymru = 47%, Sector = 43%)
Data: Arolwg Mewnwelediadau Profiad Digidol Jisc
Yn ystod y pandemig, wynebom her o ran darparu ein dulliau addysgu, wrth i ni addasu i’r amgylchedd newidiol. Fe ddechreuom archwilio technegau efelychu newydd ac arloesol a fyddai’n ymgysylltu’n â’n myfyrwyr bydwreigiaeth. Fe ddaethom o hyd i efelychiadau esgor a geni trwy rithrealiti (VR) ac roeddem am ddod â’r dechnoleg hon i Brifysgol Bangor.
Ar hyn o bryd mae’r efelychiad yn canolbwyntio ar enedigaeth ffisiolegol normal, fodd bynnag, mae’r dechnoleg yn cael ei datblygu i gynnwys senarios esgor a genedigaeth mwy cymhleth i gynnwys argyfyngau obstetrig. Ein nod yw integreiddio’r efelychiad rhithrealiti ar draws y tair blynedd, felly, yn ddibynnol ar eu cyfnod dysgu, gall myfyrwyr elwa o’r dechnoleg rhithrealiti trwy gydol eu taith israddedig.
Lauren Irving — Ysgol Gwyddorau Meddygol ac Iechyd
Mae defnyddio camerâu Go-Pro Hero a phensetiau rhithrealiti Oculus wir yn rhoi profiad mwy trochol na fideo traddodiadol - mae hyn hyd yn oed yn wir mewn golygfa pan fo’r targed dysgu yn 2D yn bennaf, megis wyneb craig pan mai tasg y cyfranogwyr yw nodi gwahanol dacsonau. Mae’n well mynd i’r afael â llawer o’r sgiliau maes y mae arnom eisiau i fyfyrwyr eu datblygu yn y modd 360 hwn. Er enghraifft, mae dehongli geomorffoleg yr ardal gyfagos ar sail arsylwadau trosolwg cychwynnol yn bosibl mewn modd 360; gall y tiwtor enghreifftio strata penodol mewn allfrigiad creigiog ac yna gofyn i gyfranogwyr nodi enghreifftiau eraill ar bwyntiau ymhellach ymlaen yn y fideo. Gellir dilyn hyn â thrafodaeth gyda’r myfyrwyr am yr hyn y mae’r haenau hynny’n ei ddweud ynglŷn â’r amodau pan ffurfiwyd y graig, er enghraifft. Mae hefyd yn bosibl defnyddio’r fideo i fyfyrwyr wneud brasluniau ac ysgrifennu nodiadau arsylwadol sy’n bwysig o ran datblygu’r sgil o grynhoi gwybodaeth.
Mae’r myfyrwyr wedi cael cipolwg ar botensial ymchwil amlddisgyblaethol dan arweiniad ymarfer gyda’r adran a sut y gall ymarfer artistig gysylltu ag adrannau eraill o fewn y Brifysgol a thu hwnt trwy dechnoleg ddigidol. Maent hefyd wedi cael eu cyflwyno i dechnolegau newydd i archwilio eu harferion ymchwil ymhellach.
Ffion Evans — Pennaeth Drama, Theatr a Pherfformio
Datblygwyd Strategaeth Ehangu Mynediad Prifysgol Bangor yn 2021-22 a gynlluniwyd i gynnig dull cynhwysfawr gan ddechrau gyda chodi dyheadau yn y blynyddoedd cynnar, hyd at yrfaoedd hirdymor llwyddiannus a chynaliadwy y tu hwnt i addysg uwch. Cefnogir ein dull strategol o ehangu mynediad gan ein Cynllun Ffioedd a Mynediad sefydliadol sy’n manylu ar ein cynlluniau gweithredol gan gynnwys ond heb fod yn gyfyngedig i, codi dyheadau, recriwtio, addysgu a dysgu, cefnogi myfyrwyr, cyfle cyfartal, dilyniant a gyrfaoedd.
Y Brifysgol hefyd yw partner arweiniol y Bartneriaeth Ymestyn yn Ehangach sy’n cynnwys Gogledd a Chanolbarth Cymru. Nod y strategaeth sefydliadol yw ategu’r rhaglen hon a’r strategaeth, ychwanegu gwerth at y rhaglen Ymestyn yn Ehangach a helpu cynyddu’r effaith sydd iddi’n rhanbarthol ac yn genedlaethol. Egwyddor graidd y strategaeth yw galluogi llwyddiant cenedlaethau’r dyfodol. Yn hynny o beth, nod y strategaeth hon yw cefnogi egwyddorion
Deddf Llesiant Cenedlaethau’r Dyfodol a’r pum ffordd o weithio: hirdymor, integreiddio, ymwneud, cydweithredu ac atal.
Yn 2021-22 lansiodd Prifysgol Bangor strategaeth Recriwtio a Symudedd Rhyngwladol uchelgeisiol. Mae’r strategaeth sy’n sail i Strategaeth 2030 wedi ei datblygu i gryfhau ymgysylltiad rhyngwladol Bangor, gan ganolbwyntio ar recriwtio myfyrwyr, datblygu partneriaethau a symudedd myfyrwyr.
Mae’r strategaeth yn nodi y bydd Prifysgol Bangor yn datblygu presenoldeb rhyngwladol cryfach ac iddo fwy o ffocws ac sy’n rhoi cyfle gwirioneddol i’r Brifysgol adeiladu ar yr agenda addysg uwch bresennol yng Nghymru a helpu i gyflawni’r uchelgais o fynd â Bangor allan i’r byd a dod â’r byd yma i Fangor.
Roedd y Brifysgol yn falch iawn o gael ei hailachredu gan Advance HE, gan atgyfnerthu ein hymrwymiad i ragoriaeth addysgu. Derbyniodd Bangor wyth canmoliaeth am ei darpariaeth achrededig, ac roedd y cadarnhad o’r ail-achrediad yn cynnwys y sylw a ganlyn:
Yn fras, mae gan ein dull strategol yr hyblygrwydd i ymateb i flaenoriaethau ac anghenion cenedlaethol a rhanbarthol, yn ogystal â chefnogi blaenoriaethau
HEFCW mewn modd effeithiol. Bydd hon yn parhau i fod yn strategaeth ddeinamig a hyblyg a gaiff ei haddasu dros amser i sicrhau y bydd yn berthnasol ac yn effeithiol.
Mae Prifysgol Bangor yn dangos ymrwymiad sefydliadol i ddatblygiad proffesiynol staff sy’n addysgu ac yn cefnogi dysgu a hynny trwy ddilyn Fframwaith Safonau Proffesiynol y Deyrnas Unedig a chynnwys cymrodoriaethau yn rhan o strategaethau a pholisïau sefydliadol, gan gynnwys Strategaeth 2030, sy’n cael ei hategu gan themâu trawsnewidiol sy’n cyd-fynd ag arfer cynhwysol a Gwerthoedd Proffesiynol y Fframwaith Safonau Proffesiynol.
Mae hwn yn ganlyniad gwych i’r Brifysgol gan ei fod yn cydnabod ein hymrwymiad parhaus i gyflwyno a chefnogi addysgu a dysgu o’r ansawdd uchaf. Mae hefyd yn galluogi staff ar draws y Brifysgol i dderbyn cydnabyddiaeth broffesiynol am eu hymrwymiad i ragoriaeth drwy feincnodi yn erbyn y Fframwaith Safonau Proffesiynol sy’n gosod safonau ansawdd a gydnabyddir yn rhyngwladol.
Mae’r Strategaeth Ryngwladol yn gosod gweledigaeth i’r Brifysgol fod yn uchelgeisiol yn fyd-eang, chwarae rôl allweddol mewn partneriaethau addysg ac ymchwil rhyngwladol, galluogi dylanwad a chysylltedd rhyngwladol ehangach i Ogledd Cymru, a chwarae rhan weithredol mewn Cymru sy’n gyfrifol yn fyd-eang drwy ganolbwyntio ar dri maes allweddol sy’n cynnwys: Sicrhau profiad byd-eang i bob myfyriwr graddedig trwy addysg drawswladol a symudedd myfyrwyr; cynyddu ein poblogaeth o fyfyrwyr rhyngwladol; a gwella safle byd-eang y Brifysgol drwy ddatblygu ymchwil rhyngwladol ac iddo effaith fyd-eang amlwg.
Mae’r Brifysgol yn ymrwymedig i ddatblygiad ein myfyrwyr trwy gefnogi eu gwybodaeth, eu dealltwriaeth, y sgiliau a’r priodoleddau sydd eu hangen arnynt i weithio a byw mewn ffordd sy’n diogelu lles amgylcheddol, cymdeithasol, economaidd a diwylliannol, yn awr ac ar gyfer cenedlaethau’r dyfodol.
Mae creu amgylchedd dysgu ysbrydoledig a chefnogol yn sbardun allweddol, gan weithio mewn partneriaeth â’n myfyrwyr trwy ein pwyllgorau ac yn rhediad y Brifysgol o ddydd i ddydd i sicrhau cynrychiolaeth, ymgynghori a chydweithio â myfyrwyr yn seiliedig ar agenda o barch at y naill a’r llall.
Er i flwyddyn academaidd 2021-22 barhau i fod yn her o ran addysgu ac astudio oherwydd cyfyngiadau parhaus y pandemig, darparodd y Brifysgol brofiad rhagorol i fyfyrwyr trwy ei fframwaith hirsefydlog yn unol â’r protocolau Covid-19. Gyda’r rheoliadau’n llacio tua diwedd y flwyddyn academaidd, adolygodd y Brifysgol y sefyllfa’n gyflym ac ymateb i’r newidiadau i ddarparu’r profiad gorau posibl i fyfyrwyr wrth sicrhau bod eu diogelwch yn parhau i fod yn ystyriaeth hollbwysig.
Yng ngwobrau WhatUni Student Choice 2022, roedd Prifysgol Bangor yn bedwerydd yn y Deyrnas Unedig yn y categori Prifysgol y Flwyddyn. Roedd y Brifysgol yn ail yn y categori Rhyngwladol, ac yn drydydd yn y categorïau Neuaddau Prifysgol ac Ôl-raddedig. Yn ogystal, enwyd Undeb Bangor yn bumed yng nghategori’r Undeb Myfyrwyr gorau. Mae’r gwobrau’n adlewyrchu ein hymrwymiad i brofiad myfyrwyr ac yn gydnabyddiaeth o waith caled ac ymrwymiad y swyddogion sabothol, Undeb y Myfyrwyr a’r staff.

Cyflogadwyedd: Darparu hyfforddiant a phrofiad gwaith i’n myfyrwyr
Roedd ein rhaglen o interniaethau israddedig yn cynnig y cyfle i fyfyrwyr wneud cais am 62 o brojectau gyda’r ymgeiswyr llwyddiannus yn elwa o gael profiad ar interniaeth. Gyda chyllid hael gan Santander Universities, gwahoddwyd ceisiadau gan fyfyrwyr a graddedigion i ariannu cyrsiau hyfforddi ychwanegol neu gyflenwol a chawsom fwy na 700 o geisiadau. Dyfarnwyd £32,500 i 84 o fyfyrwyr a chyn-fyfyrwyr ifanc, gan eu galluogi i ennill cymwysterau mewn pethau megis gyrru, rheoli projectau a phlymio tanfor i enwi dim ond rhai, yn ogystal â darparu cymorth ariannol i ennill profiad gwaith graddedig dros yr haf.
Cefnogi myfyrwyr i archwilio a pharatoi ar gyfer hunangyflogaeth a dechrau busnes
Yn 2022 recriwtiodd y Brifysgol Gydlynydd Busnesau Cychwynnol Graddedigion sydd wedi bod yn darparu mentora un-i-un a chymorth ymarferol i 63 o fyfyrwyr sydd â diddordeb mewn datblygu eu syniadau busnes neu dyfu eu busnesau. Yn ogystal, ariannwyd 47 o fyfyrwyr i gael profiad hunangyflogaeth trwy leoliadau a bwrsariaethau.
Cefnogi cyn-fyfyrwyr i ddod yn agosach at y farchnad swyddi i raddedigion

Yn ystod 2021-22, darparodd ein Rhaglen Cefnogaeth i Raddedigion gefnogaeth bwrpasol i 124 o raddedigion diweddar a oedd yn wynebu rhwystrau wrth chwilio am swyddi i raddedigion, gan gynnwys 25 o gyfleoedd lleoliad profiad gwaith cyflogedig. Aeth 61% o’r graddedigion a ymgysylltodd â’r rhaglen ymlaen i gael swyddi graddedig.
Cronfa Caledi Digidol i Fyfyrwyr
Cefnogodd y Brifysgol fyfyrwyr a brofodd rwystrau yn cael mynediad at ddarpariaeth ar-lein o ganlyniad uniongyrchol i’r pandemig Covid 19. Yn 2021-22, bu’r Uned
Cefnogaeth Ariannol yn ymdrin â 1,299 o ymholiadau gan fyfyrwyr yn ymwneud â
chaledi digidol gan brosesu 1,056 o daliadau, sef cyfanswm o £483,603.99.
Mae enghreifftiau o gyfarpar a darpariaethau digidol a dderbyniwyd gan fyfyrwyr yn cynnwys gliniaduron, cyfrifiaduron personol, tabledi, uwchraddio cysylltiadau rhyngrwyd, clustffonau a sgriniau cyfrifiadur ychwanegol.
Mae ysgoloriaethau Bangor Gynhwysol yn cefnogi myfyrwyr sy’n graddio i barhau â’u hastudiaethau ym Mangor - yn enwedig mewn meysydd lle ceir tangynrychiolaeth ar le fel ôl-radd a/neu lle mae grwpiau penodol yn gadael y meysydd hynny yn ystod eu gyrfa.
Fel aelod o siarter Athena Swan - ac felly wedi ymrwymo i gydraddoldeb rhyw ac amrywiaeth ac i greu a hyrwyddo diwylliant cynhwysol - dyfarnwyd ein Hysgoloriaethau Bangor Gynhwysol i dri o raddedigion eithriadol - sef Mae Bernard, Eddie Cox a Thea Moule.
Mae cymryd rhan mewn gwaith cydraddoldeb, amrywiaeth a chynhwysiant yn bwysig i mi oherwydd fy mod yn ymdrechu i wneud y byd yn lle gwell i’r cenedlaethau ar fy ôl ac mae cydraddoldeb i bawb yn bwysig rhan o hynny. Ar ben hynny, gall amrywiaeth a chynhwysiant mewn lleoliadau addysg helpu i gael gwared ar ragfarn ddiwylliannol a chyfoethogi’r gymdeithas ehangach trwy gynnig profiadau a safbwyntiau newydd.
Mae Bernard — sy’n astudio am MSc mewn Niwroddelweddu yn yr Ysgol Gwyddorau Dynol ac Ymddygiadol
Mae Prifysgol Bangor wedi bod yn gefnogol iawn i faterion yn ymwneud â chydraddoldeb, amrywiaeth a chynwysoldeb yn fy maes i yn ystod fy ngradd israddedig ac mae’n amlwg bod llawer o ddarlithwyr a staff benywaidd yn wybodus iawn am gynhwysiant. Dwi’n ddiolchgar iawn am y gefnogaeth ges i gan grŵp Athena Swan y Brifysgol ac edrychaf ymlaen at y cyfle i wthio am gynwysoldeb, yn y Brifysgol ac o fewn fy maes ehangach.
— sy’n astudio am MA mewn Archaeoleg Geltaidd yn yr Ysgol Hanes, y Gyfraith a Gwyddorau Cymdeithas
Mae’n anrhydedd ac rwyf yn teimlo’n hynod ddiolchgar i dderbyn yr Ysgoloriaeth Bangor Gynhwysol i astudio MRes mewn Bioleg Môr. Bydd yr ysgoloriaeth yn rhoi i mi’r sefydlogrwydd ariannol i fedru ymroi yn llawn i weithio ar fy mhwnc ymchwil. Ar ben hynny, bydd yn fy ngalluogi i symud ymlaen â fy nyheadau o ran gyrfa sef bod yn ymchwilydd ecoleg môr.
Thea Moule — sy’n astudio am MRes mewn Bioleg Môr yn Ysgol Gwyddorau’r Eigion
Cynhaliodd Undeb Bangor, sef undeb y myfyrwyr, lawer iawn o weithgaredd a gwaith yn ystod 202122 gyda’n cyd-fyfyrwyr, ein Swyddog Myfyrwyr a thimau staff. Ein blaenoriaeth oedd cefnogi myfyrwyr, cynrychioli eu llais a chynnig cyfleoedd iddynt.
Rydym wedi gweithio’n agos gyda’r Brifysgol i sicrhau bod buddiannau ein myfyrwyr wedi’u cynrychioli’n effeithiol ac mae ein hymwneud â phenderfyniadau ynghylch newidiadau i gyfyngiadau COVID-19 yn enghraifft gref o’n dull o weithio mewn partneriaeth ac o’r cysylltiadau gwaith agos sydd gennym. Yn 202122 buom yn gweithio i sicrhau ein bod yn ymgynghori â myfyrwyr ynghylch strategaethau Rhyngwladol, Cynaliadwyedd, Cyflogadwyedd ac Ehangu Mynediad a Chenhadaeth Ddinesig y Brifysgol.
Roedd projectau partneriaethol eraill yn cynnwys project Myf.Cymru a ariennir gan HEFCW, i wella cefnogaeth iechyd meddwl a lles i fyfyrwyr trwy gyfrwng y Gymraeg; digwyddiadau i wella profiad myfyrwyr; nodweddion addysgol i fyfyrwyr; diogelwch myfyrwyr a mynd i’r afael ag aflonyddu; cydweithio â myfyrwyr-ymgynghorwyr ar strategaeth iechyd meddwl dan arweiniad myfyrwyr y Brifysgol; a hyrwyddo urddas mislif gyda’r Brifysgol yn ymrwymo i sicrhau mynediad at gynnyrch mislif yn rhad ac am ddim ar draws y campws yn dilyn peilota’r cynllun Tlodi ac Urddas Mislif yn llwyddiannus dan arweiniad Undeb y Myfyrwyr. Projectau cydweithredol oeddent i gyda, ac mae’r gwaith partneriaethol a welsom yn ystod y cyfnod hwn yn dangos pa mor fuddiol yw cael Undeb Myfyrwyr annibynnol a chryf yn gweithio i gynrychioli buddiannau pob myfyriwr.
Fe wnaethom ddatblygu mentrau iechyd a lles yn defnyddio £103,605 gan y Brifysgol trwy HEFCW i gefnogi lles ac iechyd myfyrwyr. Cafodd y cyllid hwn effaith gadarnhaol iawn gan gefnogi lles myfyrwyr mewn sawl maes o roi cyfle iddynt gymdeithasu, adeiladu tîm, cysylltu â ffrindiau a phobl newydd er mwyn dysgu gyda nhw, herio eu hunain yn gorfforol ac yn feddyliol, datblygu sgiliau newydd a hunanhyder.
Fel llywyddion Undeb y Myfyrwyr ac Undeb Myfyrwyr
Cymraeg Bangor (UMCB) rydym yn aelodau o Gyngor y Brifysgol ac mae’r swyddogion sabothol yn aelodau o holl grwpiau strategaeth y Brifysgol. Roedd y llywydd yn rhan o’r broses o benodi’r Is-ganghellor a bu swyddogion sabothol eraill yn ymwneud ag ymgysylltu
â rhanddeiliaid fel rhan o’r broses. Rydym yn falch o’r cyfraniad a wnaethom at lawer o fentrau yn ystod y flwyddyn ac rydym hefyd wedi cynnal sesiynau holi ac ateb gydag aelodau o Fwrdd Gweithredol y Brifysgol.
Cafodd ein Strategaeth ar gyfer 2021-24 ei lansio ym mis Medi 2021 ac mae’n ein helpu i ddarparu profiad myfyriwr o’r ansawdd gorau i’n corff amrywiol o fyfyrwyr. Fe’i cynlluniwyd i gyfrannu at Strategaeth 2030 y Brifysgol. Hefyd aeth Undeb y Myfyrwyr ati i ailstrwythuro eu staff a gwnaethpwyd hynny ym mis Ionawr 2022. Roeddem yn gyffro i gyd o gael lansio Canolbwynt Gweithgareddau’r Undeb uwchben Bar Uno gyda chymorth cyllid cyfalaf gan HEFCW i wella profiad y myfyrwyr. Mae’r gofod wedi’i drawsnewid ar gyfer grwpiau myfyrwyr ac mae’n ganolbwynt cymdeithasol i glybiau, cymdeithasau a phrojectau gwirfoddoli’r Undeb, gan atgyfnerthu a gwella cyfleusterau cyfarfod i glybiau a chymdeithasau, gan greu ymdeimlad o hunaniaeth a lle.
Yn 2022 fe wnaethom gynnal ein seremonïau gwobrwyo yn y cnawd am y tro cyntaf ers 2019. Roeddent yn cydnabod llwyddiannau a chyfraniadau rhagorol ac yn dathlu gwaith caled ac ymroddiad ein myfyrwyr gwych a hefyd yn cydnabod addysgu rhagorol, a chyfraniadau a chefnogaeth gan staff ar draws y Brifysgol.
Cynhaliwyd yr Eisteddfod Ryng-golegol ym Mangor wedi ei threfnu gan UMCB ac enillodd Prifysgol Bangor yr Eisteddfod am y seithfed flwyddyn yn olynol. Ystyrir yr Eisteddfod yn un o’r prif ddigwyddiadau cymdeithasol
a diwylliannol yng
nghalendr unrhyw fyfyriwr Cymraeg
neu unrhyw ddysgwr Cymraeg sy’n astudio yng
Nghymru. Aethom hefyd â 900 o gystadleuwyr a gwylwyr lawr i Aberystwyth ar gyfer Pencampwriaeth
Ryng-golegol a Gŵyl Gymdeithasau Bangor yn erbyn
Aberystwyth, ac roeddem wrth ein bodd yn dod â’r tlws yn ôl i Fangor am y chweched flwyddyn yn olynol.
Gosodwyd Undeb Bangor yn y pumed safle yng
nghategori Undeb Myfyrwyr y Flwyddyn yng
ngwobrau WhatUni Student Choice 2022, ac yng nghynghrair Student Crowd gosodwyd Undeb Bangor yn yr 20 uchaf yn y categori Undeb Myfyrwyr Gorau ac yn y 10 uchaf yng nghategori’r Clybiau a Chymdeithasau Gorau. Mae’r gwobrau hyn yn seiliedig ar adolygiadau myfyrwyr go iawn. Enillom wobr Cymuned ac Undod UCM Cymru, sef gwobr sy’n cydnabod projectau eithriadol sydd wedi dod â chymunedau ynghyd. Roedd hyn ar gyfer ein gwaith gwirfoddoli myfyrwyr gyda’r henoed a phlant.

Unwaith eto rydym wedi derbyn gwobr Rhagoriaeth Effaith Werdd am ein gwaith a’n mentrau cynaliadwyedd.
Dyma’r unfed flwyddyn ar ddeg o’r bron i Undeb Bangor ennill y wobr hon oherwydd ymdrechion ei staff, y swyddogion a’r myfyrwyr i fynd i’r afael â materion pwysig o ran cynaliadwyedd a’r amgylchedd, yn ogystal â gweithio i ymgorffori newidiadau cynaliadwyedd cadarnhaol ym Mhrifysgol Bangor.
Rydym hefyd wrth ein boddau ein bod wedi cyrraedd y brig fel yr Undeb Myfyrwyr â’r sgôr uchaf yng Nghymru am foddhad myfyrwyr yn yr Arolwg Cenedlaethol Myfyrwyr. Byddwn yn parhau i weithio’n galed i sicrhau bod boddhad myfyrwyr yn parhau i fod yn uchel ym Mhrifysgol Bangor ac i sicrhau bod myfyrwyr Bangor yn caru bywyd myfyrwyr. Mae’r gwobrau hyn yn dyst i’r gwaith caled a wnaed gan dîm yr Undeb ac arweinwyr y myfyrwyr i greu profiad gwych i fyfyrwyr gan ddod â’r gymuned myfyrwyr at ei gilydd yn ystod y cyfnod anodd hwn.
Nyah Lowe Llywydd Undeb y Myfyrwyr Celt John Llywydd UMCBDatblygwyd Strategaeth Pobl a Thalent Prifysgol Bangor yn 2021-2022 i greu amgylchedd sy’n galluogi ein staff i ffynnu ac i gyflawni eu potensial. Ein gweledigaeth yw y bydd y Brifysgol yn creu diwylliant lle gallwn siarad yn agored am iechyd a lles; ymrwymo i gefnogi ein staff a’n myfyrwyr i gynnal ffordd iach o fyw gyda ffocws cadarn ar atal a lleihau afiechyd a gyrru newid cymdeithasol trwy roi prawf ar ymyriadau sy’n seiliedig ar ymchwil a’u defnyddio er budd ein cymuned fyd-eang yn ehangach.
Un dull o sicrhau bod y strategaeth yn cael ei gwireddu yw cynnal arolygon staff sy’n ffordd o gasglu adborth am beth sy’n dda am weithio yn y Brifysgol a beth sydd angen ei wella. Rhoddodd arolwg staff 2022 drosolwg i’r Brifysgol o brofiadau staff. Er bod Covid-19 wedi cyflymu newidiadau i ffyrdd pobl o weithio ac wedi galluogi datblygu gwahanol ffyrdd o feddwl, roedd staff eisoes yn pwyso am ffyrdd newydd o weithio. Yr her nawr yw sut i gyfathrebu ac adeiladu diwylliant sy’n adlewyrchu sut a beth yr ydym eisiau ei ddatblygu a’i wella yn ogystal â chefnogi anghenion ein staff. Edrychodd ein harolwg staff ar ystod eang o themâu, megis arweinyddiaeth, cydraddoldeb ac amrywiaeth, boddhad mewn swydd, amgylchedd gwaith, gwaith tîm, cyflog a buddion, cyfathrebu, lles a safbwyntiau pobl am yr hyn y mae’r Brifysgol yn ei wneud yn dda ynghyd â pha welliannau y dylid eu gwneud. Dangosodd y canlyniadau, a gyhoeddwyd ym mis Ebrill 2022, fod 88% o staff yn teimlo bod y Brifysgol yn ymddiried ynddynt i wneud eu gwaith a bod hyblygrwydd ac ymreolaeth yn bethau yn agweddau da am weithio yn y Brifysgol. Gyda’r cysyniad newydd o weithio deinamig gall cydweithwyr gadw ymdeimlad o ymreolaeth trwy
barhau i fod yn hyblyg yn ystod yr wythnos waith. Mae’r Brifysgol yn bwriadu canolbwyntio ar ymgysylltu
â staff a fydd yn helpu rheolwyr ac arweinwyr i edrych ar welliannau trwy lens y gweithiwr yn hytrach na’r cyflogwr yn unig.

Yn hollbwysig i’r gwaith hwn ac i iechyd a lles staff, yn ystod 2021-22 cyhoeddwyd Strategaeth Iechyd a Lles newydd y Brifysgol.
Ar ôl ymgynghori â dros 50 o aelodau staff mewn chwe grŵp ffocws, nodwyd meysydd a fyddai’n elwa o gael cefnogaeth ychwanegol. Darparwyd rhagor o hyfforddiant i-act i staff. Hyfforddiant yw hwn sy’n seiliedig ar dystiolaeth ac wedi’i achredu gan Goleg Brenhinol y Seiciatryddion. Cymerodd 123 o staff, gan gynnwys aelodau’r Bwrdd Gweithredol, ran yn yr hyfforddiant hwn sy’n rhoi arweiniad ymarferol i bobl i’w helpu i ddeall a rheoli iechyd meddwl a lles yn y gweithle.
Penodwyd staff iechyd a lles penodol hefyd i gefnogi’r ymdrechion i roi’r strategaeth ar waith ar gyfer staff a myfyrwyr gan gynnwys sefydlu hyrwyddwyr lles staff ym mhob adran ac Ysgol, a hyfforddi hyfforddwyr i-act yn fewnol i barhau â’r gwaith o gyflwyno gweithdai rheoli lles yn y gweithle.
Yn 2021-22 cynigiwyd hyfforddiant i wyliedyddion i bob myfyriwr yn y flwyddyn gyntaf ym Mangor i gefnogi cymuned gynhwysol. Cafodd modiwl i helpu myfyrwyr i ddatblygu gwytnwch ei dreialu’n llwyddiannus yn yr Ysgol Gwyddorau Dynol ac Ymddygiadol ac mae’r Brifysgol yn bwriadu sicrhau bod hwn ar gael yn ehangach yn y dyfodol.
Mae Strategaeth Ystadau’r Brifysgol - 2030+ lle, pwrpas a chymuned - yn cydnabod y bydd angen i ffurf ffisegol y sefydliad gefnogi ein cyfeiriad strategol am flynyddoedd lawer, gan greu campysau hyblyg ac ystwyth i ymateb i anghenion a heriau strategol cyfnewidiol.
Nod y strategaeth a ddatblygwyd yn 2021-22 yw sicrhau buddion i staff, myfyrwyr a’r gymuned ehangach gyda ffocws ar gyflawni’n effeithiol y pum C mewn perthynas â’r ystad, sef cydgrynhoi, cydlynu, cydleoli, cyd-ddibynnu a chyfathrebu.
Roedd ansicrwydd sylweddol oherwydd pandemig Covid-19 ond gyda’r rheolau’n newid a phethau’n dychwelyd yn raddol i normalrwydd, addasodd y Brifysgol yn gyflym i ofynion staff a myfyrwyr.
Mae Adeilad Deiniol, sy’n gartref i dîm Gwasanaethau Digidol y Brifysgol yn cael ei ddatblygu gyda chymorth cyllidol gan HEFCW i fod yn ganolbwynt addysgu hyblyg wedi’i alluogi’n ddigidol i wasanaethu’r Campws Gwyddoniaeth a’r Brifysgol yn ei chyfanrwydd. Dwy brif elfen i’r project yw creu switiau mawr y gellir eu harchebu ar gyfer addysgu gyda chyfrifiaduron gyda lle i 200 o weithfannau, a chanolfan addysgu a dysgu hyblyg ar gyfer addysgu pan na ddefnyddir cyfrifiaduron ond bod yno well isadeiledd digidol a lle i 200 o fyfyrwyr.
Cwblhawyd y gwaith o adnewyddu’r Canolbwynt Gweithgareddau Myfyrwyr yn Adeilad Ffriddoedd ym mis Medi 2021. Llwyddodd hyn i adfywio’r gofod ac ailfodelu ardal ar gyfer clybiau a chymdeithasau Undeb y Myfyrwyr.
Ym mis Mawrth 2022, dyfarnodd HEFCW £3.2m o gyllid grant cyfalaf ychwanegol, a dyrannwyd £2m ohono ar gyfer gwaith sy’n gysylltiedig â chynnal a chadw, offer a datblygiadau eraill sy’n cefnogi strategaeth cynaliadwyedd y Brifysgol a’r ymrwymiad i’r targed sero net.

Mae cwadrangl allanol Prif Adeilad y Celfyddydau yn cael ei dirlunio fel rhan o gynllun tir cyhoeddus gwerth £1.5m i ddarparu ardal bleserus a thawel i gerddwyr trwy gael gwared ar gerbydau a darparu seddi, planhigion a goleuo.
Mae’r weledigaeth gyffrous ar gyfer adfywio Parc Coleg a’i wneud yn lle croesawgar, gyda chefnogaeth Cyngor Gwynedd a chynllun Trawsnewid Trefi Llywodraeth Cymru, yn dwyn ffrwyth, gan drawsnewid y man gwyrdd amlwg hwn yng nghanol y ddinas yn lle bywiog a chyffrous o addysg a mwynhad i’r gymuned ehangach. Mae’r gwaith yn cynnwys creu gofod i gyflwyno gweithgareddau newydd, gwelliannau i lwybrau, dod â golygfeydd i’r amlwg, annog coed i dyfu gwell a gwella bioamrywiaeth yn yr ardal.
Yn sgil y rhyfel yn Wcráin, cynigiodd y Brifysgol gefnogi Llywodraeth Cymru ac fel rhan o’r cynllun uwchnoddwr cafodd un o’n neuaddau preswyl ei ail-bwrpasu yn Ebrill 2022. Gan weithio mewn partneriaeth â Chyngor Gwynedd, Llywodraeth Cymru, Bwrdd Iechyd Prifysgol Betsi Cadwaladr a Clwyd Alyn, sef darparwr tai cymdeithasol lleol, mae mwy nag 80 o ffoaduriaid o Wcráin wedi cael cynnig noddfa ym Mangor.
Mae Gardd Fotaneg Treborth yn hyrwyddo cadwraeth, defnydd cynaliadwy a mwynhad o blanhigion a byd natur drwy addysg, ymchwil, hyfforddiant ac ymwneud â’r gymuned.
Mae bygythiadau newid hinsawdd a cholli bioamrywiaeth planhigion yn fyd-eang o ran maint ac effaith, ac mae cynefinoedd morol a daearol yr ardd, ei chasgliadau brodorol ac egsotig, labordai ar y ddaear ac o dan y ddaear, dynodiad gwarchodfa natur a statws hamdden cyhoeddus, yn cynnig microcosm lleol perffaith i astudio prosesau amgylcheddol a lledaenu dysgu ar gyfer dyfodol cynaliadwy.

Mae gardd fotaneg yn cynnwys llawer mwy na’i phlanhigion. Mae Treborth yn gweithredu fwyfwy fel man cyfarfod ar gyfer y gwyddorau naturiol a gwyddorau cymdeithas, at ddibenion addysg ffurfiol ac anffurfiol, a gweithgareddau allymestyn i gymunedau. Wrth i’r byd newid, bydd yr ardd yn addasu i heriau newydd mewn ffyrdd dychmygus a chyffrous sy’n cyfrannu at ddatrys problemau cadwraeth amgylcheddol a rheoli adnoddau naturiol.
Gydag arian gan Gyfeillion Treborth ynghyd â chyllideb cynnal a chadw’r ystâd llwyddwyd i godi gweithdy ac adeilad addysg newydd i gefnogi mynediad i’r
gerddi. Dyfarnwyd £10,000 i’r ardd gan HEFCW drwy’r gronfa Iechyd a Lles sy’n cefnogi sesiynau ioga ac ymwybyddiaeth ofalgar rheolaidd, gweithgareddau byw yn y gwyllt yn Ysgol y Goedwig a theithiau cerdded llesol i fyfyrwyr drwy’r coetir ac i lawr at ymyl y dŵr. Mae hefyd wedi ariannu estyniad i’n project gazebo derw, dan arweiniad Elfennau Gwyllt.
Mae gan Gyfeillion Gardd Fotaneg Treborth aelodaeth o dros 400 o bobl gyda thîm gwirfoddoli craidd o dros 40, a ddarparodd 8,500 o oriau o waith yn 2021-22, gan gynnwys garddio ymarferol, cyfrannu at gynllunio strategol a chynllunio’r ardd, rheoli’r cofnodion planhigion, archifo a rheoli’r llyfrgell a’i chronfa ddata, cynghori staff, gwneud ceisiadau am grantiau, cefnogi’r aelodau trwy gynhyrchu cylchlythyr deirgwaith y flwyddyn, trefnu digwyddiadau gwerthu planhigion a digwyddiadau eraill, a thyfu planhigion gartref.
Cynhaliodd yr ardd hefyd bedair interniaeth i fyfyrwyr a lleoliad blwyddyn i fyfyriwr mewn cydweithrediad
â Gwobr Cyflogadwyedd Bangor. Eleni ymunodd y myfyrwyr â’r tîm i gynorthwyo gyda thasgau garddio pob dydd, cynlluniau gweithredu bioamrywiaeth ar gyfer y brifysgol, a chatalogio ein casgliad cigysol sy’n tyfu’n barhaus.
Mae adeiladu seilwaith y gellir ei ddefnyddio’n hyblyg, yn awr ac yn y dyfodol, yn un o amcanion allweddol strategaeth ystadau’r Brifysgol. Mae ein dull hefyd yn cydnabod y gall dylunio arloesol a defnyddio atebion dodrefn modern gael effaith sylweddol ar y defnydd o le a sut y gellir ei ffurfweddu, gan greu mannau magnetig a gludiog a fydd yn denu staff a myfyrwyr a gwella eu profiad a’u mwynhad.
Mae Pontio, sef Canolfan Gelfyddydau arloesol a llawn steil Prifysgol Bangor wedi dod yn ganolbwynt ar gyfer ystod eang o ddysgu ffurfiol ac anffurfiol yn ogystal â’i rôl fel canolfan gyhoeddus i’r celfyddydau ac i ddiwylliant. Fel adeilad modern, eang ac agored, gwnaed gwelliannau arloesol i’r ased arbennig hwn er mwyn uchafu ei fuddion i ddefnyddwyr ac ymwelwyr.
Yn ogystal, yn dilyn yr aflonyddwch a achoswyd gan Covid-19 mae ail-gysylltu â chynulleidfaoedd trwy ddigwyddiadau byw a gweithgaredd cyfranogol wyneb yn wyneb wedi bod yn ffocws i Pontio a, chan ddangos bod galw, o agor y drysau unwaith eto gwerthwyd 35,434 o docynnau i 379 o ddigwyddiadau, ynghyd â 1067 o ddangosiadau yn y sinema yn 2021-22.
Mae Pontio wedi cynnal nifer o brojectau, digwyddiadau a mentrau ymgysylltu cymunedol llwyddiannus, gan gynnwys lansio’r Ŵyl Goncrit, sef rhaglen yn cynnwys amrywiaeth o berfformiadau awyr agored o feysydd dawns, theatr gerdd, cerddoriaeth gyfoes, cerddoriaeth glasurol, theatr a gweithgaredd cyfranogol.
Project a ddaeth i fod yn ystod y cyfnod clo oedd y project Cartref a Chynefin. Gyda chyllid gan HEFCW, roedd hwn yn broject ar y cyd rhwng canolfannau y celfyddydau Prifysgol Bangor, Prifysgol Aberystwyth
a Phrifysgol Abertawe. Bu project unigryw yn cynnwys myfyrwyr, artistiaid a grwpiau cymunedol yn cydweithio mewn perfformiad teimladwy a phwerus iawn yn Theatr Bryn Terfel Prifysgol Bangor. Cyflogwyd 150 o fyfyrwyr ar y project gan roi profiad gwerthfawr o ymarfer proffesiynol iddynt.

Mae BLAS, ein project cyfranogol craidd dan arweiniad Mared Huws ynghyd â’r dosbarthiadau theatr rheolaidd wedi arwain at nifer o brojectau cyffrous. Dau uchafbwynt oedd project clwb llyfrau gyda Chymdeithas Gogledd Cymru Affrica, a phroject parhaus gyda Phobl i Bobl Bangor, sy’n gweithio gyda ffoaduriaid sy’n cael eu hailgartrefu ym Mangor o Wcráin, Afghanistan, Yemen a Syria. Mae projectau eraill yn cynnwys Dance for Parkinson’s, project gyda Chwmni Dawns Cenedlaethol Cymru a’r English National Ballet sy’n darparu dosbarthiadau dawns i bobl sy’n byw gyda dementia.
Ar lwyfannau Pontio, cafwyd llawer o uchafbwyntiau, gan gynnwys Gŵyl Undod Hijinx a gyflwynodd waith gan artistiaid ag anableddau dysgu, a sefydliadau celfyddydol cenedlaethol Cymru gan gynnwys Theatr Genedlaethol Cymru, National Theatre Wales, Ballet Cymru, Opera Cenedlaethol Cymru a Chwmni Dawns Cenedlaethol Cymru. Bu talentau lleol hefyd yn rhannu’r llwyfan gan gynnwys cyngerdd pen-blwydd Côr Seiriol, Academi’r West End o Fangor, Showzone Maes-G a Choleg Menai.
Mae Pontio yn alinio ei weithgarwch â Deddf Llesiant Cenedlaethau’r Dyfodol Llywodraeth Cymru. Mae darparu llawenydd a chwerthin yn rhan hanfodol o hyn ac mae comedi wedi bod yn rhan amlwg o’n rhaglen ers y pandemig, gyda Kiri Prichard-McLean, Nish Kumar ac Ed Byrne i gyd yn perfformio yn Pontio. Dychwelodd cynulleidfa’r sinema yn raddol hefyd, gyda chyfuniad o ffilmiau poblogaidd masnachol a ffilmiau annibynnol ac artistig, ochr yn ochr â sgyrsiau a thrafodaethau panel.
Mae Strategaeth y Gymraeg y Brifysgol yn dweud fod i’r Gymraeg le canolog ym mhob agwedd ar waith y sefydliad ac y gall staff a myfyrwyr ddewis manteisio ar ddysgu a gweithio mewn amgylchedd Cymraeg a dwyieithog, a mwynhau’r cyfle hwnnw.
Trwy ein hymrwymiad parhaus i’r Gymraeg ac i ddwyieithrwydd o fewn y sefydliad, mae Prifysgol Bangor yn chwarae rhan bwysig trwy gyfrannu at dwf y Gymraeg yn gymdeithasol, yn ddiwylliannol ac yn economaidd, gan gyfrannu’r arwyddocaol at ymdrech y Llywodraeth i annog a chefnogi unigolion sy’n barod i ddefnyddio’r Gymraeg yn eu bywydau bob dydd.
Mae gan 72% o weithlu’r Brifysgol a bron i chwarter ein myfyrwyr sgiliau Cymraeg. Yn ystod 2021-22, adroddodd Canolfan Bedwyr gynnydd o 63% yn nifer y staff sy’n dysgu Cymraeg ac enillodd 40 o fyfyrwyr y dystysgrif Sgiliau Iaith. Enillodd Dr Eirini Sanoudaki ragoriaeth. Uwch Ddarlithydd mewn Ieithyddiaeth yw Eirini a hi yw Cyfarwyddwr Materion y Gymraeg yn yr Ysgol Iaith, Diwylliant a’r Celfyddydau. Yn wreiddiol o Wlad Groeg, dywedodd bod y diolch am ei llwyddiant i waith ei thiwtoriaid Cymraeg a’r awyrgylch ddwyieithog gyfoethog a geir yn y Brifysgol.

Penodwyd y Brifysgol i roi cyngor arbenigol i gefnogi Llywodraeth Cymru ar ei strategaeth Cymraeg 2050 - Miliwn o Siaradwyr. Fel rhan o’r broses dendro, roedd cyfle i’r Brifysgol gyflwyno ceisiadau am waith ymgynghorol mewn sawl maes gwahanol, gan gynnwys y Gymraeg mewn addysg ac yn y gweithle ac yn y gymdeithas ehangach, yn ogystal â meysydd mwy penodol megis y defnydd o’r iaith gan bobl ifanc, dylunio ymyriadau newid ymddygiad, technoleg iaith a datblygu corpws. Roedd pob un o’r ceisiadau hyn yn llwyddiannus.
Y ddarpariaeth Cymraeg i Oedolion ym Mangor -
Dysgu Cymraeg y Gogledd Orllewin (DCGO) – cawsant sgôr rhagorol gan Estyn, yr arolygiaeth addysg a hyfforddiant yng Nghymru, a nododd fod gan y Brifysgol “weledigaeth glir a chryf iawn ar gyfer darparu gwasanaeth o ansawdd uchel” a’i bod yn “canolbwyntio ar sicrhau profiadau dysgu cyfoethog er mwyn cefnogi cynnydd dysgwyr ”.
Mae Prifysgol Bangor hefyd yn rhan o broject arloesol sy’n cael ei arwain gan y Coleg Cymraeg Cenedlaethol i greu dros 130 o unedau dysgu digidol newydd i gefnogi myfyrwyr ledled Cymru sy’n astudio drwy gyfrwng y Gymraeg. Mae’r project wedi creu adnoddau arbenigol ac unigryw i ddysgu nifer o bynciau poblogaidd trwy gyfrwng y Gymraeg, o Wyddorau Chwaraeon i Wyddorau Cymdeithas. Mae’r adnoddau’n darparu pecynnau dysgu y gall myfyrwyr eu cyrchu ar unrhyw adeg, gan gynnwys darlithoedd fideo o’r ansawdd uchaf, pecynnau darllen a chynnwys rhyngweithiol i fyfyrwyr Cymraeg eu hiaith eu defnyddio, ble bynnag y bônt yn astudio yng Nghymru.
Roedd tîm cyfieithu’r Brifysgol yng Nghanolfan Bedwyr wedi rhagweld y byddai natur cyfarfodydd yn newid pan ddeuai’r cyfyngiadau Covid-19 i ben a bu iddynt ddyfeisio a chomisiynu teclyn cyfieithu ar y pryd digidol a fyddai’n gweithio gyda’r llwyfan Zoom i hwyluso cyfieithu mewn cyfarfodydd hybrid lle mae rhai pobl yn bresennol yn y cyfarfod ac eraill yn gweithio o bell.
Y Brifysgol yw’r sefydliad cyntaf yng Nghymru i allu cynnig datrysiad mor integredig ac mae Comisiynydd y Gymraeg wedi cyhoeddi astudiaeth achos yn disgrifio’r dull arloesol hwn er mwyn rhannu arfer gorau.
Ein huchelgais yw i’r Gymraeg fod â lle ym mhob agwedd ar waith y Brifysgol ac y gall staff a myfyrwyr ddewis manteisio ar ddysgu a gweithio mewn amgylchedd Cymraeg a dwyieithog, a mwynhau’r cyfle hwnnw.
Ar ôl gweld bod prinder adnoddau iechyd meddwl a lles ar gael i fyfyrwyr trwy gyfrwng y Gymraeg, lansiodd Prifysgol Bangor mewn partneriaeth â Grŵp Llandrillo Menai, Prifysgol Aberystwyth a Phrifysgol Cymru Y Drindod Dewi Sant myf. cymru gyda chyllid gan Gyngor Cyllido Addysg Uwch Cymru (HEFCW).
Mae’r adnodd iechyd meddwl a lles hwn wedi’i anelu at fyfyrwyr addysg uwch Cymraeg eu hiaith sy’n astudio yng Nghymru a thu hwnt ac mae’n darparu gwybodaeth am gyflyrau iechyd meddwl ac awgrymiadau ynglŷn ag iechyd a lles.
Dathlodd y Coleg Cymraeg Cenedlaethol ei ben-blwydd yn 10 oed a chynnal gwobrau i wobrwyo rhai o’r myfyrwyr a’r darlithwyr mwyaf disglair o Gymru a wnaeth gyfraniad sylweddol i addysg ôl-orfodol Cymraeg a dwyieithog yn 2021-22.
Dyfarnwyd y wobr Cyfraniad Eithriadol i addysg cyfrwng Cymraeg sy’n rhoi cydnabyddiaeth i unigolyn am wneud cyfraniad eithriadol i addysg uwch y tu hwnt i’w rôl broffesiynol i Dr Gwenan Prysor, sy’n Uwch Ddarlithydd mewn Gwaith Cymdeithasol am arwain cwrs MA Gwaith Cymdeithasol Bangor sy’n cael ei gyflwyno 100% drwy gyfrwng y Gymraeg, ac am ei gwaith yn cefnogi myfyrwyr a gweithwyr i ddysgu am bwysigrwydd y Gymraeg o fewn gwaith cymdeithasol.

Gan adlewyrchu uchelgais a gweledigaeth Strategaeth 2030 y Brifysgol, mae ein Strategaeth Cenhadaeth Ddinesig a ddatblygwyd yn 2021-22 yn nodi ein hymrwymiad i ymgysylltu dinesig a chymunedol.
Cyn pandemig Covid-19, roedd prifysgolion wedi cael eu herio gan lunwyr polisi i feddwl mewn ffordd wahanol am sut roeddent yn rhyngweithio â’u cymunedau lleol, rhanbarthol a rhyngwladol. Wrth wraidd y gofyniad hwnnw roedd galw ar brifysgolion i ddarparu gwerth ychwanegol i grwpiau craidd o randdeiliaid allanol a meddwl yn wahanol am ymgysylltu cymunedol.
Mae Prifysgol Bangor yn gwneud cyfraniad sylweddol i fywyd ein cymunedau lleol. Mae’r gwaith a wnaed i sicrhau bod y campws ar gael ar gyfer yr ymdrechion i drin, profi ac atal Covid-19, yr ymchwil a helpodd i ddeall a mynd i’r afael â’r heriau a achosir gan y firws, ymdrechion staff a myfyrwyr i gefnogi grwpiau mewn perygl yn ystod y cyfnodau clo a darparu cefnogaeth i ffoaduriaid o Wcráin yn enghreifftiau o’r ffyrdd y dangosodd y Brifysgol ei bod yn bartner cymunedol effeithiol ac yn arweinydd syniadaeth.
Cynrychiolir amcanion craidd y strategaeth newydd gan dair thema ‘ymbarél’:
Gweithio gyda rhanddeiliaid i nodi a mynd i’r afael
â ‘heriau mawr’ gan gynnwys iechyd, yr hinsawdd, y Gymraeg, tai, tlodi, yr adferiad ôl-Covid, poblogaeth sy’n heneiddio;
Gweithio gyda rhanddeiliaid i sicrhau twf economaidd a chynaliadwyedd e.e., datblygu ein dealltwriaeth o anghenion sgiliau a chyflogaeth a defnyddio partneriaethau i ddeall y ffyrdd mwyaf effeithiol o gyrraedd cymunedau i helpu i gyflwyno darpariaeth addysgiadol a sgiliau;
Gwella ansawdd bywyd a gwybodaeth trwy ymgysylltu cymdeithasol a chyhoeddus e.e., trwy ein mentrau celfyddydol, chwaraeon a lles gan gynnwys Pontio, Canolfan Brailsford, Gardd Fotaneg Treborth ac ailddatblygu Parc y Coleg.
Mae camau cadarnhaol wedi’u cymryd i sicrhau y gallwn ymateb yn fwy effeithiol i’r heriau a’r cyfleoedd sy’n ein hwynebu dros y degawd nesaf drwy greu Bwrdd Cymunedol sy’n dwyn ynghyd ystod eang o randdeiliaid o’r sectorau cyhoeddus, preifat a gwirfoddol a fydd yn cefnogi’r strategaeth drwy nodi cyfleoedd i gydweithio a darparu adborth ar ein gwaith ymgysylltu dinesig.
Mae tîm Cenhadaeth Ddinesig wedi’i sefydlu yn y Brifysgol a’i rôl yw cyflawni ein strategaeth cenhadaeth ddinesig, gan gynnwys nodi cyfleoedd i gydweithio, datblygu modelau o weithio mewn partneriaeth ac ymestyn cyrhaeddiad ein hôl troed cymunedol ar draws Gogledd Cymru.
Mae’r Sefydliad Materion Cymreig a Phrifysgol Bangor wedi creu partneriaeth i gyflwyno cyfres o ddigwyddiadau rhithiol, yn y cnawd neu hybrid sydd wedi’u cynllunio i gyfrannu at ddylanwadu ar yr agenda polisi cyhoeddus ar draws ystod o faterion, gan gynnwys: Canfyddiadau a gwirioneddau am ranbarth Gogledd Cymru a’i berthynas gymdeithasol, economaidd a gwleidyddol a gweddill y wlad a thu hwnt; y ffin hydraidd rhwng Gogledd-ddwyrain Cymru a Gogledd-orllewin Lloegr, a’r hyn y mae’n ei olygu o ran mudiad poblogaethau; a buddsoddi, arloesi, agenda Codi’r Gwastad a chynghreiriau a fodolai cyn datganoli.
Yn ystod lansiad y bartneriaeth hon ym mis Mawrth 2022 cafwyd trafodaeth ar-lein yn dwyn y teitl Taxing Twilight: the Health Economics of North Wales lle gofynnwyd i’r panelwyr drafod sut y dylem fynd i’r afael â phwysau mewn amgylchedd lle mae cyfran y boblogaeth o oedran gweithio yn lleihau, gan ddeall ar yr un pryd yr heriau presennol a ddaw yn sgil natur wledig yr ardal ac yn y pen draw yr angen i ddarparu’r gwasanaethau gorau y mae Gogledd Cymru yn haeddu eu cael.
Ym mis Gorffennaf 2022, dathlodd mwy na 5,000 o fyfyrwyr o dair blynedd academaidd eu llwyddiannau gyda’u teuluoedd a’u ffrindiau. Yn ystod gŵyl dair wythnos o seremonïau graddio, rhoddodd y Brifysgol hefyd 15 gradd er anrhydedd i unigolion nodedig sydd wedi gwneud cyfraniadau eithriadol i gymdeithas.

Am ei wasanaeth i adloniant poblogaidd a’i gyfraniad at ddysgu trwy bob cyfrwng:
Mae Tudur Owen yn enw cyfarwydd yng Nghymru ac yn ddigrifwr sydd wedi ennill gwobr BAFTA. Mae’n cyfuno agwedd ddarostyngedig a Chymreigaidd gydag arddull hwyliog sy’n codi’r galon. Mae gan Tudur ddawn i ddenu cynulleidfaoedd newydd, yn enwedig y bobl hynny na fyddai fel arfer yn gwylio nac yn gwrando ar raglenni Cymraeg, gan ehangu mynediad at y Gymraeg.
Dyn camera bywyd gwyllt o Swdan yw Hamza Yassin. Mae’n adnabyddus am ei waith ar raglen Countryfile y BBC. Mae ganddo radd mewn Swoleg gyda Chadwraeth o Brifysgol Bangor ac ers hynny mae wedi creu gyrfa ym maes ffilmiau bywyd gwyllt a’r hyn sy’n ei ysbrydoli yw Gogledd Cymru a’r Alban.
Am gyfraniad at y Gymraeg a Diwylliant, Cerddoriaeth a’r Celfyddydau yng
Nghymru:
Am ysgolheictod ac arloesi eithriadol:
Mae’r Arglwydd John Krebs FRS yn sŵolegydd nodedig. Graddiodd o Goleg Penfro, Rhydychen cyn dal swyddi ym Mhrifysgol British Columbia a Choleg Prifysgol Gogledd Cymru, Bangor. Etholwyd yn Gymrawd y Gymdeithas Frenhinol yn 1984. Ef oedd Prif Weithredwr Cyngor Ymchwil yr Amgylchedd Naturiol rhwng 1994 a 1999 a chafodd ei urddo’n farchog ym 1999.

Am wasanaeth cyhoeddus, gan gynnwys iechyd:
Mae Arfon Jones wedi cyfrannu at ddiwylliant crefyddol yng Nghymru, yn bennaf wrth gynhyrchu testun dealladwy ac academaidd gyfrifol o’r Beibl Cymraeg sy’n gweddu i ddiwylliant cyfoes. Graddiodd Arfon o Brifysgol Bangor, a dechreuodd gyfieithu’r Ysgrythur i Gymraeg a fyddai’n ddealladwy i ddysgwyr ifanc yn y 1990au. DJ Cymreig a chynhyrchydd recordiau yw Sasha. Mae’n fwyaf adnabyddus am ei ddigwyddiadau byw ac am gerddoriaeth electronig fel artist unigol yn ogystal â’i brojectau cydweithio fel Sasha a John Digweed. Daeth i’r brig fel DJ gorau’r byd mewn arolwg barn a gynhaliwyd gan DJ Magazine ac mae wedi ennill pedair gwobr yng ngwobrau’r International Dance Music Awards ac wedi ei enwebu am wobr Grammy. Menai Williams yw un o diwtoriaid, cyfansoddwyr a beirniaid cerdd mwyaf blaenllaw Cymru, ac un o raddedigion Prifysgol Bangor. Bu’n delynores ac yn feirniad yn yr Eisteddfod Genedlaethol ers dros 40 mlynedd. Mae Menai wedi cyfansoddi nifer o geinciau cerdd dant a ddefnyddir mewn digwyddiadau cenedlaethol ledled Cymru.
Am wasanaeth i fusnes ac entrepreneuriaeth:
Simon Gibson CBE yw Cadeirydd Sefydliad Entrepreneuriaeth Graddedigion
Alacrity a Phrif Weithredwr Wesley Clover Wales. Mae’n gadeirydd ar sawl cwmni technoleg ac yn Gyfarwyddwr anweithredol y Celtic Manor Resort. Mae ganddo hanes hir o gynghori cyrff cyhoeddus ac ef yw Cadeirydd Panel Cynghori 5G Cymru ac mae’n Ymddiriedolwr Sefydliad Elusennol Newbridge.
Nigel Short yw cyfarwyddwr Wisgi Penderyn ac mae wedi dal sawl swydd gan gynnwys Cadeirydd Gweithredol ers lansio’r cwmni’n swyddogol yn 2004. Treuliodd

Nigel 25 mlynedd yn gweithio yn y diwydiant dur gan gyflogi 1,500 o bobl mewn chwe gwlad wahanol, gan ddefnyddio logisteg soffistigedig ar y safleoedd.
Dr Debbie Williams yw cyd-sylfaenydd y wefan cymharu prisiau, confused.com. Mae ganddi brofiad masnachol eang yn cynnwys arweinyddiaeth, e-fasnach a mentora, ar ôl dal swyddi gweithredol ac anweithredol mewn cwmnïau gan gynnwys yr Admiral Group, Banc Tesco a Rygbi’r Gweilch. Mae Debbie yn dal swyddi lefel bwrdd gyda Gyrfa Cymru, Cymdeithas Adeiladu’r Principality a Chomisiwn Democratiaeth Cymru.

Roedd Y Gwir Anrhydeddus Robert Buckland QC yn Arglwydd Ganghellor ac yn Ysgrifennydd Gwladol dros Gyfiawnder rhwng 2019 a 2021 ac yn Ysgrifennydd Gwladol Cymru yn 2022. Cafodd ei eni yn Llanelli ym 1968 a mynychodd Ysgol y Gyfraith Ysbytai’r Brawdlys lle enillodd wobr am Eiriolaeth.

Graddiodd Dr Rebecca Heaton gyda gradd dosbarth cyntaf mewn Coedwigaeth o Brifysgol Bangor yn 1993 ac aeth ymlaen i gwblhau PhD ar dyfu ac economeg cnydau ynni ym Mhrifysgol Caerdydd yn 2000, cyn mynd ymlaen i wneud ymchwil ôl-ddoethurol a gyfrannodd tuag at fewnbwn y Deyrnas Unedig i Brotocol Kyoto fel rhan o Gonfensiwn Fframwaith y Cenhedloedd Unedig ar Newid yn yr Hinsawdd. Mae hi’n arweinydd o ran ein hymateb i’r argyfwng hinsawdd.




Graddiodd Zaha Waheed gyda BSc mewn Bioleg Môr ac Eigioneg ym Mhrifysgol Bangor ym 1996. Mae hi’n Weinidog yn Swyddfa’r Llywydd yn y Maldives. Mae wedi gwneud cyfraniadau gwerthfawr iawn i’r Maldives mewn meysydd pysgodfeydd, gwyddor y môr a rheoli trychinebau, gan gynnwys sefydlu llwyfan cenedlaethol ar gyfer lleihau risg trychinebau a gwella rhaglenni rheoli risg trychinebau yn y gymuned. Actores, digrifwraig, awdures, personoliaeth deledu ac ymgyrchydd iechyd meddwl yw’r Americanes-Brydeinig Ruby Wax OBE sydd â chysylltiadau ymchwil ac addysgu â’r Ysgol Gwyddorau Dynol ac Ymddygiadol ym Mhrifysgol Bangor ac, yn arbennig felly, â Chanolfan Ymchwil ac Ymarfer Ymwybyddiaeth Ofalgar y Brifysgol.


Am wasanaeth i addysg:
Simon Thompson yw Prif Weithredwr Sefydliad y Bancwyr Siartredig sy’n gweithio mewn partneriaeth â Phrifysgol Bangor i gyflwyno ein cwrs MBA Banciwr Siartredig, yr unig gymhwyster bancio yn y byd sy’n cyfuno MBA a statws Banciwr Siartredig. Lansiodd gronfa ysgoloriaeth gwerth £1m - Sefydliad 2025 - i gefnogi pobl ifanc o gefndiroedd difreintiedig sy’n ceisio ymuno â’r proffesiwn bancio.





Am lwyddiant ym myd y campau:
Rachel Taylor yw hyfforddwr perfformio Clwb Rygbi Sale Sharks. Hi yw’r unig chwaraewr a fu’n gapten ar dimau rhyngwladol 7 bob ochr a 15 bob ochr Cymru ac a chwaraeodd i bob rhanbarth yng Nghymru, ac mewn tri Chwpan Byd. Cafodd Rachel 67 o gapiau dros Gymru ac mae’n ferch sy’n ysbrydoli ym maes chwaraeon ac yn llysgennad dros rygbi merched.
Yn ystod 2021-22, dathlodd y Brifysgol 100 mlynedd ers penodi ET Davies fel y Cyfarwyddwr Cerdd llawn amser cyntaf. Roedd y dathliadau’n cynnwys cyngherddau, perfformiadau, dosbarthiadau meistr a sgyrsiau – oll yn talu teyrnged i’r traddodiad hir o greu cerddoriaeth ym Mangor.

Crëwyd meicrosafle arbennig fel rhan o’r brif wefan i rannu hanes cerddorol y Brifysgol, atgofion cynfyfyrwyr a digwyddiadau. Cafodd talent Adran Cerdd, Drama a Pherfformio Prifysgol Bangor ei arddangos mewn cyngherddau gan Gerddorfa Symffoni’r Brifysgol a Chorws y Brifysgol gyda gwesteion arbennig, a oedd yn cynnwys cerddoriaeth a gyfansoddwyd rhwng 1921-2022 ymysg y darnau a berfformiwyd.

Roedd Neuadd Prichard-Jones dan ei sang ym mis Ebrill 2022 ar gyfer y cyngerdd dathlu. Roedd rhywfaint
o gyn-fyfyrwyr wedi teithio i Fangor yn arbennig i ymuno â’r gerddorfa a’r corws ynghyd â myfyrwyr presennol, staff ac aelodau o’r gymuned. Cyflwynwyd symudiad o 5ed Symffoni Beethoven gan arweinydd a Chyfarwyddwr Cerdd y Brifysgol, Gwyn L Williams, a chan gerddorfa’r Brifysgol fel ‘symbol cerddorol o egni a herfeiddiad i’r bobl sydd dan warchae yn Wcráin’.
Gwnaed cyflwyniad i John Hywel, cyn-ddarlithydd a Phennaeth yr Adran Cerddoriaeth am ei gyfraniad arbennig i gerddoriaeth yn y Brifysgol. Yna synnodd y gynulleidfa trwy arwain yr Ave Verum Corpus gan Mozart.
Parhaodd dathliadau Cerddoriaeth 100 yn yr Eisteddfod Genedlaethol gyda rhaglen o ddigwyddiadau i nodi’r pen-blwydd. Ymunodd Menai Williams, sy’n dderbynnydd gradd er anrhydedd, â Dr Guto Puw i drafod ei bywyd ym myd cerddoriaeth a chynhaliodd Stephen Rees, sy’n ddarlithydd mewn cerddoleg, drafodaeth banel ar ddyfodol addysg cerddoriaeth. Cafodd Eisteddfodwyr hefyd y pleser o wrando ar berfformiadau gan y delynores Gwenan Gibbard a’r canwr a’r cerddor Osian Huw Williams, y ddau yn gyn-fyfyrwyr o Fangor sydd wedi gwneud cyfraniad enfawr i gerddoriaeth Cymru.

Mae prifysgolion yn chwarae rhan bwysig yn hyrwyddo’r agenda cydraddoldeb yng Nghymru. Rydym wedi ymrwymo’n llwyr i’n cyfrifoldebau i gyflawni dyletswyddau cyffredinol Deddf Cydraddoldeb 2010 a’r dyletswyddau penodol i Gymru. Yn benodol, mae’r Brifysgol hefyd wedi ymrwymo i’r amcanion a amlinellir yn Neddf Llesiant Cenedlaethau’r Dyfodol (2015). Rydym yn ystyried bod ein hymrwymiad i gydraddoldeb a chynhwysiant yn allweddol i’n cynaliadwyedd a’n llwyddiant hirdymor.
Mae Prifysgol Bangor yn parhau i gefnogi a hyrwyddo cydraddoldeb, amrywiaeth a chynhwysiant ar draws y brifysgol a’i gweithgareddau. Er mwyn gwneud hyn rydym wedi gweithio’n agos gyda staff a myfyrwyr i gefnogi ein cymuned amrywiol i ddarparu profiad rhagorol i fyfyrwyr ac i ddarparu addysgu ac ymchwil rhagorol.
Mae Prifysgol Bangor yn cydnabod pwysigrwydd tegwch a thryloywder yn ei strwythurau cyflog gan sicrhau bod staff yn cael eu gwobrwyo’n deg am y gwaith a wnânt a sicrhau cyflog cyfartal am waith o werth cyfartal.
Fframwaith Deddfwriaethol
Mae’r brifysgol wedi ei hymgorffori drwy Siarter Frenhinol, a roddwyd gyntaf iddi yn 1885, ac sydd wedi cael ei hailysgrifennu a’i diwygio ar sawl achlysur yn dilyn hynny. Mae’r Siarter (a’r Statudau a’r Ordinhadau ategol) yn gosod fframwaith bras i strwythur cyfreithiol a dull llywodraethu’r Brifysgol.
O dan y Siarter a’r Statudau, y Cyngor yw corff llywodraethu’r Brifysgol. Ar hyn o bryd mae ynddo 20 o aelodau, y mwyafrif ohonynt yn aelodau annibynnol.
Wrth bennu cyflog a thâl ei holl weithwyr, bydd y brifysgol yn cydymffurfio â’r holl ddeddfwriaeth gyflogaeth berthnasol.
Strwythur cyflog a gwneud penderfyniadau
Cafodd Cytundeb Fframwaith Cenedlaethol ei negodi yn 2004 gan Gymdeithas Cyflogwyr y Prifysgolion a’r Colegau (UCEA) a holl undebau llafur cydnabyddedig y sector addysg uwch i ddiwygio strwythurau cyflog, graddfeydd a rhai telerau ac amodau ar draws y sector. Cafodd hyn ei roi ar waith trwy gytundeb lleol rhwng y brifysgol a’r undebau llafur yn 2008.
Y Cydbwyllgor Negodi newydd ar gyfer Staff Addysg Uwch (JNCHES) yw’r fforwm lle mae’r cyflogwyr sy’n cymryd rhan, a gynrychiolir gan UCEA, a’r undebau llafur yn negodi ynghylch y codiad sylfaenol i’r Golofn Gyflog Genedlaethol, a ddaw i rym ar 1 Awst bob blwyddyn. Mae amserlen negodi’r Cydbwyllgor newydd yn broses sy’n rhedeg ar draws cyfarfodydd a gynhelir ym mis Mawrth, Ebrill a Mai ac yn caniatáu ar gyfer cynnal tri chyfarfod negodi. Mae’r brifysgol yn penderfynu bob blwyddyn a fydd yn cymryd rhan mewn trafodaethau cenedlaethol. Yna dyfernir y dyfarniad cyflog sylfaenol i holl staff y brifysgol.
Ym Mangor, mae mwyafrif staff y brifysgol yn dod o fewn un golofn gyflog sengl ac yn unol â hynny pennwyd proffiliau swydd iddynt ar sail Dadansoddiad Rolau Addysg Uwch (HERA), gan eu categoreiddio felly fel ‘gwaith tebyg’.Mae’r Brifysgol wedi pennu, ac yn defnyddio, naw graddfa ar yr un golofn gyflog sengl honno.
Mae swyddi Athrawon o fewn y band priodol ar gyfer staff sydd yn Athrawon (ehangodd y Brifysgol y golofn sengl ym mis Awst 2015 i gynnwys rolau Athrawon), sef Band 1 (ar gyfer ymuno â’r llwybr athrawon), Band 2 (ar gyfer unigolion ag enw da sydd wedi’u hen sefydlu) a Band 3 (ar gyfer ffigyrau academaidd o bwys).
Mae rolau cyfarwyddwr fel arfer yn rolau sydd y tu allan i’r golofn sengl a’r bandio ar gyfer Athrawon, e.e. y rhai sy’n cael cyflog uwchlaw pwynt 51.
Mae’r Brifysgol hefyd yn gwneud taliad atodol o’i gwirfodd mewn perthynas â’r Cyflog Byw gwirioneddol, gan gynnwys gwahaniaeth cyflog cysylltiedig, sy’n berthnasol i’r pwyntiau cyflog is ar y raddfa 51 pwynt.
Mae’r Brifysgol fel rheol yn cynnig nifer o gyfleoedd am ddyrchafiad bob blwyddyn yn ogystal â Dilyniant Cyflog o fewn Graddfeydd a Chyflog ar sail Cyfraniad ar gyfer pob graddfa o fewn y golofn sengl 51 pwynt ac yn y Bandiau ar gyfer Athrawon. Cytunwyd ar y polisïau hyn yn lleol gydag undebau llafur y brifysgol.
Sefydlwyd y Cydbwyllgor Negodi ar gyfer Staff Addysg Uwch (JNCHES) yn 2001 fel y cyfrwng cysylltiadau diwydiannol ar gyfer y sector i drafod tâl ac amodau gwasanaeth. Bydd newidiadau mewn amodau gwasanaeth, y cytunir arnynt o bryd i’w gilydd, yn cael eu hymgorffori yn awtomatig yng nghontractau unigol yr aelodau staff hynny a ddiogelir gan y cytundeb hwnnw, a hysbysir staff yn unol â gofynion Deddf Diwygio Undebau Llafur a Chysylltiadau Cyflogaeth 1993.
Mae Prifysgol Bangor yn cydnabod yr undebau llafur canlynol at ddibenion ymgynghori ar lefel leol gyda’r Brifysgol ynglŷn â pholisïau ac amodau lleol, ac maent yn darparu cefnogaeth unigol ac ar y cyd i aelodau a chanddynt broblemau: UCU; Unite; ac Unsain.
Mae Cyngor y Brifysgol wedi sefydlu Pwyllgor Taliadau i fod yn un o bwyllgorau sefydlog y Cyngor. Y Pwyllgor hwn sy’n penderfynu ar dâl yr Is-ganghellor, aelodau’r Bwrdd Gweithredol a staff sy’n derbyn cyflogau o £100,000 a mwy, ac yn adolygu’r penderfyniadau hynny.
Mae’r Pwyllgor Taliadau yn gyfrifol am bennu ac adolygu strategaeth gyflogau gyffredinol ar gyfer uwch swyddogion y brifysgol. Rhaid iddo sicrhau bod gwybodaeth berthnasol mewn perthynas â chydraddoldeb ac amrywiaeth yn cael ei hystyried yn llawn ym mhob mater sy’n ymwneud â chyflogau uwch-aelodau staff a’r staff hynny sy’n dod oddi fewn i gylch gorchwyl y Grŵp Adolygu Cyflogau UwchAelodau Staff.
Cafodd y cylch gorchwyl ei lunio yn unol â Chod Taliadau Uwch-Aelodau Staff Addysg Uwch y Pwyllgor Cadeiryddion Prifysgol. Nid yw’r Is-ganghellor yn aelod o’r Pwyllgor hwn.
Mae gwybodaeth a ystyriwyd gan y Pwyllgor Taliadau yn cynnwys fforddiadwyedd, gwybodaeth gymharol am daliadau o fewn y sector neu fannau eraill a metrigau a data perfformiad perthnasol. Caiff perfformiad staff ei ystyried yn erbyn safonau a nodwyd.
Mae’r Brifysgol yn cyhoeddi ei Datganiadau Ariannol ar gyfer pob blwyddyn yn diweddu 31 Gorffennaf. Mae rhain yn cynnwys cyflog yr Is-Ganghellor sydd i’w weld ar Dudalen 114.
Mae’r Pwyllgor Taliadau yn sicrhau bod y brifysgol yn cydymffurfio â’r egwyddorion a fabwysiadwyd yng nghanllawiau’r Pwyllgor Cadeiryddion Prifysgol ar Benderfyniadau a wneir ynghylch Taliadau Diswyddo mewn Sefydliadau Addysg Uwch mewn perthynas ag unrhyw delerau diswyddo i uwch-aelodau staff.
DATGANIAD BLYNYDDOL Y POLISI CYFLOGAU
Cydberthynas cyflogau
Y tâl isaf yn y Brifysgol, o 1 Mai 2021, yw £9.90. Mae hyn wedi’i alinio â’r Cyflog Byw Gwirioneddol y mae Prifysgol Bangor wedi ymrwymo iddo fel aelod achrededig.
Yn ystod 2021/22 yr Is-ganghellor yw’r aelod staff ar y cyflog uchaf yn y Brifysgol gyda chyflog o £223,000.
Mae’r gymhareb rhwng yr enillion uchaf a’r enillion canolrifol yn y brifysgol fel a ganlyn:
Ein cenhadaeth
Prifysgol Gogledd Cymru ac ar gyfer Gogledd Cymru, sy’n cael ei harwain gan ymchwil ac yn meithrin effaith gadarnhaol ar gymdeithas yn rhanbarthol, yn genedlaethol ac yn rhyngwladol.
Y Brifysgol mewn cyd-destun
Mae Prifysgol Bangor yn parhau i ragori ar adeg pan mae addysg uwch yng Nghymru a’r Deyrnas Unedig yn wynebu cyfnod heriol. Rydym wedi ymrwymo i adeiladu ar lwyddiannau diweddar, gan weithio gyda chymunedau amrywiol a nodedig i ddarparu addysgu, ysgolheictod ac ymchwil rhagorol, gan gadw ein pwyslais cryf ar gyfraniad nodedig a gwerthfawr ein myfyrwyr a pharhau’n ffyddlon i’n cyd-destun dwyieithog a diwylliannol unigryw.
Adolygu
Cyhoeddwyd y datganiad hwn ar wefan Prifysgol Bangor. Bydd yn cael ei adolygu bob blwyddyn neu pan wneir unrhyw newidiadau.
Mae’r cyfraniad mawr yr ydym yn ei wneud i wella gofal iechyd a lles, dwyieithrwydd a gwarchod yr amgylchedd, yn ei gwneud yn amlwg bod yr ymchwil sy’n cael ei wneud gan academyddion Prifysgol Bangor yn cael effaith gadarnhaol ar yr economi ac ar fywydau pobl ledled y byd.
Yn dilyn canlyniad llwyddiannus Fframwaith Rhagoriaeth Ymchwil 2021 lle barnwyd fod 85% o ymchwil y Brifysgol gyda’r gorau yn y byd neu’n rhagorol yn rhyngwladol, rydym yn parhau i adeiladu ar ein rhagoriaeth ymchwil, i ddarparu amgylchedd lle gall y gymuned ymchwil ffynnu, gan gefnogi’r meysydd presennol o gryfder ymchwil, meithrin meysydd ymchwil newydd ar draws yr holl ddisgyblaethau, a bod yn sail i addysgu sy’n cael ei lywio gan ymchwil sef yr hyn sy’n gefn i’r haddysgu o ansawdd uchel a’r profiad a gaiff ein myfyrwyr.
Rydym yn gweithio gyda busnesau, llywodraethau a chyn-fyfyrwyr i sicrhau bod Prifysgol Bangor yn parhau’n berthnasol i’w hanghenion ac i anghenion eginfarchnadoedd, gan sicrhau ein bod yn uchafu ein cyfraniad cadarnhaol i’r economi leol a rhanbarthol.
Mae’r Brifysgol yn dal i fod wedi ymrwymo i ffurfio cysylltiadau strategol manteisiol yn y rhanbarth. Yn benodol, cryfhau ymhellach y berthynas â Bwrdd Iechyd Prifysgol Betsi Cadwaladr fel llwyfan i adeiladu cryfder cydweithredol pellach mewn ymchwil ac addysg sy’n ymwneud ag iechyd a meddygaeth.
Cyfeiriad Strategol
Mae’r Brifysgol yn parhau i fod yn ymrwymedig i’w nodau strategol hirdymor fel yr amlinellir yn Strategaeth 2030. Dyma strategaeth ac ynddi weledigaeth o ran ei chwmpas a’i huchelgais sy’n rhannu’r cyfeiriad y bydd y Brifysgol yn ei ddilyn i fywiogi ei chymuned a’i rhanddeiliaid dros y degawd nesaf. Yn sail i’r strategaeth mae pedair colofn : Rhagoriaeth ymchwil, profiadau dysgu trawsnewidiol, profiad rhagorol i fyfyrwyr, ac amgylchedd dwyieithog lle mae’r Gymraeg yn ffynnu.
Mae’r Brifysgol mewn sefyllfa gref fel prifysgol ddwyieithog Gogledd Cymru ac ar gyfer Gogledd Cymru, sy’n entrepreneuraidd ac yn cael ei harwain gan ymchwil. Fel sefydliad llwyddiannus, mae’r Strategaeth yn amlinellu lle y bwriada’r Brifysgol fod yn 2030, gan ddatblygu’r màs critigol sy’n angenrheidiol i chwarae ein rhan yn fydeang, gan fanteisio ar ddarbodion maint a bod yn gynaliadwy yn academaidd, yn weithredol ac yn ariannol. Felly mae’r Brifysgol yn parhau i ganolbwyntio ar dwf, gan gydnabod heriau’r amgylchedd gweithredu wrth i addysg uwch ddod allan o gyfnod pandemig byd-eang COVID-19 a wynebu’r economi chwyddiant uchel sydd ohoni.
Cytunodd y Brifysgol ar ei strategaeth ar gyfer yr ystâd fel rhan o’i phroses gynllunio ym mis Gorffennaf 2022. Dros y blynyddoedd diwethaf rydym wedi cwblhau nifer o ddatblygiadau newydd, sy’n cynnwys llety myfyrwyr yn ogystal â mannau ar gyfer addysgu ac ymchwil ac ymwneud â’r gymuned. Maent yn amrywio o ddatblygiadau newydd i waith ar brif adeilad hanesyddol y brifysgol, er mwyn sicrhau y bydd myfyrwyr y dyfodol yn elwa o gael cyfleusterau academaidd rhagorol a phrofiad penigamp fel myfyrwyr.
Bod yn brifysgol ac iddi gysylltiadau byd-eang, sy’n gwireddu cyfleoedd ar gyfer llwyddiant trwy ymchwil ac addysgu trawsnewidiol ac arloesol a sbardunir gan effaith, gyda ffocws ar gynaliadwyedd: diogelu’r amgylchedd, adfywio iechyd cymdeithas, a hyrwyddo ffyniant economaidd, cymdeithasol, dwyieithog, a diwylliannol.
Recriwtio myfyrwyr
Mae recriwtio myfyrwyr yn parhau i fod yn farchnad gystadleuol iawn, a does dim cap go iawn wedi ei roi ar niferoedd sefydliadau addysg uwch yn Lloegr nac yng Nghymru. Yn dilyn lefelau is o recriwtio myfyrwyr yn gyffredinol yn y flwyddyn flaenorol, gwelwyd gwelliant eleni yn nifer y myfyrwyr a recriwtiwyd yn gyffredinol yn y Brifysgol. Roedd y gwelliant hwn yn arbennig o amlwg wrth recriwtio myfyrwyr tramor yn dilyn y gostyngiad pan oedd effaith y pandemig ar ei waethaf.
Ym mis Medi 2018 newidiodd y cyllid ar gyfer addysgu a’r ffioedd a delir gan israddedigion, a bellach mae system sydd wedi’i seilio ar fenthyciadau yn cael ei gweithredu i israddedigion o Gymru a Lloegr, tra bo israddedigion o Gymru hefyd yn manteisio ar grant cynhaliaeth o rhwng £1,000 a mymryn dros £10,000 a hynny’n seiliedig ar brawf modd.
O’r herwydd gwelwyd cynnydd mewn myfyrwyr yn symud ar draws ffiniau gwledydd ac mae holl sefydliadau’r Deyrnas Unedig wedi cynyddu eu gweithgarwch o ran marchnata a throsi ceisiadau’n dderbyniadau pendant. Rydym yn parhau i fonitro ein marchnata ac yn parhau i ddatblygu dulliau arloesol o farchnata a byddwn yn parhau i ddatblygu rhaglenni traddodiadol a chyfoes mewn meysydd y mae galw amdanynt gan fyfyrwyr neu gyflogwyr, yn lleol ac yn fyd-eang, er mwyn sicrhau bod Prifysgol Bangor yn parhau’n gystadleuol yn y farchnad newydd.
Mae HEFCW wedi cytuno ar gynllun ffioedd, yn cynnwys ffi o £9,000 i israddedigion Cartref ar gyfer y blynyddoedd hyd at 2022-23. Mae’r cynllun ffioedd yn cynnwys buddsoddiadau cynyddol i gefnogi ehangu mynediad, profiad myfyrwyr, darpariaeth cyfrwng Cymraeg a chyflogadwyedd, gan gynnwys rhoi mynediad am ddim i’r holl glybiau chwaraeon, cymdeithasau a gweithgareddau gwirfoddoli yn undeb y myfyrwyr, a rhoi gwell darpariaeth llyfrgell a chwaraeon.
Mae cynyddu niferoedd myfyrwyr ôl-radd a rhyngwladol yn bwysig hefyd, a byddwn yn sicrhau bod y cyrsiau a gynigiwn yn gynaliadwy ac yn ddeniadol, gan adeiladu ar brofiad myfyrwyr, a chryfhau brand y brifysgol gartref a thramor. Mae datblygu cysylltiadau agosach gyda nifer o bartneriaid rhyngwladol, yn ogystal â pharhau i ddatblygu Coleg Bangor yn Tsieina, yn gamau allweddol i ddatblygu llif cyson o fyfyrwyr i’r Deyrnas Unedig, yn ogystal ag ehangu ôl troed ein haddysgu a’r mannau y daw ein myfyrwyr ohonynt.
Mae Strategaeth Ystadau’r Brifysgol yn parhau i gael ei hadolygu’n rheolaidd er mwyn sicrhau bod gennym y capasiti a’r gallu i ddarparu’n effeithiol ar gyfer ystod eang o weithgarwch addysgu ac ymchwil ar draws portffolio eang o ddisgyblaethau. Mae
hyn yn ystyried tueddiadau newydd a thueddiadau sy’n cael eu rhagweld ar gyfer mannau gwaith ac amgylcheddau addysgu a dysgu, a’r angen hefyd am fannau dysgu cymdeithasol ochr yn ochr ag ystafelloedd addysgu mwy ffurfiol.
Mae ein strategaeth Ystadau yn cynnwys cynaliadwyedd fel ystyriaeth anhepgor wrth ddatblygu’r Brifysgol yn y dyfodol. Mae canolfan Pontio, sef adeilad gwerth miliynau o bunnoedd, Canolfan Fôr Cymru ym Mhorthaethwy a Phentref Myfyrwyr y Santes Fair yn ddatblygiadau a gwblhawyd yn y blynyddoedd diwethaf a dderbyniodd sgôr BREEAM rhagorol. Bwriedir gwneud gwaith datblygu sylweddol ar Ardal Wyddoniaeth y Brifysgol ar Ffordd Deiniol, tra cafodd Parc Gwyddoniaeth Menai yn Y Gaerwen ei gwblhau yn 2018.
Rydym hefyd yn cychwyn ar raglen effeithlonrwydd ynni uchelgeisiol Buddsoddi er mwyn Arbed wrth i ni geisio cyflawni ein hamcanion a’n targedau tymor hir. Bob blwyddyn mae’r Brifysgol yn sicrhau bod 5% o’i chostau ynni ar gael ar gyfer mentrau o’r fath. Mae enghreifftiau diweddar yn cynnwys goleuadau LED Garddwriaethol yn ein tai gwydr yn Henfaes a’r Adeilad Coffa, gosod wrinalau di-ddŵr, ôl-osod pennau cawod sy’n defnyddio dŵr yn effeithlon yn ein neuaddau preswyl, a phrynu cerbydau trydan yn lle faniau disel sy’n cyrraedd diwedd eu hoes fel rhan o fflyd y Gwasanaethau Eiddo a Champws. Bydd yr holl ynni sy’n cael ei arbed yn cyfrannu at ein targedau o ran parhau i ostwng ein hôl-troed carbon, sydd wedi bod yn gostwng yn gyson ers nifer o flynyddoedd.
Dyma pam fod Prifysgol Bangor ymhlith y prifysgolion gorau yn y Deyrnas Unedig o ran ei pherfformiad amgylcheddol a moesegol, yn ôl meini prawf y gynghrair prifysgolion People & Planet. Mae hwn yn dabl cynghrair annibynnol sy’n gosod sefydliadau yn flynyddol yn seiliedig ar berfformiad amgylcheddol a moesegol.
Prif risgiau ac ansicrwydd
Mae’r Brifysgol yn cydnabod bod risgiau ac ansicrwydd cynhenid yn gysylltiedig â sawl agwedd ar ei gweithrediadau. Mae’n anelu at adnabod, rheoli a lliniaru’r risgiau hynny lle bynnag y bo modd a hyrwyddo diwylliant o reoli risgiau drwy’r Brifysgol gyfan. Caiff y gofrestr risg sefydliadol ei hadolygu’n ffurfiol gan y Grŵp Tasg Rheoli
Risg a’r Bwrdd Gweithredol yn rheolaidd. Adroddir ar y gofrestr o bryd i’w gilydd i’r Pwyllgor Archwilio a Risg. Mae’r broses hon, ynghyd ag ystyriaethau eraill, yn llywio’r cynllun archwilio mewnol ar gyfer y flwyddyn i ddod, yn ogystal â galluogi’r Pwyllgor Archwilio a Risg i roi sicrwydd i’r Cyngor trwy gyfrwng yr Adroddiad Blynyddol.
Ymysg y risgiau allweddol sydd o bwysigrwydd neilltuol i’r Brifysgol ar hyn o bryd mae’r canlynol:
Recriwtio’r nifer a gynlluniwyd o fyfyrwyr israddedig ac ôl-radd o’r Deyrnas
Unedig, o’r Undeb Ewropeaidd ac yn rhyngwladol yn dilyn ymateb annigonol i farchnad gynyddol gystadleuol, gan gynnwys ein gallu i gyflawni rhagolygon recriwtio myfyrwyr, o ystyried diwygiadau a wnaed i drefn cyllido myfyrwyr a chynnydd mewn buddsoddi ym maes marchnata gan sefydliadau sy’n
cystadlu â ni
Effaith bosibl newidiadau i gyllid allanol, cyfundrefnau rheoleiddio a statudol
Effaith hirdymor posibl y gost o ddarparu pensiynau a buddion wedi’u diffinio gan gydnabod y gwelliant tymor byrrach mewn cyllid sy’n deillio o amrywiadau diweddar yn y farchnad
Methu â chynnal iechyd ariannol y sefydliad, a chynnal hylifedd, ar adeg o gyfyngiadau economaidd sylweddol, chwyddiant uwch a chystadleuaeth gynyddol
— Sicrhau profiad myfyriwr o ansawdd uchel
Mae risgiau eraill y mae’r brifysgol yn eu rheoli ar sail barhaus. Mae’r rhain yn cynnwys:
— Sicrhau bod ystâd y brifysgol yn cydymffurfio ac yn addas i’r diben
Sicrhau cydymffurfiaeth â deddfwriaeth a rheoliadau e.e. diogelwch data, rheoliadau’n ymwneud â fisas
Sicrhau bod cyfamodau benthyciadau banc yn cael eu bodloni
Perfformiad gweithredu
Yn y flwyddyn hyd 31 Gorffennaf 2022 ymatebodd y Brifysgol yn gryf yn dilyn uchafbwynt y pandemig Covid-19 yn y flwyddyn flaenorol. Yn gyffredinol, cynyddodd yr incwm gan £9.9 miliwn er gwaethaf gostyngiad o £5.5 miliwn mewn grantiau gan gyrff cyllido ar ôl cael gwared ar ffrydiau ariannu ychwanegol oedd yn ymwneud â’r pandemig. Bu cynnydd o £4.0 miliwn mewn ffioedd dysgu wedi’i ysgogi gan lwyddiant wrth recriwtio myfyrwyr tramor. Gwelwyd twf mewn incwm hefyd o ran grantiau a chontractau ymchwil ac incwm arall. Caiff yr olaf ei sbarduno gan gynnydd yn incwm preswylfeydd, arlwyo a chynadleddau.
Effeithir ar y diffyg cyn treth o £35.5 miliwn a adroddwyd am y flwyddyn gan sawl ffactor yn ystod y flwyddyn, gan gynnwys addasiadau pensiwn a digwyddiad addasu ar ôl dyddiad y fantolen. Mae’r perfformiad sylfaenol fel y caiff ei fesur gan EBITDA (enillion cyn llog, treth, dibrisiant ac amorteiddio) yn well adlewyrchiad o’r perfformiad cyfredol.
Mae’r Brifysgol, felly, yn adrodd ar fesur ychwanegol sef cynaliadwyedd ariannol, wedi ei seilio ar addasu canlyniadau ar gyfer symudiadau blynyddol anghylchol, yn unol â methodoleg a ddatblygwyd i’w defnyddio ar draws y sector addysg uwch.
Mae’r mesur a fabwysiadwyd yn seiliedig ar EBITDA ond yna tynnir effaith addasiadau anghylchol sy’n bresennol yn y ffigyrau cyhoeddedig; mae hyn yn caniatáu cymharu, mewn modd mwy realistig ac ystyrlon, berfformiad rhwng blynyddoedd, neu hyd yn oed sefydliadau.
Mae’r tabl isod yn amlinellu’r canlyniadau a geir wrth ddefnyddio methodoleg
‘EBITDA Addasedig Addysg Uwch’:
Mae EBITDA Addasedig AU 2021/22 o £17.7m yn cynrychioli canlyniad cadarnhaol mewn blwyddyn heriol. Cydnabyddir fodd bynnag bod gwaith sylweddol i’w wneud o hyd i symud i sefyllfa o gynaliadwyedd ariannol tymor hir.
O ran costau, arhosodd cyfanswm y costau staff, heb gynnwys y cynnydd yr adroddwyd ar wahân yn ei gylch yn y ddarpariaeth bensiwn ar gyfer cynllun pensiwn yr USS, yn gymharol ddigyfnewid ar £86.5 miliwn. Y cynnydd yn y ddarpariaeth pensiynau ar gyfer USS oedd £34.4 miliwn, cynnydd o £33.0 miliwn ar y flwyddyn flaenorol. Mae’r USS wedi datgan bod cryfder ariannol y cynllun wedi gwella yn ystod y flwyddyn ddiwethaf ond mae’n parhau i fod yn gyfnewidiol. Disgwylir i’r cynllun gael prisiad tair blynedd ffurfiol a gynhelir ddiwedd Mawrth 2023.
Bu gostyngiad bychan yn y symudiad ar ddarpariaethau pensiwn ar gyfer BUPAS, cynllun y Brifysgol ei hun, a gynhwyswyd mewn costau staff, i £1 miliwn o £1.1 miliwn yn y flwyddyn flaenorol.
Yn gynwysedig yn y cyfanswm gwariant mae effaith yr amhariad a dymchweliad dilynol adeilad ar Gampws Bangor. Yn dilyn asesiad o ddiogelwch yr adeilad penderfynwyd dymchwel yr adeilad fel mater o frys. O ganlyniad amharwyd ar werth yr adeilad yn ystod y flwyddyn ac mae darpariaethau i gwrdd â chostau’r dymchwel wedi’u cynnwys mewn costau gweithredu eraill.
Mae costau nad ydynt yn ymwneud â chyflogau yn parhau i gael eu rheoli ac yn unol â’r rhagolygon. Bu cynnydd cyffredinol o £9.7 miliwn mewn costau gweithredu eraill sy’n adlewyrchu’r costau ychwanegol a gafwyd i gefnogi’r cynnydd mewn incwm ar draws y Brifysgol a’r costau ychwanegol sy’n gysylltiedig â’r gwaith dymchwel adeiladau. Cynyddodd costau dibrisiad o ganlyniad i’r buddsoddiadau cyfalaf parhaus.
Cymharol ychydig yw’r materion sy’n teilyngu sylw mewn perthynas â’r Datganiad Sefyllfa Ariannol. Mae gwariant cyfalaf eleni wedi bod yn gyfyngedig, a dim ond yn rhannol y mae’n gwrthbwyso’r tâl dibrisiad, gan esbonio felly pam fod gostyngiad mewn asedau anghyfredol. Cynyddodd arian parod a chywerthoedd arian parod ychydig yn ystod y flwyddyn i £45.1 miliwn. Cynyddodd asedau cyfredol net oherwydd cynnydd mewn symiau masnach derbyniadwy a rhagdaliadau ac incwm cronedig, wedi ei wrthbwyso gan gynnydd mewn croniadau ac incwm gohiriedig.
Yn dilyn Cynllun Pensiwn BUPAS y Brifysgol ei hun yn adrodd gwarged o £3.6 miliwn ar 31 Gorffennaf 2021, canlyniad y tybiaethau prisio ar 31 Gorffennaf 2022 yw bod y cynllun wedi dychwelyd gwarged uwch, sydd bellach yn £15.7 miliwn. Yn unol ag adroddiadau blaenorol, cydnabyddir hyn yn y Datganiad Sefyllfa Ariannol.
Fel y nodwyd yn flaenorol, yn dilyn y symudiadau mewn darpariaethau pensiwn yn ystod y flwyddyn, bu cynnydd cyffredinol yn y darpariaethau pensiwn i £39.7m, o £17.3m yn y flwyddyn flaenorol.
Mae’r asedau net cyffredinol ar ddiwedd y flwyddyn yn £212.4 miliwn, i lawr o £234.8 miliwn wedi ei sbarduno yn bennaf gan y cynnydd mewn darpariaethau pensiwn. Mewn perthynas â llif arian, gostyngodd y mewnlif arian parod net o weithgarwch
gweithredol i £16.5 miliwn o £20.4 miliwn yn y flwyddyn flaenorol. Mae hyn yn adlewyrchu’r cynnydd mewn asedau cyfredol net.
Cynlluniau pensiwn
Cwblhawyd prisiad tair blynedd ‘Cynllun Pensiwn ac Yswiriant Prifysgol Bangor’ (BUPAS) 2020 yn ystod 2020/21, a chytunwyd ar atodlen cyfraniadau newydd gyda’r ymddiriedolwyr yn ystod y flwyddyn. Mae’r ffigyrau sy’n sail i’r prisiad hwnnw wedi darparu’r sail ar gyfer ffigyrau prisiad 31 Gorffennaf 2022 sydd wedi ei gynnwys yn y cyfrifon hyn.
Bu’n bryder mawr i’r brifysgol, ac i’r sector addysg uwch, bod y cynllun cenedlaethol i staff academaidd a chysylltiedig (USS) wedi wynebu diffygion cynyddol yn ystod y blynyddoedd diwethaf. Cynhaliodd USS brisiad tair blynedd yn seiliedig ar Fawrth 2020 a chafodd canlyniad y prisiad ei gadarnhau’n derfynol yn ystod y flwyddyn hyd 31 Gorffennaf 2022. Defnyddiwyd y tybiaethau ym mhrisiad terfynol Mawrth 2020 i gyfrifo’r darpariaethau diwedd blwyddyn ar 31 Gorffennaf 2022.
Er bod ymddiriedolwyr yr USS wedi adrodd bod sefyllfa ariannol y cynllun wedi gwella yn ystod y flwyddyn ddiwethaf, mae’n parhau i fod yn gyfnewidiol. Disgwylir prisiad tair blynedd nesaf y cynllun ym mis Mawrth 2023.
Polisïau ac amcanion y trysorlys
Mae gan y Brifysgol nifer o gronfeydd yn deillio o gymynroddion a rhoddion eraill, sy’n cael eu cydnabod yn y cyfrifon hyn fel naill ai gwaddolion neu roddion gyda neu heb gyfyngiadau. Bu’r cronfeydd hyn yn cael eu buddsoddi ar sail gyfun a’u rheoli gan UBS yn unol â pholisi buddsoddi cynaliadwy’r brifysgol. Yn ystod y flwyddyn, cafwyd gostyngiad o £26k yn y cronfeydd ynghyd ag incwm o £200k. Cyfanswm gwerth y cronfeydd gwaddol ar 31 Gorffennaf 2022 oedd £8.2 miliwn, gan gynnwys incwm cronedig o £1.4 miliwn.
Llif arian a hylifedd
Caeodd sefyllfa llif arian a hylifedd y brifysgol mewn sefyllfa well. Cynyddodd Asedau Cyfredol Net i £33.8 miliwn (2020-21 £29.4 miliwn). Bu gostyngiad yn y mewnlif arian parod net a gynhyrchwyd o weithgareddau gweithredol i £16.5 miliwn (2020-21 £20.4 miliwn).
Mae’r sefyllfa hylifedd ar ddiwedd y flwyddyn yn cynrychioli lefel normal ar gyfer yr adeg hon o’r flwyddyn, ac fe’i cyfnerthir gan gyfleuster credyd cylchol gyda Santander na chafodd ei ddefnyddio yn ystod 2021-22.
Arian cyfalaf
Cafwyd gwariant o £10.1 miliwn ar brojectau cyfalaf yn 2021-22 (2020-21 £8.9 miliwn). Buddsoddwyd mewn cynnal yr ystâd ac mewn asedau offer sy’n cefnogi gweithgarwch addysgu ac ymchwil a gweithgarwch y gwasanaethau proffesiynol ar draws yr holl safleoedd a ddefnyddiwn.
Busnes hyfyw
Mae gweithgareddau’r Grŵp a’r Brifysgol, ynghyd â’r ffactorau sy’n debygol o effeithio ar ddatblygiad, perfformiad, sefyllfa ariannol, llifoedd arian, hylifedd a chyfleusterau benthyca, i’r dyfodol wedi’u nodi yn yr Adolygiad Strategol sy’n rhan o’r Adolygiad Blynyddol.
Mae’r Grŵp a’r Brifysgol yn cyflawni ei ofynion o ran cyfalaf gweithio o ddydd i ddydd drwy falansau arian parod anghyfyngedig presennol, sy’n ddigonol i gwrdd â rhwymedigaethau fel y dônt yn ddyledus hyd y gellir rhagweld. Mae’r Cyngor wedi paratoi rhagolygon manwl am lif arian ar gyfer 2022-23 a 2023-24. Ar ôl adolygu’r rhagolygon hyn, mae’r Cyngor o’r farn, o ystyried risgiau anfantais
difrifol ond credadwy, y bydd gan y Grŵp a’r Brifysgol ddigon o arian i gyflawni eu rhwymedigaethau wrth iddynt ddod yn ddyledus dros gyfnod o 12 mis o leiaf o ddyddiad cymeradwyo’r datganiadau ariannol (y cyfnod asesu busnes hyfyw).
Parhaodd y pandemig coronafeirws i effeithio ar y Brifysgol, yn weithredol ac yn ariannol, yn ystod y flwyddyn hyd at 31 Gorffennaf 2022 ond ar lefel llawer llai nag yn y flwyddyn flaenorol. Mewn ymateb i hyn a’r risgiau eraill y tynnir sylw atynt yn yr adroddiad, mae’r Brifysgol yn parhau i reoli ei chostau a’i phrojectau gwariant cyfalaf yn ofalus.
Asesodd y Brifysgol nifer o senarios gan amcangyfrif yr effeithiau ariannol amrywiol y risgiau y mae’n eu hwynebu mewn nifer o feysydd, yn enwedig niferoedd myfyrwyr a chynhyrchu incwm ffioedd ynghyd ag incwm neuaddau ac incwm masnachol. Roedd hyn hefyd yn cynnwys asesiad o effaith gredadwy chwyddiant ar gostau staff a chostau gweithredu.
Mae gan y Brifysgol Gyllideb ar gyfer 2022-23 yn seiliedig ar y sefyllfa o ran recriwtio myfyrwyr, ynghyd â rheolaeth dros wariant cyfalaf i gynnal hylifedd. Nid oes gan y Brifysgol unrhyw gynlluniau i gynyddu lefel ei chyfleusterau cyllido, ac eithrio o bosibl y rhai sy’n gysylltiedig â chynlluniau cymorth y llywodraeth lle bo hynny’n briodol, y tu hwnt i’r rhai hynny oedd ar waith ar 31 Gorffennaf 2022 yn ystod y cyfnod asesu busnes hyfyw. Ni thorrwyd unrhyw gyfamodau bancio ac ni ragwelir y bydd hynny’n digwydd yn ystod y cyfnod asesu busnes hyfyw.
O ganlyniad i’r adolygiad hwn, mae’r Cyngor o’r farn bod y Grŵp a’r rhiantBrifysgol yn gallu rheoli ei risgiau cyllid a’i risgiau busnes ac yn parhau i gyflawni ei rhwymedigaethau wrth iddynt ddod yn ddyledus am o leiaf 12 mis o ddyddiad cymeradwyo’r datganiadau ariannol ac felly paratowyd datganiadau ariannol ar sail busnes hyfyw.
Mae Prifysgol Bangor yn Elusen Gofrestredig (rhif 1141565) yn unol â thelerau Deddf Elusennau 2011. Wrth bennu ac adolygu amcanion a gweithgareddau’r Brifysgol, mae’r Brifysgol wedi rhoi sylw dyledus i ganllawiau’r Comisiwn Elusennau ar adrodd ar fudd cyhoeddus a’r canllawiau atodol i elusennau a sefydlwyd at ddiben addysgol.
Mae Prifysgol Bangor yn sefydliad cryf a hyderus a gaiff ei gydnabod yn rhanbarthol, yn genedlaethol ac yn rhyngwladol fel canolfan ragoriaeth am ei bortffolio amrywiol o addysgu ac ymchwil, ac am y profiad unigryw, amlddiwylliannol a chynhwysol y mae’n ei roi i staff a myfyrwyr. Sefydlwyd y Brifysgol o ganlyniad uniongyrchol i ymgyrch gan gymunedau yng Ngogledd Cymru am ddarpariaeth addysg uwch i’r rhanbarth. Wedi’i sefydlu gan gefnogaeth leol sylweddol, yn ariannol ac fel arall, mae’r Brifysgol yn parhau i ymfalchïo yn ein swyddogaeth fel aelod o’r gymuned ac yn ein treftadaeth ddwyieithog.
Ein nod yw bod yn Brifysgol Gogledd Cymru ac ar gyfer Gogledd Cymru, sy’n cael ei harwain gan ymchwil, gan ddarparu profiadau dysgu trawsnewidiol a meithrin effaith gadarnhaol ar gymdeithas yn rhanbarthol, yn genedlaethol ac yn rhyngwladol.
Profiadau Dysgu Trawsnewidiol / Profiad rhagorol i fyfyrwyr
Mae’r Brifysgol yn darparu addysg uwch mewn ystod eang o ddisgyblaethau yn y celfyddydau a’r dyniaethau, gwyddorau cymdeithas, gwyddorau naturiol, gwyddorau ffisegol, iechyd ac addysg. Y colofnau sy’n sail i strategaeth y Brifysgol yw darparu profiadau dysgu trawsnewidiol a phrofiad rhagorol i fyfyrwyr mewn amgylchedd dwyieithog lle mae’r Gymraeg yn ffynnu.
Mae’r Brifysgol yn hyrwyddo ac yn diogelu mynediad teg i addysg uwch, yn cynnwys adnabod unigolion o gefndiroedd difreintiedig sydd â photensial mawr. Ymdrechwn i ddenu a dal gafael ar fyfyrwyr a darpar fyfyrwyr o grwpiau heb gynrychiolaeth ddigonol, gan godi dyheadau addysgol a datblygu sgiliau i baratoi myfyrwyr ar gyfer astudio mewn addysg uwch. Mae’r Brifysgol yn gweithio gyda nifer o bartneriaid, gan gynnwys Ymestyn yn Ehangach: Partneriaeth Gogledd a Chanolbarth Cymru, awdurdodau addysg lleol, a cholegau addysg bellach lleol i hyrwyddo astudiaethau prifysgol ar bob lefel. Rydym yn diogelu mynediad teg ac yn dal gafael ar ragor o fyfyrwyr drwy ddarparu bwrsariaethau, ysgoloriaethau a chynlluniau caledi i rai sy’n gadael gofal ac i’r digartref.
Mae’r Brifysgol yn gweithio gydag ysgolion i godi dyheadau addysgol ac ymwybyddiaeth grwpiau sydd heb gynrychiolaeth ddigonol; trwy adnabod unigolion sydd â photensial, a datblygu sgiliau i baratoi myfyrwyr ar gyfer addysg uwch. Mae’r gefnogaeth yn cynnwys cyngor ac arweiniad cyn ymgeisio, sgyrsiau cyswllt ysgolion, rhedeg ein Rhaglen Dawn a Chyfle, sef un o’r rhaglenni ehangu mynediad mwyaf yn y wlad. Mae’r Brifysgol hefyd yn lleoliad delfrydol ar gyfer ymweliadau preswyl ar gyfer gweithgareddau sy’n amrywio o waith maes ac wythnosau gweithgaredd i Gyflwyniad i raglenni addysg uwch.
Mae’r Brifysgol, trwy ei gwasanaeth Sgiliau a Chyflogadwyedd, yn darparu ystod o adnoddau i gefnogi myfyrwyr i ddatblygu sgiliau personol a gwella cyflogadwyedd. Rydym yn cynnig Gwobr Cyflogadwyedd Bangor fel cwrs ar-lein cynhwysfawr sy’n cefnogi myfyrwyr, profiad gwaith a lleoliadau ac interniaethau.
Mae gweithgareddau allgyrsiol a gwirfoddoli yn datblygu unigolion, yn gwella eu cyflogadwyedd, ac yn hyrwyddo ymwneud â’r gymuned.
Mae’r Brifysgol yn caniatáu i’w myfyrwyr ymuno am ddim â’r holl glybiau chwaraeon, cymdeithasau a gweithgareddau gwirfoddoli, waeth beth fo gallu’r myfyriwr i dalu. Ym maes addysgu a dysgu, mae’r Brifysgol yn darparu cwricwlwm deniadol sy’n addas i’r diben gyda rhaglenni academaidd o ansawdd uchel, cyfleusterau addysgu rhagorol ac ystod eang o wasanaethau cefnogi (gan gynnwys cyngor academaidd, ariannol, bugeiliol, ysbrydol a gyrfaoedd). Mae ein rhaglenni’n adlewyrchu ein hymrwymiad i sicrhau bod ein myfyrwyr yn ddinasyddion byd-eang.
Rhagoriaeth Ymchwil
Mae ymchwil arloesol Prifysgol Bangor, sy’n cael ei sbarduno gan effaith, yn mynd i’r afael â rhai o’r cwestiynau mwyaf sy’n wynebu’r byd heddiw. Cydnabu Fframwaith Rhagoriaeth Ymchwil 2021 (a gyhoeddwyd yn 2022) fod 85% o’n hymchwil naill ai gyda’r gorau yn y byd neu’n rhagorol yn rhyngwladol. Mae’r Brifysgol yn y 30 uchaf yn y wlad am effaith gymdeithasol, gan ddangos cyfraniad ein hymchwil i’r byd go iawn.
Rydym yn blaenoriaethu buddsoddiad mewn ymchwil rhyngddisgyblaethol sy’n cydfynd â chynaliadwyedd ac sy’n mynd i’r afael â heriau byd-eang, gan ganolbwyntio ar dair thema allweddol, sef ynni a’r amgylchedd; iechyd, lles ac ymddygiad, ac iaith, diwylliant a chymdeithas. Mae cyfleoedd i wneud astudiaethau ac ymchwil ôl-radd (gan gynnwys darparu efrydiaethau) ar gael ym mhob ysgol academaidd.
Mae’r Brifysgol yn ymgysylltu ag Innovate UK, sef y cyngor cyllido allweddol sy’n rhoi pwyslais ar arloesi dan arweiniad busnes i gefnogi projectau ymchwil cydweithredol sy’n cynnwys partneriaid diwydiannol.
Trwy’r Ganolfan Gydweithio, mae’r Brifysgol hefyd yn darparu mynediad i ystod eang o gyfleoedd cefnogi busnes ac arloesi. Mae hanes llwyddiannus o weithio mewn partneriaeth â busnesau i ddatblygu pobl, cynhyrchion a phrosesau. Gall hyn fod trwy gynlluniau Cyfnewid Gwybodaeth sy’n rhoi mynediad cost effeithiol i fusnesau at yr adnoddau o fewn sylfaen wybodaeth y Brifysgol, sef ei harbenigedd ymchwil.
Cyrhaeddiad Byd-eang
Caiff Prifysgol Bangor ei rhestru ymysg y 200 o’r prifysgolion mwyaf rhyngwladol yn fyd-eang a’r fwyaf rhyngwladol yng Nghymru. Mae’r Brifysgol yn darparu cymuned ryngwladol lewyrchus ac yn estyn croeso i staff a myfyrwyr o fwy na 100 o wledydd ledled y byd, gan ddarparu profiad unigryw Bangor i fyfyrwyr rhyngwladol. Mae’r Brifysgol yn gweithio gyda phartneriaid ledled y byd, gan gynnwys Coleg Bangor yn Tsieina. Caiff cyflogadwyedd a dinasyddiaeth fyd-eang eu cryfhau gan gwricwlwm rhyngwladol y Brifysgol a thrwy hyrwyddo a chefnogi symudedd allanol myfyrwyr. Mae myfyrwyr yn gallu treulio blwyddyn yn cael profiad rhyngwladol, gan astudio neu weithio dramor ac ar y rhan fwyaf o’n cyrsiau israddedig rydym yn cefnogi ein myfyrwyr i fod â rhagor o gymhelliant, yn annibynnol ac yn hyderus ac yn debygol o wella eu cyflogadwyedd.
Amgylchedd Dwyieithog lle mae’r Gymraeg yn ffynnu / Effaith
Economaidd, Gymdeithasol a Dinesig
Mae’r Brifysgol yn arwain ym maes darpariaeth addysg uwch cyfrwng Cymraeg.
Mae’r Brifysgol yn mynd ati i annog myfyrwyr Cymraeg eu hiaith i ddilyn eu cyrsiau trwy gyfrwng y Gymraeg ac yn hyrwyddo defnyddio’r Gymraeg yn y gweithle. Mae’r Brifysgol yn gweithio gyda’r Coleg Cymraeg Cenedlaethol i hyrwyddo astudio mewn Prifysgol trwy gyfrwng y Gymraeg.
Ceir Llyfrgell helaeth ac mae gan yr adran Archifau statws ‘Man Cadw Cofnodion Cyhoeddus’. Rhennir llyfrau a chasgliadau’r Llyfrgell â’r cyhoedd oddi allan i’r Brifysgol trwy gynlluniau megis Linc y Gogledd, sy’n golygu bod adnoddau Llyfrgell y Brifysgol ar gael mewn llyfrgelloedd cyhoeddus lleol yng Ngogledd Cymru.
Yn dilyn anterth y pandemig Covid-19, roedd y Brifysgol yn falch fod modd ailagor Pontio, sef y ganolfan sy’n cynnig cyfuniad cyffrous ac unigryw o gelfyddyd a diwylliant, arloesi, addysg a gweithgareddau cymunedol. Mae Pontio yn cynnwys theatr, theatr stiwdio, sinema, darlithfeydd mawr a chanolfan arloesi, man perfformio awyr agored, yn ogystal â chaffis, bariau a chynteddau sy’n agored i’r cyhoedd. Mae Pontio yn ychwanegu’n sylweddol at y cyfleusterau sydd i’w cael ym Mangor a’r cyffiniau er budd economaidd, cymdeithasol a diwylliannol y Brifysgol a chymuned ehangach Gogledd Cymru.
Yn ogystal, mae’r Brifysgol yn hyrwyddo datblygiadau diwylliannol drwy ei rhaglen o ddarlithoedd cyhoeddus, rhaglen o gerddoriaeth a drama, amgueddfa ac oriel gelf sy’n cynnwys casgliad celf o bwys, a chasgliadau unigryw yn cynnwys cerameg, offerynnau cerdd a sbesimenau o fyd natur.
Mae’r brifysgol hefyd yn darparu dosbarthiadau a chyfleusterau chwaraeon o ansawdd uchel i’r gymuned leol. Mae ystâd y Brifysgol yn cynnwys bron i 150 o adeiladau, yn cynnwys 14 o adeiladau rhestredig - gydag un ohonynt yn adeilad rhestredig gradd 1 sydd o bwysigrwydd hanesyddol.
Ymrwymiad i gynaliadwyedd a’r amgylchedd
Mae’r Brifysgol wedi ymrwymo i ddatblygu cynaliadwy a dinasyddiaeth fyd-eang, gan hyrwyddo cynaliadwyedd ym mhopeth a wnawn gan gynnwys gweithgareddau ymchwil, busnes a menter. Mae ein cymuned academaidd, timau’r Gwasanaethau Proffesiynol a’n myfyrwyr yn helpu i greu byd mwy cynaliadwy. Mae cynaladwyedd yn fwy na’r amgylchedd ac mae ym mhopeth a wnawn. Ein gweledigaeth o ran ymchwil ac effaith yw bod yn ganolfan ragoriaeth fyd-eang mewn cynaliadwyedd, ac mae’r Brifysgol yn ymdrin â chynaliadwyedd mewn modd unigryw a chyfannol sy’n cyd-daro â Deddf Llesiant Cenedlaethau’r Dyfodol (Cymru) 2015 Llywodraeth Cymru a Nodau Datblygu Cynaliadwy’r Cenhedloedd Unedig.
Adlewyrchir ymrwymiad Bangor i gynaliadwyedd yn ei pholisi amgylcheddol, sy’n datgan: “Byddwn nid yn unig yn ceisio diogelu ein hamgylchedd naturiol, ond hefyd yn mynd ati i geisio cyfleoedd i’w wella, gan hyrwyddo diwylliant o fod yn stiwardiaid yr amgylchedd ymysg ein staff a’n myfyrwyr a gweithio tuag at nodau datblygu cynaliadwy.” Rydym wedi cynnal ein System Rheoli Amgylcheddol ISO14001.2015.
Mae’r Brifysgol ymhlith y prifysgolion gorau yn y Deyrnas Unedig am berfformiad amgylcheddol a moesegol yn ôl meini prawf y gynghrair prifysgolion People & Planet gan dderbyn gwobr dosbarth cyntaf yn 2021, gan olygu bod Bangor yn yr 20% uchaf o brifysgolion y Deyrnas Unedig.
Mae’r Brifysgol wedi dangos ei harweinyddiaeth a’i hymrwymiad i gynaliadwyedd drwy benodi’r Dirprwy i’r Is-ganghellor, ar ran y Bwrdd Gweithredol, i gadeirio’r Grŵp Strategaeth Cynaliadwyedd, sy’n goruchwylio esblygiad a gweithrediad dull gweithredu cynaliadwy’r Brifysgol, gan gynnwys y materion y system rheoli amgylcheddol.
Mae bioamrywiaeth yn ffocws arall. Mae gan gynefinoedd ar ein tiroedd werth addysgol, cymdeithasol, diwylliannol, hamdden ac amgylcheddol i fyfyrwyr, staff a’r gymuned ehangach. Mae’r Cynllun Gweithredu Bioamrywiaeth yn ceisio hyrwyddo
bioamrywiaeth ym mhob cynefin ar y campws ac integreiddio bioamrywiaeth yn rhan o’n dulliau gweithredu wrth i ni gynnal ein busnes. Mae’r gwaith estyn allan yng Ngardd Fotaneg Treborth yn parhau.
Ymrwymiad i gynaliadwyedd drwy ein polisi buddsoddi
Mae’r Brifysgol, drwy is-bwyllgor o’r Pwyllgor Cyllid a Strategaeth, wedi cynnal adolygiad blynyddol o’r Polisi Buddsoddi Cynaliadwy sy’n berthnasol i’r cronfeydd gwaddol sy’n cael eu rheoli ar ei rhan gan UBS. Mae’r polisi’n sicrhau bod y Brifysgol yn gwneud y gorau o’i hadenillion buddsoddi heb gyfaddawdu ein hymrwymiad i gynaliadwyedd a llesiant cenedlaethau’r presennol a’r dyfodol. Mae hyn yn golygu cynnal sgrinio cadarnhaol a negyddol ar bob cwmni i weld a ydynt yn cydymffurfio â safonau moesegol a chymdeithasol gyfrifol, gan gynnwys osgoi gweithgareddau sy’n niweidiol i’r amgylchedd neu i les eu gweithlu. Mae eithriadau penodol hefyd ar gyfer meysydd megis arfau, alcohol, gamblo, tybaco ac ati. Nid yw’r Brifysgol yn buddsoddi mewn tanwyddau ffosil echdynnol.
Adroddiad yr archwiliwr annibynnol i Gyngor Prifysgol Bangor
Y flwyddyn yn diweddu 31 Gorffennaf 2022
Adroddiad ar yr archwiliad o’r datganiadau ariannol
Barn
Rydym wedi archwilio datganiadau ariannol Prifysgol Bangor (“y Brifysgol”) am y flwyddyn yn diweddu 31 Gorffennaf 2022 sy’n cynnwys Datganiad o Incwm a Gwariant Cynhwysfawr Cyfunol a Phrifysgol, Datganiad o Newidiadau mewn Cronfeydd wrth Gefn Cyfunol a Phrifysgol, Mantolenni Cyfunol a Phrifysgol, Datganiad Llif Arian Cyfunol a nodiadau cysylltiedig, gan gynnwys y Datganiad Polisïau Cyfrifo.
Yn ein barn ni, mae’r datganiadau ariannol:
yn rhoi darlun gwir a theg o gyflwr materion y Grŵp a’r Brifysgol ar 31 Gorffennaf 2022, ac o incwm a gwariant y Grŵp a’r Brifysgol, enillion a cholledion a newidiadau mewn cronfeydd wrth gefn, ac o lif arian y Grŵp, am y flwyddyn a ddaeth i ben bryd hynny;
wedi cael eu paratoi’n briodol yn unol â safonau cyfrifo’r Deyrnas Unedig, gan gynnwys FRS 102 The Financial Reporting Standard applicable in the UK and Republic of Ireland, a chyda Statement of Recommended Practice – Accounting for Further and Higher Education 2019; ac
wedi cael eu paratoi’n unol â gofynion Deddf Elusennau 2011.
Sail y farn
Penodwyd ni yn archwiliwr o dan Siarterau a Statudau’r Brifysgol ac yn unol ag adran 144 Deddf Elusennau 2011 (neu ei rhagflaenwyr) ac rydym yn adrodd yn unol â rheoliadau a wnaed o dan adran 154 y Ddeddf honno.
Cynhaliom ein harchwiliad yn unol â Safonau Rhyngwladol ar Archwilio (y Deyrnas Unedig) a chyfraith berthnasol. Caiff ein cyfrifoldebau eu disgrifio isod. Rydym wedi cyflawni ein cyfrifoldebau moesegol o dan, ac rydym yn annibynnol ar y grŵp yn unol â, gofynion moesegol y Deyrnas Unedig, gan gynnwys Safon Foesegol y Cyngor Adrodd Ariannol. Credwn fod y dystiolaeth archwilio a gawsom yn sail ddigonol a phriodol i ni roi barn.
Busnes hyfyw
Mae’r Cyngor wedi paratoi’r datganiadau ariannol ar sail busnes hyfyw gan na yw’n bwriadu datod y Grŵp na’r Brifysgol na rhoi’r gorau i weithredu, a gan ei fod wedi dod i’r casgliad bod sefyllfa ariannol y Grŵp a’r Brifysgol yn golygu bod hyn yn realistig. Daeth hefyd i’r casgliad nad oes unrhyw ansicrwydd materol berthnasol a allai fod wedi bwrw amheuaeth sylweddol ar eu gallu i barhau fel busnes hyfyw am o leiaf blwyddyn o ddyddiad cymeradwyo’r datganiadau ariannol (“y cyfnod busnes hyfyw”).
Yn ein gwerthusiad o gasgliadau’r Cyngor, ystyriom y risgiau cynhenid i fodel busnes y Grŵp, a dadansoddi sut y gallai’r risgiau hynny effeithio ar adnoddau ariannol y Grŵp a’r Brifysgol neu ar eu gallu i barhau i weithredu dros y cyfnod busnes hyfyw.
Dyma ein casgliadau yn seiliedig ar y gwaith hwn: rydym o’r farn bod defnydd y Cyngor o sail cyfrifo busnes hyfyw wrth baratoi’r datganiadau ariannol yn briodol;
nid ydym wedi nodi, ac rydym yn cytuno ag asesiad y Cyngor nad oes, ansicrwydd materol berthnasol yn ymwneud â digwyddiadau neu amodau a allai, yn unigol neu ar y cyd, fwrw amheuaeth sylweddol ar allu’r Grŵp neu’r Brifysgol i barhau fel busnes hyfyw ar gyfer y cyfnod busnes hyfyw.
Fodd bynnag, gan na allwn ragfynegi pob digwyddiad neu amod yn y dyfodol ac oherwydd y gall digwyddiadau o’r
fath arwain at ganlyniadau sy’n anghyson â barn a oedd yn rhesymol pan gawsant eu ffurfio, nid yw’r casgliadau
uchod yn gwarantu y bydd y Grŵp neu’r Brifysgol yn parhau i weithredu.
Adroddiad yr archwiliwr annibynnol i Gyngor Prifysgol Bangor (parhad)
Y flwyddyn yn diweddu 31 Gorffennaf 2022
Twyll a thorri deddfau a rheoliadau - y gallu i ganfod
Nodi ac ymateb i risgiau camddatgan materol berthnasol oherwydd twyll
Er mwyn nodi risgiau cam-ddatgan materol berthnasol oherwydd twyll (“risgiau twyll”) gwnaethom asesu digwyddiadau neu amodau a allai ddynodi cymhelliant neu bwysau i gyflawni twyll neu roi cyfle i gyflawni twyll. Roedd ein gweithdrefnau asesu risg yn cynnwys.
Holi’r llywodraethwyr ac archwilio dogfennau polisi ynghylch polisïau a gweithdrefnau lefel uchel y Brifysgol i atal a chanfod twyll, a pholisi datgelu er lles y cyhoedd “chwythu’r chwiban” yn ogystal â gweld a ydynt yn gwybod am unrhyw dwyll gwirioneddol, neu a ydynt yn amau twyll neu’n gwybod am honiadau o dwyll.
Darllen Cofnodion y Bwrdd a’r Pwyllgor Archwilio a Risg.
Defnyddio gweithdrefnau dadansoddol i nodi unrhyw gysylltiadau anarferol neu annisgwyl.
Gwnaethom gyfathrebu’r risgiau twyll a nodwyd trwy’r tîm archwilio a pharhau’n effro i unrhyw arwyddion o dwyll trwy gydol yr archwiliad.
Fel sy’n ofynnol gan safonau archwilio, a chan ystyried pwysau posibl i fodloni cyfamodau benthyca, mae gennym weithdrefnau i fynd i’r afael â’r risg o reolwyr yn diystyru camau rheoli a’r risg o gydnabod refeniw mewn modd twyllodrus, yn enwedig y risg y caiff incwm o gontractau ymchwil ei gofnodi yn y cyfnod anghywir.
Ni wnaethom nodi unrhyw risgiau twyll ychwanegol.
Dilynom weithdrefnau gan gynnwys:
Nodi cofnodion yn y dyddlyfr i’w profi yn seiliedig ar feini prawf risg a chymharu’r cofnodion a nodwyd â dogfennaeth ategol. Roeddent yn cynnwys y rhai hynny a bostiwyd gan uwch reolwyr cyllid, cofnodion dyddlyfr diwedd blwyddyn yn cefnogi balansau Cynllun Pensiwn ac Yswiriant Prifysgol Bangor (BUPAS) a chyfuniadau anarferol rhwng codau refeniw a chodau’r fantolen.
Sampl-brofi incwm ymchwil i asesu a oedd y refeniw hwnnw wedi’i gofnodi yn y cyfnod cywir; ac Asesu amcangyfrifon cyfrifyddu arwyddocaol am duedd.
Nodi ac ymateb i risgiau camddatgan materol berthnasol oherwydd diffyg cydymffurfio â deddfau a rheoliadau
Gwnaethom nodi meysydd o fewn deddfau a rheoliadau y gellid yn rhesymol ddisgwyl iddynt gael effaith faterol berthnasol ar y datganiadau ariannol yn ein profiad masnachol a’n profiad cyffredinol yn y sector, trwy drafod gyda’r rheolwyr (fel sy’n ofynnol yn ôl y safonau archwilio) a thrwy drafod gyda’r rheolwyr y polisïau a’r gweithdrefnau o ran cydymffurfiaeth â deddfau a rheoliadau.
Gan fod y Brifysgol yn cael ei rheoleiddio, roedd ein hasesiad o risgiau’n cynnwys magu dealltwriaeth o’r amgylchedd rheoli gan gynnwys gweithdrefnau’r endid ar gyfer cydymffurfio â gofynion rheoleiddiol.
Gwnaethom gyfathrebu’r deddfau a’r rheoliadau a nodwyd gennym ledled ein tîm a pharhau’n effro i unrhyw arwyddion o ddiffyg cydymffurfio trwy gydol yr archwiliad.
Mae effaith bosibl y deddfau a’r rheoliadau hyn ar y datganiadau ariannol yn amrywio’n sylweddol.
Yn gyntaf, mae’r Grŵp/Prifysgol yn ddarostyngedig i gyfreithiau a rheoliadau sy’n effeithio’n uniongyrchol ar y datganiadau ariannol gan gynnwys deddfwriaeth adrodd ariannol, deddfwriaeth trethiant, deddfwriaeth pensiynau a datgeliadau penodol sy’n ofynnol yn ôl deddfwriaeth a rheoliadau addysg uwch / addysg a sgiliau ôl-16, deddfwriaeth elusennau a deddfwriaeth gysylltiedig ac asesom hyd a lled y cydymffurfio â’r deddfau a’r rheoliadau hyn fel rhan o’n gweithdrefnau ar eitemau cysylltiedig y datganiad ariannol.
Yn ail, mae’r Grŵp/Prifysgol yn ddarostyngedig i lawer o gyfreithiau a rheoliadau eraill lle gallai canlyniadau diffyg cydymffurfiaeth gael effaith sylweddol ar symiau neu ddatgeliadau yn y datganiadau ariannol, er enghraifft trwy
Adroddiad yr archwiliwr annibynnol i Gyngor Prifysgol Bangor (parhad)
Y flwyddyn yn diweddu 31 Gorffennaf 2022
orfodi dirwyon neu ymgyfreitha neu’r angen i gynnwys darpariaethau sylweddol. Nodwyd y meysydd canlynol gennym fel y rhai sydd fwyaf tebygol o gael effaith o’r fath: cydymffurfio â gofynion rheoleiddiol Addysg Uwch HEFCW, gan gydnabod natur reoleiddiedig gweithgareddau’r Brifysgol.
Mae safonau archwilio yn cyfyngu’r gweithdrefnau archwilio sy’n ofynnol i nodi diffyg cydymffurfiaeth â’r deddfau a’r rheoliadau hyn i ymchwiliad llywodraethwyr a rheolwyr eraill ac archwilio gohebiaeth reoleiddiol a chyfreithiol, os o gwbl. Felly, os na chaiff achos o dorri rheoliadau gweithredol ei ddatgelu i ni neu os nad yw’n amlwg o ohebiaeth berthnasol, ni fydd archwiliad yn canfod y methiant hwnnw.
Cyd-destun gallu’r archwiliad i ganfod twyll neu dor-cyfraith neu dor-rheoliad
Oherwydd cyfyngiadau cynhenid archwiliad, mae risg anochel na fyddwn wedi canfod rhai camddatganiadau materol berthnasol yn y datganiadau ariannol, er ein bod wedi cynllunio a pherfformio ein harchwiliad yn unol â’r safonau archwilio. Er enghraifft, po bellaf yw’r diffyg cydymffurfiaeth â deddfau a rheoliadau oddi wrth y digwyddiadau a’r trafodion a adlewyrchir yn y datganiadau ariannol, y lleiaf tebygol yw’r gweithdrefnau cynhenid gyfyngedig a wneir yn ofynnol gan y safonau archwilio o’u canfod.
Yn ogystal, fel gydag unrhyw archwiliad, roedd risg uwch o beidio â chanfod twyll, gan y gallai hynny gynnwys cydgynllwynio, ffugio, hepgor bwriadol, camliwio, neu ddiystyru camau rheoli mewnol. Dyluniwyd ein gweithdrefnau archwilio i ganfod camddatganiadau materol berthnasol. Nid ydym yn gyfrifol am atal diffyg cydymffurfiaeth neu dwyll ac ni ellir disgwyl i ni ganfod diffyg cydymffurfiaeth yn achos pob deddf a rheoliad.
Gwybodaeth bellach
Y Cyngor (y mae ei aelodau yn Ymddiriedolwyr y Brifysgol at ddibenion cyfraith elusennau) sy’n gyfrifol am weddill yr wybodaeth, sef yr Adolygiad Strategol a’r Datganiad Budd Cyhoeddus, a’r Datganiadau Llywodraethu Corfforaethol a Chyfrifoldebau’r Cyngor. Nid yw ein barn ar y datganiadau ariannol yn ymwneud â gweddill yr wybodaeth ac felly nid ydym yn mynegi barn archwilio nac yn dod i unrhyw fath o gasgliad sicrwydd am yr wybodaeth honno, ac eithrio fel y nodir yn benodol isod.
Ein cyfrifoldeb ni yw darllen gweddill yr wybodaeth ac, wrth wneud hynny, ystyried a yw’r wybodaeth ynddi, yn seiliedig ar ein gwaith yn archwilio’r datganiadau ariannol, yn gamddatganiad materol berthnasol neu’n anghyson
â’r datganiadau ariannol neu ein gwybodaeth archwilio. Mae’n ofynnol i ni roi gwybod i chi:
yn seiliedig ar y gwaith hwnnw yn unig, os ydym wedi nodi unrhyw gamddatganiadau materol berthnasol yng ngweddill yr wybodaeth; neu
yn ein barn ni bod yr wybodaeth a roddwyd yn yr Adolygiad Strategol yn anghyson mewn unrhyw ffordd faterol berthnasol â’r datganiadau ariannol.
Nid oes gennym unrhyw beth i’w adrodd yn y cyswllt hwn.
Materion y mae angen i ni adrodd arnynt drwy eithriad
O dan Ddeddf Elusennau 2011 mae’n ofynnol i ni adrodd i chi os, yn ein barn ni: nad yw’r elusen wedi bod yn cadw cofnodion cyfrifo digonol; neu os nad yw’r datganiadau ariannol yn cytuno â’r cofnodion cyfrifo; neu
Nid ydym wedi derbyn yr holl wybodaeth a’r esboniadau y mae arnom eu hangen ar gyfer ein harchwiliad.
Nid oes gennym unrhyw beth i’w adrodd yn y cyswllt hwn.
Cyfrifoldebau’r Cyngor
Fel yr esboniwyd yn llawnach yn y datganiad a nodir ar dudalen 51, mae’r Cyngor yn gyfrifol am y canlynol: paratoi’r datganiadau ariannol sy’n rhoi golwg wir a theg; camau rheoli mewnol fel sy’n angenrheidiol ym marn y Cyngor i alluogi paratoi datganiadau ariannol lle na cheir unrhyw gamddatganiad materol berthnasol, boed hynny oherwydd twyll neu wall; asesu gallu’r Grŵp a’r rhiant-brifysgol i barhau fel busnes hyfyw, gan ddatgelu, fel sy’n
Adroddiad yr archwiliwr annibynnol i Gyngor Prifysgol Bangor (parhad)
Y flwyddyn yn diweddu 31 Gorffennaf 2022
berthnasol, faterion sy’n gysylltiedig â bod yn fusnes hyfyw; a defnyddio sail cyfrifo busnes hyfyw oni bai ei fod naill ai’n bwriadu datod y Grŵp neu’r rhiant-brifysgol neu roi’r gorau i weithredu, neu bod dim dewis arall realistig ond gwneud hynny.
Cyfrifoldebau’r Archwiliwr
Ein hamcanion yw cael sicrwydd rhesymol na cheir yn y datganiadau ariannol, drwodd a thro, gamddatganiad materol berthnasol, boed hynny oherwydd twyll neu wall, ac i gyflwyno ein barn mewn adroddiad archwiliwr. Mae sicrwydd rhesymol yn lefel uchel o sicrwydd, ond nid yw’n gwarantu y bydd archwiliad a gynhelir yn unol â Safonau Rhyngwladol ar Archwilio (y Deyrnas Unedig) bob amser yn canfod camddatganiad materol berthnasol pan fo un yn bodoli. Gall camddatganiadau godi o ganlyniad i dwyll neu wall ac fe’u hystyrir yn faterol berthnasol os gellid disgwyl yn rhesymol iddynt, yn unigol neu’n yn gyfun, ddylanwadu ar benderfyniadau economaidd defnyddwyr a wnaed yn seiliedig ar y datganiadau ariannol.
Ceir disgrifiad llawnach o’n cyfrifoldebau ar wefan yr FRC yn: www.frc.org.uk/auditorsresponsibilities
Adroddiad ar ofynion cyfreithiol a rheoleiddio eraill
Mae’n ofynnol i ni adrodd ar y materion canlynol a ragnodir yng Nghod Ymarfer Archwilio Cyngor Cyllido Addysg Uwch Cymru (‘HEFCW’) a gyhoeddwyd o dan Ddeddf Addysg Bellach ac Uwch 1992 ac yn y Cod Rheoli Ariannol a gyhoeddwyd o dan Ddeddf Addysg Uwch (Cymru) 2015 a Cyfarwyddyd i Sefydliadau Addysg Uwch ynglŷn â’u Cyfrifon 2021/22 a gyhoeddwyd gan HEFCW (“Cyfarwyddyd Cyfrifon”).
Yn ein barn ni, ym mhob ffordd faterol:
mae arian o ba ffynhonnell bynnag a weinyddir gan y Grŵp neu’r Brifysgol at ddibenion penodol wedi’u defnyddio’n briodol at y dibenion hynny ac wedi’u rheoli’n unol â deddfwriaeth berthnasol; mae incwm, lle bo’n briodol, wedi’i gymhwyso yn unol â pharagraff 145 o God Rheolaeth Ariannol HEFCW; Mae grantiau’r Cyngor Cyllido wedi’u cymhwyso yn unol â’r telerau a’r amodau sydd ynghlwm wrthynt a’u defnyddio at y dibenion y cawsant eu derbyn, gan gynnwys y Telerau a’r Amodau Cyllido; mae gofynion Cyfarwyddyd Cyfrifon HEFCW wedi’u bodloni.
Diben ein gwaith archwilio ac i bwy y mae ein cyfrifoldebau ni yn ddyledus
Llunnir yr adroddiad hwn i’r Cyngor yn unig, yn unol ag Erthygl 12(ii) o Siartrau a Statudau’r Brifysgol ac yn unol ag adran 144 o Ddeddf Elusennau 2011 (neu ei rhagflaenwyr) a rheoliadau a wnaed o dan adran 154 y Ddeddf honno. Gwnaed ein gwaith archwilio er mwyn i ni gael datgan y materion hynny y mae angen i ni eu datgan wrth y Cyngor mewn adroddiad archwiliwr ac i ddim diben arall. Hyd yr eithaf a ganiateir gan y gyfraith, nid ydym yn derbyn nac yn cymryd cyfrifoldeb dros unrhyw un heblaw’r Brifysgol a’r Cyngor am ein gwaith archwilio, am yr adroddiad hwn, neu am y farn y daethom iddi.
Timothy Cutler
dros ac ar ran KPMG LLP, Archwiliwr Statudol Cyfrifwyr Siartredig
1 St Peter’s Square Manceinion
M2 3AE
01 Rhagfyr 2022
Datganiad o gyfrifoldebau’r Cyngor mewn perthynas â’r Adroddiad
Blynyddol a’r Datganiadau Ariannol
Y flwyddyn yn diweddu 31 Gorffennaf 2022
Mae’r Cyngor yn gyfrifol am baratoi’r Adroddiad Blynyddol a’r datganiadau ariannol yn unol â gofynion y Telerau a’r Amodau Cyllido a gyhoeddwyd gan Gyngor Cyllido Addysg Uwch Cymru (HEFCW), y Cyfarwyddyd i Sefydliadau Addysg Uwch ynglŷn â’u Cyfrifon 2021/22 a gyhoeddwyd gan HEFCW, y Cod Rheolaeth Ariannol a gyhoeddwyd o dan Ddeddf Addysg Uwch (Cymru) 2015 a chyfraith a rheoliadau cymwys.
Mae’n ofynnol iddo baratoi datganiadau ariannol ar gyfer y Grŵp a’r rhiant-brifysgol yn unol â safonau cyfrifo’r Deyrnas Unedig a chyfraith berthnasol (yr arferion cyfrifo a dderbynnir yn gyffredinol yn y Deyrnas Unedig), gan gynnwys FRS 102 The Financial Reporting Standard applicable in the UK and Republic of Ireland a gofynion Deddf Elusennau 2011. Mae’r Telerau a’r Amodau Cyllido yn ei gwneud yn ofynnol bod y datganiadau ariannol yn cael eu paratoi’n unol â Datganiad o’r Arfer a Argymhellir – Cyfrifo ar gyfer Addysg Bellach ac Addysg Uwch 2019, yn unol â gofynion y Cyfarwyddyd i Sefydliadau Addysg Uwch ynglŷn â’u Cyfrifon ar gyfer 2021/22 a gyhoeddwyd gan HEFCW.
Mae’n ofynnol i’r Cyngor baratoi datganiadau ariannol sy’n rhoi darlun cywir a theg o sefyllfa’r Grŵp a’r rhiantbrifysgol ac o’u hincwm a’u gwariant, enillion a cholledion a newidiadau mewn cronfeydd wrth gefn ar gyfer y cyfnod hwnnw. Wrth baratoi pob un o ddatganiadau ariannol y Grŵp a’r rhiant-brifysgol, mae’n ofynnol i’r cyfarwyddwyr wneud y canlynol:
dewis polisïau cyfrifo addas, ac yna’u defnyddio’n gyson; dod i farn ac amcangyfrif mewn modd sy’n rhesymol a doeth;
datgan a yw safonau cyfrifo perthnasol y Deyrnas Unedig wedi’u dilyn a’r Datganiad o’r Arfer a Argymhellir, yn amodol ar unrhyw wyriadau materol berthnasol a ddatgelwyd ac a esboniwyd yn y datganiadau ariannol;
asesu gallu’r Grŵp a’r rhiant-brifysgol i barhau fel busnes hyfyw, gan ddatgelu, fel y bo’n berthnasol, faterion sy’n ymwneud â busnes hyfyw; a defnyddio sail cyfrifo busnes hyfyw oni bai ei fod naill ai’n bwriadu datod y Grŵp neu’r rhiant-brifysgol neu roi’r gorau i weithredu, neu nad oes ganddynt unrhyw ddewis realistig arall ond gwneud hynny.
Mae’r Cyngor yn gyfrifol am gadw cofnodion cyfrifo sy’n ddigonol i ddangos ac esbonio trafodion y rhiantbrifysgol a datgelu gyda chywirdeb rhesymol ar unrhyw adeg sefyllfa ariannol y rhiant-brifysgol. Y Cyngor sy’n gyfrifol am unrhyw gamau rheoli mewnol sy’n angenrheidiol ym marn y Cyngor i alluogi paratoi datganiadau ariannol lle na cheir camddatganiad materol berthnasol, boed hynny oherwydd twyll neu wall, ac yn gyfrifol yn gyffredinol dros gymryd unrhyw gamau sy’n rhesymol agored iddo i ddiogelu asedau’r Grŵp ac i atal a chanfod twyll ac unrhyw anghysondebau eraill.
Datganiad o gyfrifoldebau’r Cyngor mewn perthynas â’r Adroddiad
Blynyddol a’r Datganiadau Ariannol
Y flwyddyn yn diweddu 31 Gorffennaf 2022
Mae’r Cyngor hefyd yn gyfrifol am sicrhau’r canlynol: mae arian o ba ffynhonnell bynnag a weinyddir gan y Grŵp neu’r Brifysgol at ddibenion penodol wedi’u defnyddio’n briodol at y dibenion hynny ac wedi’u rheoli’n unol â deddfwriaeth berthnasol; mae incwm, lle bo’n briodol, wedi’i gymhwyso yn unol â pharagraff 145 o God Rheolaeth Ariannol HEFCW; mae grantiau’r Cyngor Cyllido wedi’u cymhwyso yn unol â’r telerau a’r amodau sydd ynghlwm wrthynt a’u defnyddio at y dibenion y cawsant eu derbyn, gan gynnwys y Telerau a’r Amodau Cyllido; sicrhau fod camau rheoli ariannol priodol ar waith i ddiogelu arian cyhoeddus ac arian o ffynonellau eraill; sicrhau rheolaeth ddarbodus, effeithlon ac effeithiol dros adnoddau a gwariant y Brifysgol.
Mae’r Cyngor yn gyfrifol am gynnal yr wybodaeth gorfforaethol ac ariannol a geir ar wefan y Brifysgol ac am ei chywirdeb. Gall deddfwriaeth yn y Deyrnas Unedig yn ymwneud â pharatoi a dosbarthu datganiadau ariannol fod yn wahanol i ddeddfwriaeth mewn awdurdodaethau eraill.
Mae holl eitemau cyfanswm incwm a gwariant cynhwysfawr yn ymwneud â gweithgareddau sy’n parhau.
Mae’r Datganiad Polisïau Cyfrifo a’r Nodiadau ar dudalennau 102 i 136 yn rhan o’r datganiadau ariannol.
o Newidiadau mewn Cronfeydd wrth Gefn Cyfunol a Phrifysgol Y flwyddyn yn diweddu 31 Gorffennaf
Mae’r Datganiad Polisïau Cyfrifo a’r Nodiadau ar dudalennau 102 i 136 yn rhan o’r datganiadau ariannol.

Tachwedd 2022 a chawsant eu llofnodi ar ei ran ar 30 Tachwedd gan:
Cymeradwywyd y datganiadau ariannol gan y Cyngor ar 28
Yr Athro Edmund Burke

Yr Is-ganghellor
Mrs Marian Wyn Jones Cadeirydd y Cyngor

Syr Paul Lambert Cadeirydd y Pwyllgor Cyllid a Strategaeth
Mae’r Datganiad Polisïau Cyfrifo a’r Nodiadau ar dudalennau 102 i 136 yn rhan o’r
1. Gwybodaeth gyffredinol
Mae Prifysgol Bangor wedi ei chofrestru gyda’r Comisiwn Elusennau (rhif 1141565). Cyfeiriad y swyddfa gofrestredig yw Prifysgol Bangor, Ffordd y Coleg, Bangor, Gwynedd, LL57 2DG.
2. Sail paratoi
Paratowyd y datganiadau ariannol Cyfunol a Phrifysgol yn unol â Safonau Cyfrifeg y Deyrnas Unedig, gan gynnwys Safon Adrodd Ariannol 102 (FRS 102) a Datganiad o’r Arfer a Argymhellir (SORP): Cyfrifo ar gyfer Addysg Bellach ac Addysg Uwch a gyhoeddwyd yn 2019. Fe’u paratowyd hefyd yn unol â phwerau a dyletswyddau a ‘ddygwyd ymlaen’ o ddeddfwriaeth flaenorol (Deddf Addysg Bellach ac Uwch 1992 a Deddf Addysg Uwch 2004) a phwerau newydd Deddf Addysg Uwch ac Ymchwil 2017 yn ystod y cyfnod trosglwyddo hyd 31 Gorffennaf 2022, y Siarter Frenhinol a’r Cyfarwyddyd ynghylch Cyfrifon a gyhoeddwyd gan Gyngor Cyllido Addysg Uwch Cymru (HEFCW).
Mae’r Brifysgol yn endid budd cyhoeddus ac felly mae wedi gweithredu gofynion budd cyhoeddus perthnasol deddfau a safonau cyfrifeg y Deyrnas Unedig.
Paratowyd y datganiadau ariannol Cyfunol a Phrifysgol o dan y confensiwn cost hanesyddol (a addaswyd trwy ailbrisio rhai asedau a rhwymedigaethau ariannol ar werth teg).
Paratoir y datganiadau ariannol mewn sterling sef arian cyfred gweithredol y grŵp a chaiff y symiau eu talgrynnu i’r £’000 agosaf.
3. Eithriadau o dan FRS 102
Mae’r Brifysgol wedi manteisio ar yr eithriad a geir o dan adran 3.3 SORP (1.12(b) yn FRS 102) i beidio â chynhyrchu datganiad llif arian ar gyfer y Brifysgol yn ei datganiadau ariannol ar wahân.
4. Sail cyfuno
Mae’r datganiadau ariannol cyfunol yn cynnwys datganiadau ariannol y Brifysgol a’i holl is-gwmnïau ynghyd â chyfran canlyniadau mentrau ar y cyd a chwmnïau cysylltiedig ar gyfer y flwyddyn ariannol hyd at 31 Gorffennaf 2022.
Mae canlyniadau is-gwmnïau a gafodd eu caffael neu eu gwaredu yn ystod y cyfnod wedi eu cynnwys yn y datganiad cyfunol o incwm cynhwysfawr o’r dyddiad caffael neu hyd at y dyddiad gwaredu. Caiff trafodion rhyng-grŵp eu dileu pan gânt eu cyfuno.
Mae enillion neu golledion ar unrhyw drafodion rhyng-grŵp yn cael eu dileu yn llawn. Mae symiau mewn perthynas â dyledion a hawliadau rhwng ymgymeriadau sydd wedi’u cynnwys wrth gyfuno hefyd yn cael eu dileu. Ni chaiff balansau rhwng y Brifysgol a’i chwmnïau cysylltiedig a’i mentrau ar y cyd eu dileu. Mae trafodion masnachu arferol nad ydynt wedi’u setlo erbyn dyddiad y fantolen yn cael eu cynnwys fel asedau neu rwymedigaethau cyfredol. Mae unrhyw enillion neu golledion wedi’u cynnwys yn swm cario asedau’r naill endid neu’r llall, a chaiff y rhan sy’n ymwneud â chyfran y Brifysgol ei dileu.
Nid yw’r datganiadau ariannol cyfunol yn cynnwys Undeb y Myfyrwyr gan nad oes gan y Brifysgol reolaeth na dylanwad llywodraethol dros benderfyniadau polisi.
Defnyddir y dull ecwiti i roi cyfrif am fentrau ar y cyd.
5. Busnes Hyfyw
Mae gweithgareddau’r Grŵp a’r Brifysgol, ynghyd â’r ffactorau sy’n debygol o effeithio ar ei ddatblygiad, ei berfformiad a’i safle yn y dyfodol, wedi’u nodi yn yr Adolygiad Strategol sy’n rhan o’r Adolygiad Blynyddol.
Mae’r Adolygiad Blynyddol hefyd yn disgrifio sefyllfa ariannol y sefydliad, ei lif arian, ei sefyllfa hylifedd a’i gyfleusterau benthyca.
Mae’r Grŵp a’r Brifysgol yn cyflawni ei ofynion o ran cyfalaf gweithio o ddydd i ddydd drwy falansau arian parod anghyfyngedig presennol, sy’n ddigonol i gwrdd â rhwymedigaethau fel y dônt yn ddyledus hyd y gellir rhagweld. Mae’r Cyngor wedi paratoi rhagolygon manwl am lif arian ar gyfer 2022/23 a 23/24. Ar ôl adolygu’r rhagolygon hyn, mae’r Cyngor o’r farn, o ystyried risgiau anfantais difrifol ond credadwy, gan gynnwys effaith
Y flwyddyn yn diweddu 31 Gorffennaf 2022
bosibl y pandemig, y bydd gan y Grŵp a’r Brifysgol ddigon o arian i gyflawni eu rhwymedigaethau wrth iddynt ddod yn ddyledus dros gyfnod o 12 mis o leiaf o ddyddiad cymeradwyo’r datganiadau ariannol (y cyfnod asesu busnes hyfyw).
Lleihaodd effaith y pandemig coronafeirws ar y Brifysgol yn ystod y flwyddyn hyd at 31 Gorffennaf 2022, yn weithredol ac yn ariannol. Amcangyfrifir y bydd y Brifysgol yn parhau i gael ei heffeithio yn y blynyddoedd i ddod. Mewn ymateb, mae’r Brifysgol yn parhau i reoli ei chostau a’i phrojectau gwariant cyfalaf yn ofalus.
Er bod y sefyllfa’n esblygu’n gyson gan wneud cynllunio senarios yn anodd, asesodd y Brifysgol nifer o senarios a oedd yn amcangyfrif effeithiau ariannol amrywiol y pandemig ar nifer o feysydd, yn enwedig niferoedd myfyrwyr a chynhyrchu incwm ffioedd ynghyd ag incwm neuaddau ac incwm masnachol.
Mae gan y Brifysgol Gyllideb ar gyfer 2022/23 yn seiliedig ar y sefyllfa o ran recriwtio myfyrwyr, ynghyd â rheolaeth dros wariant cyfalaf i gynnal hylifedd. Nid oes gan y Brifysgol unrhyw gynlluniau i gynyddu lefel ei chyfleusterau cyllido, ac eithrio’r rhai sy’n gysylltiedig â chynlluniau cymorth y llywodraeth lle bo hynny’n briodol, y tu hwnt i’r rhai hynny oedd ar waith ar 31 Gorffennaf 2022 yn ystod y cyfnod asesu busnes hyfyw. Ni thorrwyd unrhyw gyfamodau bancio ac ni ragwelir y bydd hynny’n digwydd yn ystod y cyfnod asesu busnes hyfyw. Asesodd y Brifysgol nifer o senarios gan amcangyfrif yr effeithiau ariannol amrywiol, yn enwedig niferoedd myfyrwyr a chynhyrchu incwm ffioedd ynghyd ag incwm neuaddau ac incwm masnachol.
O ganlyniad i’r adolygiad hwn, mae’r Cyngor o’r farn bod y Grŵp a’r rhiant-Brifysgol yn gallu rheoli ei risgiau cyllid a’i risgiau busnes ac yn parhau i gyflawni ei rhwymedigaethau wrth iddynt ddod yn ddyledus am o leiaf 12 mis o ddyddiad cymeradwyo’r datganiadau ariannol ac felly paratowyd datganiadau ariannol ar sail busnes hyfyw.
6. Cydnabod incwm
Caiff incwm o werthiant nwyddau neu wasanaethau ei gredydu i’r Datganiad o Incwm a Gwariant Cynhwysfawr Cyfunol pan gaiff y nwyddau neu’r gwasanaethau eu cyflenwi i’r cwsmeriaid allanol neu pan fo telerau’r contract wedi cael eu bodloni.
Caiff incwm ffioedd ei ddatgan fel ffigwr gros o unrhyw wariant nad yw’n ddisgownt a’i gredydu i’r Datganiad o Incwm a Gwariant Cynhwysfawr Cyfunol dros y cyfnod y mae’r myfyrwyr yn astudio. Lle mae swm y ffioedd dysgu wedi ei ostwng, er enghraifft, drwy ddisgownt am dalu’n brydlon neu ffurf arall ar hepgoriad, dangosir yr incwm a dderbynnir fel ffigwr net o unrhyw ostyngiadau o’r fath. Mae taliadau bwrsariaethau ac ysgoloriaethau wedi eu cyfrifo’n gros fel gwariant ac nid ydynt wedi’u didynnu o incwm.
Caiff incwm buddsoddi ei gredydu i’r datganiad incwm a gwariant ar sail dderbyniadwy.
Nid yw cyllid y mae’r Brifysgol yn ei dderbyn a’i alldalu fel asiant talu ar ran corff cyllido wedi ei gynnwys yn incwm a gwariant y Brifysgol lle nad oes fawr ddim risg na budd economaidd i’r Brifysgol mewn perthynas â’r trafodyn.
Cyllid grant
Caiff cyllid grant yn cynnwys grant bloc gan gyngor cyllido, grantiau ymchwil o ffynonellau llywodraeth a grantiau (yn cynnwys grantiau ymchwil) o ffynonellau anllywodraethol eu cydnabod fel incwm lle mae gan y Brifysgol hawl i’r incwm a lle mae amodau’n ymwneud â pherfformiad wedi cael eu cyflawni. Caiff incwm a dderbynnir ymlaen llaw cyn cyflawni amodau’n ymwneud â pherfformiad ei gydnabod fel incwm gohiriedig o fewn credydwyr ar y fantolen a’i ryddhau i incwm wrth i’r amodau gael eu cyflawni.
Rhoddion a gwaddolion
Mae trafodion digyfnewid nad oes iddynt amodau’n ymwneud â pherfformiad yn rhoddion a gwaddolion.
Caiff rhoddion a gwaddolion sydd â chyfyngiadau gan y rhoddwr yn gysylltiedig â nhw eu cydnabod mewn incwm pan fo gan y Brifysgol hawl i’r cyllid. Cedwir yr incwm o fewn y gronfa gyfyngedig hyd nes caiff ei ddefnyddio yn unol â’r cyfryw gyfyngiadau pryd y caiff yr incwm ei ryddhau drwy drosglwyddiad i gronfeydd cyffredinol.
yn diweddu 31 Gorffennaf 2022
Caiff rhoddion heb gyfyngiadau eu cydnabod mewn incwm pan fo gan y Brifysgol hawl i’r cyllid. Cofnodir incwm buddsoddi ac adbrisiant gwaddolion mewn incwm yn y flwyddyn pan mae’n codi naill ai fel incwm cyfyngedig neu anghyfyngedig yn unol â thelerau’r gronfa waddol unigol. Ceir pedwar prif fath o roddion a gwaddolion o fewn cronfeydd:
1. Rhoddion cyfyngedig - mae’r rhoddwr wedi pennu bod rhaid defnyddio’r rhodd ar gyfer amcan neilltuol.
2. Gwaddolion parhaol anghyfyngedig - mae’r rhoddwr wedi pennu bod y cyllid i’w fuddsoddi’n barhaol i gynhyrchu ffrwd incwm er budd cyffredinol y Brifysgol.
3. Gwaddolion gwariadwy cyfyngedig - mae’r rhoddwr wedi pennu amcan neilltuol ac eithrio prynu neu adeiladu asedion diriaethol sefydlog, ac mae gan y Brifysgol rym i ddefnyddio’r cyfalaf.
4. Gwaddolion parhaol cyfyngedig - mae’r rhoddwr wedi pennu bod y cyllid i’w fuddsoddi’n barhaol i gynhyrchu ffrwd incwm i’w defnyddio ar gyfer amcan neilltuol.
Grantiau cyfalaf
Caiff grantiau cyfalaf eu cydnabod mewn incwm pan fo gan y Brifysgol hawl i’r cyllid yn amodol ar gyflawni unrhyw amodau’n ymwneud â pherfformiad.
7. Cyfrifo buddion ymddeol
Y ddau brif gynllun pensiwn i staff y Brifysgol yw Cynllun Pensiwn y Prifysgolion (USS) a Chynllun Pensiwn ac Yswiriant Prifysgol Bangor 1978 (BUPAS). Mae’r cynlluniau’n gynlluniau â buddion wedi’u diffinio a gyllidir yn allanol ac sydd wedi eu contractio allan o Ail Gynllun Pensiwn y Wladwriaeth (S2P).
Caiff y ddwy gronfa eu prisio bob tair blynedd gan actiwariaid annibynnol gyda chymwysterau proffesiynol.
Cynllun aml-gyflogwr â buddion wedi’u diffinio yw’r USS ac nid yw’n bosibl nodi’r asedau a’r rhwymedigaethau yn ôl y prifysgolion sy’n aelodau oherwydd natur gydfuddiannol y cynllun ac felly cyfrifir y cynllun hwn fel cynllun buddion ymddeol â chyfraniadau wedi’u diffinio. Cofnodir rhwymedigaeth o fewn y darpariaethau ar gyfer unrhyw ymrwymiad contract i ariannu diffygion yn y gorffennol yng nghynllun yr USS.
Cynllun â Chyfraniadau wedi’u Diffinio
Cynllun buddion ôl-gyflogaeth yw cynllun â chyfraniadau wedi’u diffinio lle mae’r Brifysgol yn talu cyfraniadau sefydlog i endid ar wahân ac ni fydd unrhyw rwymedigaeth gyfreithiol na thrwy ddehongliad arno i dalu symiau pellach. Caiff rhwymedigaethau am gyfraniadau i gynlluniau pensiwn â chyfraniadau wedi’u diffinio eu cydnabod fel traul yn y datganiad incwm yn y cyfnodau pryd y rhoddwyd gwasanaethau gan weithwyr.
Cynlluniau aml-gyflogwr
Pan na all y Brifysgol nodi ei chyfran o’r asedau a’r rhwymedigaethau sylfaenol mewn cynllun aml-gyflogwr ar sail resymol a chyson, bydd yn cyfrifo fel pe bai’r cynllun yn gynllun â chyfraniadau wedi’u diffinio. Pan fo’r Brifysgol wedi mynd i gytundeb â chynllun aml-gyflogwr o’r fath sy’n pennu sut y bydd y Brifysgol yn cyfrannu at gynllun adfer diffyg, mae’r Brifysgol yn cydnabod ei rhwymedigaeth dros y cyfraniadau sy’n daladwy sy’n deillio o’r cytundeb, i’r graddau y maent yn ymwneud â’r diffyg, a chaiff y draul o ganlyniad i hynny ei chydnabod fel gwariant.
Cynlluniau â buddion wedi’u diffinio
Cynllun buddion ôl-gyflogaeth nad yw’n gynllun â chyfraniadau wedi’u diffinio yw cynllun â buddion wedi’u diffinio. Dan gynlluniau â buddion wedi’u diffinio, rhwymedigaeth y Brifysgol yw darparu’r buddion y cytunwyd arnynt i weithwyr presennol ac i gyn-weithwyr, ac mae’r risg actiwaraidd (y bydd y buddion yn costio mwy neu lai nag a ddisgwyliwyd) a’r risg buddsoddi (y bydd adenillion ar asedau a neilltuwyd i gyllido’r buddion yn wahanol i’r hyn a ddisgwyliwyd) yn cael eu dwyn, yn eu hanfod, gan y Brifysgol.
Cydnabyddir y rhwymedigaeth net yn y fantolen mewn perthynas â phob cynllun a dyma werth presennol y rhwymedigaeth ar gyfer buddion wedi’u diffinio ar y dyddiad adrodd llai gwerth teg asedau’r cynllun ar y dyddiad adrodd.
Dylai’r Grŵp gydnabod rhwymedigaeth am ei ymrwymiadau dan gynlluniau â buddion wedi’u diffinio yn net o asedau’r cynllun. Caiff y rhwymedigaeth hon am fuddion net wedi’u diffinio ei mesur fel amcangyfrif o swm y buddion y mae gweithwyr wedi ei ennill yn gyfnewid am eu gwasanaeth yn y cyfnod cyfredol ac mewn cyfnodau blaenorol, wedi’i ddisgowntio i bennu ei werth presennol, llai gwerth teg asedau’r cynllun (ar bris bidio).
Gwneir y cyfrifiad hwn gan actiwari cymwysedig yn defnyddio’r dull rhagamcanu unedau credyd. O dan adran 28.22 (Buddion Gweithwyr - ased cynllun â buddion wedi’u diffinio) yn FRS 102 nid yw’r Brifysgol yn cydnabod gwarged y cynllun gan nad yw’n gallu adennill y gwarged trwy gyfraniadau is yn y dyfodol na thrwy ad-daliadau o’r cynllun. Mae darpariaeth yn y Weithred Ymddiriedolaeth i’r Brifysgol, yn unochrog, ddirwyn Cynllun Pensiwn ac Yswiriant Prifysgol Bangor i ben, ac os digwydd hynny bod unrhyw symiau gweddilliol ar ôl setlo holl rwymedigaethau’r cynllun yn cael eu had-dalu i’r Brifysgol. O ganlyniad, mae’r Brifysgol wedi penderfynu bod ganddi hawl ddiamod i gael ad-daliad wrth ddirwyn i ben. Fodd bynnag, mae darpariaeth yn y Weithred Ymddiriedolaeth hefyd i Ymddiriedolwyr y Gronfa drosglwyddo polisïau blwydd-dal i enwau aelodau unigol heb fod angen cydsyniad y Brifysgol. Oherwydd bodolaeth yr hawliau hynny i Ymddiriedolwyr y Gronfa, mae’r Brifysgol o’r farn ei bod yn briodol peidio â chydnabod y gwarged o fewn y datganiadau ariannol mewn perthynas â’r Gronfa Bensiwn.
Bob blwyddyn mae’r Brifysgol yn cyflogi actiwariaid annibynnol i gyfrifo’r rhwymedigaeth ar gyfer pob cynllun. Pennir y gwerth presennol trwy ddisgowntio taliadau amcangyfrifedig yn y dyfodol ar gyfradd ddisgowntio sy’n seiliedig ar gynnyrch y farchnad ar fondiau corfforaethol ansawdd uchel mewn sterling sydd â thelerau sy’n cyfateb i gyfnod amcangyfrifedig y taliadau yn y dyfodol.
Caiff gwerth teg asedau cynllun ei fesur yn unol â hierarchaeth gwerth teg FRS 102 ac yn unol â pholisi’r Brifysgol ar gyfer asedau tebyg. Mae hyn yn cynnwys defnyddio technegau prisio priodol.
Caiff enillion a cholledion actiwaraidd sy’n deillio o addasiadau profiad a newidiadau i dybiaethau actiwaraidd eu codi neu eu credydu i incwm cynhwysfawr arall. Caiff y symiau hyn ynghyd â’r adenillion ar asedau’r cynllun, llai symiau sydd wedi’u cynnwys mewn llog net, eu datgelu fel enillion a cholledion actiwaraidd.
Mae cost y cynllun â buddion wedi’u diffinio, a gydnabyddir mewn gwariant fel costau staff, ac eithrio pan gaiff ei gynnwys yng nghost ased, yn cynnwys y cynnydd o ran y rhwymedigaeth buddion pensiwn sy’n deillio o wasanaeth gweithwyr yn ystod y cyfnod a chost cyflwyno i’r cynllun, newidiadau i fuddion, cwtogiadau, a setliadau. Cyfrifir cost llog net trwy gymhwyso’r gyfradd ddisgowntio i’r rhwymedigaeth net. Cydnabyddir y gost hon mewn gwariant fel cost cyllid.
Darperir rhagor o fanylion am y cynlluniau pensiwn penodol yn Nodyn 29 y cyfrifon.
8. Buddion cyflogaeth
Caiff buddion cyflogaeth tymor byr, megis cyflogau ac absenoldebau digolledol eu cydnabod fel traul yn y flwyddyn pryd y rhoddodd y gweithwyr wasanaeth i’r Brifysgol. Cronnir unrhyw fuddion na ddefnyddir a’u mesur fel y swm ychwanegol y mae’r Brifysgol yn disgwyl ei dalu o ganlyniad i hawl na ddefnyddiwyd.
9. Prydlesi cyllidol
Caiff prydlesi lle mae’r Brifysgol yn ysgwyddo yn eu hanfod yr holl risgiau a’r gwobrau sy’n gysylltiedig â bod yn berchen ar yr ased ar brydles eu dosbarthu fel prydlesi cyllidol. Mae asedau ar brydles a gafodd eu caffael drwy brydles gyllidol a rhwymedigaethau’r prydlesi hynny’n cael eu cydnabod yn y lle cyntaf ar swm sy’n hafal â’r isaf o blith eu gwerth teg a gwerth presennol y taliadau prydles isaf ar gychwyniad y brydles.
Caiff y taliadau prydles isaf eu dosrannu rhwng y tâl cyllid a’r gostyngiad yn y rhwymedigaeth sy’n ddyledus. Pennir y tâl cyllid i bob cyfnod yn ystod oes y brydles er mwyn rhoi cyfradd gyfnodol gyson o log ar y balans sy’n weddill o’r rhwymedigaeth.
10. Trefniadau Consesiwn Gwasanaeth Mae trafodion Mentrau Cyllid Preifat (PFI), sydd o fewn diffiniad trefniant consesiwn gwasanaeth, yn cael eu cyfrifo fel bod ‘ar y Fantolen’ gan y Brifysgol. Caiff yr asedau sylfaenol eu cydnabod fel Asedau Sefydlog ar eu
Datganiad Prif Bolisïau Cyfrifo (parhad)
Y flwyddyn yn diweddu 31 Gorffennaf 2022
gwerth teg fel y pennir hynny ym model y gweithredwyr. Cydnabyddir rhwymedigaeth ariannol gyfwerth yn unol â FRS 102.
Caiff taliadau blynyddol y contract eu dosrannu rhwng ad-dalu’r rhwymedigaeth, cost cyllid a’r taliadau am wasanaethau. Cyfrifir y gost cyllid gan ddefnyddio’r gyfradd llog ymhlyg ar gyfer y cynllun.
Caiff y tâl gwasanaeth ei gydnabod yn y treuliau gweithredu a chodir y gost cyllid i Gostau Cyllid yn y Datganiad o Incwm Cynhwysfawr.
Caiff elfen o’r cynnydd yn y tâl unedol blynyddol o ganlyniad i fynegeio cronnus ei dyrannu i’r brydles gyllidol. Yn unol â FRS 102, ni chaiff y swm hwn ei gynnwys yn y taliadau prydles isaf, ond yn hytrach caiff ei drin fel rhent amodol. Mewn gwirionedd, mae’r swm hwn yn gost cyllid mewn perthynas â’r rhwymedigaeth a chyflwynir y draul fel cost cyllid amodol yn y Datganiad o Incwm Cynhwysfawr.
Caiff costau adnewyddu cylch oes eu cydnabod mewn treuliau gweithredu yn seiliedig ar y rhaglen adnewyddu y mae’r gweithredwyr wedi ei chynllunio.
11. Prydlesi gweithredol
Codir costau’n ymwneud â phrydlesi gweithredol ar sail llinell syth dros gyfnod y brydles. Caiff unrhyw bremiymau neu gymhellion prydles eu gwasgaru dros y cyfnod prydlesu lleiaf.
12. Arian tramor
Caiff trafodion mewn arian tramor eu trosi i arian swyddogaethol endidau’r Grŵp ar y gyfradd gyfnewid dramor ar ddyddiad y trafodyn. Caiff asedau ariannol a rhwymedigaethau mewn arian tramor ar ddyddiad y fantolen eu trosi i’r arian swyddogaethol ar y gyfradd gyfnewid dramor ar y dyddiad hwnnw. Caiff gwahaniaethau cyfnewid tramor a geir wrth drosi eu cydnabod fel Gwarged neu Ddiffyg.
Caiff asedau a rhwymedigaethau anariannol a fesurir yn nhermau cost hanesyddol mewn arian tramor eu trosi gan ddefnyddio’r gyfradd gyfnewid ar ddyddiad y trafodyn. Caiff asedau a rhwymedigaethau anariannol mewn arian tramor a gaiff eu datgan ar werth teg eu haildrosi i’r arian swyddogaethol ar gyfraddau cyfnewid tramor ar y dyddiadau y pennwyd y gwerth teg.
13. Eiddo, Peirianwaith ac Offer
Tir ac adeiladau
Caiff tir ac adeiladau eu cyfalafu ar gost wrth eu cydnabod y tro cyntaf.
Ar ôl cael eu cydnabod y tro cyntaf caiff tir ac adeiladau eu mesur ar gost dybiedig llai dibrisiad cronedig a cholledion amhariad cronedig.
Cafodd rhai tiroedd ac adeiladau eu hailbrisio i werth teg ar ddyddiad y trawsnewid i FE HE SORP 2015, ac fe’u mesurir ar sail cost dybiedig, sef swm yr ailbrisiad ar ddyddiad yr ailbrisiad hwnnw. Gwnaed y prisiad gan gwmni proffesiynol cymwys o Syrfewyr Siartredig. Ni chafodd rhai asedau eu cynnwys yn y prisiad gan eu bod yn cael eu hystyried i’w gwaredu, eu dymchwel neu eu hadnewyddu’n sylweddol.
Caiff costau a gafwyd mewn perthynas â thir ac adeiladau ar ôl y prynu neu’r adeiladu cychwynnol eu cyfalafu i’r graddau eu bod yn cynyddu’r buddion a ddisgwylir i’r Brifysgol yn y dyfodol.
Ni ddibrisir tir rhydd-ddaliol gan yr ystyrir bod iddo oes fuddiol amhenodol. Oni bai eu bod yn cael eu cydrannu, caiff adeiladau rhydd-ddaliol eu dibrisio ar sail llinell syth dros eu hoes fuddiol ddisgwyliedig fel a ganlyn:
Adeiladau 50 mlynedd
Adnewyddiadau i adeiladau 15 mlynedd
Datganiad Prif Bolisïau Cyfrifo (parhad)
Y flwyddyn yn diweddu 31 Gorffennaf 2022
Lle bo’n briodol, caiff adeiladau eu cydrannu’n dair rhan: adeiladwaith, ffitiadau ac elfennau mecanyddol a pheirianegol. Nodir y rhain fel eitemau ar wahân o asedau sefydlog a chaiff pob rhan ei dibrisio ar sail llinell syth dros gyfnod eu hoes fuddiol:
Adeiladwaith Hyd at 50 mlynedd
Ffitiadau Hyd at 20 mlynedd
Elfennau Mecanyddol a Pheirianegol Hyd at 20 mlynedd
Pan fo eitem o dir ac adeiladau’n cynnwys dwy neu ragor o brif elfennau a chanddynt oes economaidd ddefnyddiol sy’n sylweddol wahanol i’w gilydd, mae pob elfen yn cael ei chyfrif ar wahân a’i dibrisio dros ei hoes economaidd ddefnyddiol unigol. Mae gwariant sy’n ymwneud ag amnewid elfennau wedi hynny yn cael ei gyfalafu wrth i hynny ddigwydd.
Dibrisir gwelliannau i eiddo prydles dros gyfnod oes y brydles.
Ni chodir dibrisiad ar asedau sydd wrthi’n cael eu hadeiladu.
Adolygir dulliau dibrisio, oes fuddiol a gwerthoedd gweddilliol ar ddyddiad paratoi pob Datganiad Sefyllfa Ariannol.
Offer
Caiff offer ei gyfalafu ar gost wrth eu cydnabod y tro cyntaf ac wedi hynny ar gost llai dibrisiad cronedig a cholledion amhariad cronedig.
Caiff offer, gan gynnwys cyfrifiaduron a meddalwedd, sy’n costio llai na £10,000 fesul eitem unigol de minimus, neu grŵp o eitemau cysylltiedig, ei gydnabod fel gwariant. Caiff pob offer arall eu cyfalafu.
Nodir offer a gyfalafwyd ar gost a chaiff ei ddibrisio dros ei oes fuddiol ddisgwyliedig fel a ganlyn:
Offer Cyfrifiadurol
Offer ar gyfer projectau ymchwil penodol
5 mlynedd
5 mlynedd
Cyfarpar arall Hyd at 10 mlynedd
Cerbydau modur 5 mlynedd
Adolygir dulliau dibrisio, oes fuddiol a gwerthoedd gweddilliol ar ddyddiad paratoi pob Datganiad Sefyllfa Ariannol.
Amhariad
Adolygir amhariad i eiddo, peirianwaith ac offer os oes digwyddiadau neu newidiadau mewn amgylchiadau yn dangos efallai na fydd modd adennill swm cario eiddo, peirianwaith ac offer.
Costau benthyca
Cydnabyddir costau benthyca fel gwariant yn y cyfnod pryd maent yn digwydd.
14. Asedau treftadaeth
Mae’r Brifysgol yn berchen ar gasgliad helaeth o weithiau celf, a chasgliadau amgueddfa eraill, yn cynnwys llestri, offerynnau cerdd, eitemau byd natur, arteffactau daearegol a llawysgrifau, sydd gan mwyaf wedi eu rhoi neu eu gadael i’r Brifysgol yn ystod y 130 mlynedd ddiwethaf. Nid yw’r eitemau hyn wedi eu cynnwys yn y datganiadau ariannol gan fod y Brifysgol yn ystyried na fyddai’n ymarferol cael prisiad ystyrlon ohonynt yn y rhan fwyaf o achosion, oherwydd eu natur unigryw. Ychydig iawn o asedau treftadaeth y gallai’r Brifysgol eu gwerthu oherwydd natur gyfyngiadol eu caffael. Rhoddir rhagor o wybodaeth yn Nodyn 12. Nodir cost cadwraeth ac adfer y casgliad treftadaeth yn y Datganiad o Incwm Cynhwysfawr am y flwyddyn pryd y digwyddodd.
15. Buddsoddiadau
Rhoddir buddsoddiadau asedau anghyfredol mewn gwarantau heb eu rhestru ar y Datganiad Sefyllfa Ariannol ar gost llai amhariad.
Prif Bolisïau Cyfrifo (parhad)
Y flwyddyn yn diweddu 31 Gorffennaf 2022
Caiff buddsoddiadau mewn endidau a reolir ar y cyd, cwmnïau cysylltiedig ac is-gwmnïau eu cario ar gost llai amhariad yn Natganiadau Ariannol y Brifysgol.
Rhoddir buddsoddiadau yn y Datganiad Sefyllfa Ariannol fel asedau ariannol sylfaenol a chânt eu mesur yn unol â Nodyn 18 y polisi cyfrifyddu.
16. Stoc
Caiff stoc ei ddal ar yr isaf o blith cost a gwerth gwireddadwy net, a chaiff ei fesur yn defnyddio fformiwla costau cyfartalog.
17. Arian parod a chywerthoedd arian parod
Mae arian parod yn cynnwys arian mewn llaw ac adneuon sy’n ad-daladwy ar gais. Mae adneuon yn ad-daladwy ar gais os ydynt ar gael o fewn 24 awr heb gosb.
Buddsoddiadau tymor byr hynod hylifol yw cywerthoedd arian parod y gellir eu trosi’n rhwydd i symiau hysbys o arian parod heb risg sylweddol y bydd newid mewn gwerth.
18. Darpariaethau, rhwymedigaethau amodol ac asedau amodol
Cydnabyddir darpariaethau yn y datganiadau ariannol pan:
(a) mae gan y Brifysgol rwymedigaeth bresennol (cyfreithiol neu trwy ddehongliad) o ganlyniad i ddigwyddiad yn y gorffennol;
(b) mae’n debygol y bydd angen all-lif o fuddion economaidd i setlo’r rhwymedigaeth; a
(c) gellir gwneud amcangyfrif dibynadwy o swm y rhwymedigaeth.
Pennir y swm a gydnabyddir fel darpariaeth drwy ddisgowntio’r llifoedd arian disgwyliedig yn y dyfodol ar gyfradd cyn treth sy’n adlewyrchu risgiau penodol i’r rhwymedigaeth.
Mae rhwymedigaeth amodol yn codi o ddigwyddiad yn y gorffennol sy’n rhoi rhwymedigaeth bosibl i’r Brifysgol ond y cadarnheir ei bodolaeth yn unig gan ddigwyddiadau ansicr yn y dyfodol, neu fel arall, na fydd yn llwyr o fewn rheolaeth y Brifysgol. Mae rhwymedigaethau amodol yn codi hefyd mewn amgylchiadau lle byddai darpariaeth yn cael ei gwneud fel arall, ond naill ai nid yw’n debygol y bydd angen all-lif o adnoddau neu ni ellir mesur swm y rhwymedigaeth mewn modd dibynadwy.
Mae ased amodol yn codi pan fo digwyddiad wedi digwydd sy’n rhoi ased posibl i’r Brifysgol ond y cadarnheir ei bodolaeth yn unig gan ddigwyddiadau ansicr yn y dyfodol, neu fel arall, na fydd yn llwyr o fewn rheolaeth y Brifysgol.
Ni chaiff asedau a rhwymedigaethau amodol eu cydnabod yn y Fantolen ond maent yn cael eu datgelu yn y Nodiadau.
19. Cyfrifo ar gyfer Gweithrediadau ar y Cyd, Asedau a Reolir ar y Cyd a Gweithrediadau a Reolir ar y Cyd
Mae’r Brifysgol yn defnyddio’r dull ecwiti i roi cyfrif am ei chyfran o fentrau ar y cyd.
Mae’r Brifysgol yn rhoi cyfrif am ei chyfran o drafodion o weithrediadau ar y cyd ac asedau a reolir ar y cyd yn y Datganiad Cyfunol o Incwm a Gwariant.
20. Trethiant
Caiff y dreth gyfredol, gan gynnwys treth gorfforaeth y Deyrnas Unedig a threth dramor, ei darparu ar symiau y disgwylir eu talu (neu eu hadennill) gan ddefnyddio’r cyfraddau treth a’r cyfreithiau a ddeddfwyd erbyn dyddiad y fantolen.
Ystyrir bod y Brifysgol yn pasio’r profion a nodir ym Mharagraff 1 Atodlen 6 o Ddeddf Gyllid 2010 ac felly mae’n cyflawni’r diffiniad o gwmni elusennol i ddibenion treth gorfforaethol y Deyrnas Unedig. Felly, mae’r Brifysgol o bosibl wedi ei heithrio o drethiant mewn perthynas ag incwm neu enillion cyfalaf a dderbyniwyd o fewn categorïau a ddaw dan adran 478-488 Deddf Treth Gorfforaeth 2010 (CTA 2010) neu adran 256 Deddf
Datganiad Prif Bolisïau Cyfrifo (parhad)
Y flwyddyn yn diweddu 31 Gorffennaf 2022
Trethiant Enillion Trethadwy 1992, i’r graddau y defnyddir y cyfryw incwm neu enillion i ddibenion elusennol yn unig.
21. Offerynnau Ariannol
Mae’r Brifysgol wedi dewis mabwysiadu Adrannau 11 a 12 FRS 102 mewn perthynas â chydnabod, mesur a datgelu offerynnau ariannol.
Cydnabyddir asedau a rhwymedigaethau ariannol pan ddaw’r Brifysgol yn rhan o ddarpariaeth gontractol yr offeryn, ac fe’u dosbarthir yn ôl sylwedd y trefniadau contractol yr ymrwymwyd iddynt.
Caiff ased ariannol a rhwymedigaeth ariannol eu gwrthbwyso dim ond pan fo hawl y gellir ei gorfodi’n gyfreithiol i wrthbwyso’r symiau a gydnabyddir a bwriad naill ai i setlo ar sail net, neu i wireddu’r ased a setlo’r rhwymedigaeth ar yr un pryd.
Asedau ariannol
Mae asedau ariannol sylfaenol yn cynnwys symiau masnach a symiau derbyniadwy eraill, arian parod a chywerthoedd arian parod, a buddsoddiadau mewn papur masnachol (h.y. adneuon a bondiau). Caiff yr asedau hyn eu cydnabod y tro cyntaf ar bris y trafodyn oni bai bod y trefniant yn drafodyn cyllido, pan gaiff y trafodyn ei fesur yn ôl gwerth presennol y derbyniadau yn y dyfodol wedi’u disgowntio ar gyfradd llog y farchnad. Yn dilyn hynny, caiff asedau o’r fath eu cario ar gost wedi’i hamorteiddio gan ddefnyddio’r dull cyfradd llog effeithiol. Asesir asedau ariannol i weld a oes arwyddion o amhariad ar bob dyddiad adrodd. Os oes tystiolaeth wrthrychol bod amhariad, caiff colled amhariad ei chydnabod yn y Datganiad o Incwm Cynhwysfawr
Yn achos asedau ariannol sy’n cael eu cario ar gost wedi’i hamorteiddio y golled amhariad yw’r gwahaniaeth rhwng swm cario’r ased a gwerth presennol llifoedd arian amcangyfrifedig yn y dyfodol, wedi’i ddisgowntio ar gyfradd llog effeithiol wreiddiol yr ased.
Mae asedau ariannol eraill, gan gynnwys buddsoddiadau mewn offerynnau ecwiti nad ydynt yn is-gwmnïau, yn gwmnïau cysylltiedig nac yn fentrau ar y cyd, yn cael eu mesur y tro cyntaf ar werth teg, sef pris y trafodyn fel arfer. Wedi hynny, caiff yr asedau hyn eu cario ar werth teg a chaiff newidiadau mewn gwerth teg ar y dyddiad adrodd eu cydnabod yn y datganiad o incwm cynhwysfawr. Pan nad yw’r buddsoddiad mewn offerynnau ecwiti’n cael ei fasnachu’n gyhoeddus a phan na ellir mesur y gwerth teg yn ddibynadwy, caiff yr asedau eu mesur ar gost llai amhariad.
Caiff asedau ariannol eu dad-gydnabod pan fo hawliau contractol i lifoedd arian o’r ased yn dod i ben neu’n cael eu setlo neu pan fo holl risgiau a manteision bod yn berchen ar yr ased yn cael eu trosglwyddo yn eu hanfod i barti arall.
Rhwymedigaethau ariannol
Mae rhwymedigaethau ariannol sylfaenol yn cynnwys symiau masnach a symiau taladwy eraill, benthyciadau banc a benthyciadau rhyng-grŵp. Caiff y rhwymedigaethau hyn eu cydnabod y tro cyntaf ar bris y trafodyn oni bai bod y trefniant yn drafodyn cyllido, pan gaiff yr offeryn dyled ei fesur ar werth presennol taliadau yn y dyfodol wedi’u disgowntio ar gyfradd llog y farchnad. Yn dilyn hynny, caiff offerynnau dyled eu cario ar gost wedi’i hamorteiddio gan ddefnyddio’r dull cyfradd llog effeithiol.
Caiff ffioedd a delir wrth sefydlu cyfleusterau benthyciad eu cydnabod fel costau trafod y benthyciad i’r graddau ei bod yn debygol y bydd peth neu’r cyfan o’r cyfleuster yn cael ei dynnu i lawr.
Rhwymedigaethau yw symiau masnach taladwy i dalu am nwyddau a gwasanaethau a gafwyd fel rhan o’r busnes arferol oddi wrth gyflenwyr. Dosberthir cyfrifon taladwy fel rhwymedigaethau cyfredol os ydynt yn daladwy o fewn blwyddyn neu lai. Os nad ydynt, cânt eu cyflwyno fel rhwymedigaethau anghyfredol. Caiff symiau masnach taladwy eu cydnabod y tro cyntaf ar bris y trafodyn ac wedi hynny cânt eu mesur ar gost wedi’i hamorteiddio gan ddefnyddio’r dull cyfradd llog effeithiol.
Nid yw deilliadau ariannol, gan gynnwys blaen-gontractau cyfnewid tramor, yn offerynnau ariannol sylfaenol. Caiff deilliadau ariannol eu cydnabod y tro cyntaf ar werth teg ar ddyddiad ymrwymo i’r contract deilliadol
Datganiad Prif Bolisïau Cyfrifo (parhad)
Y flwyddyn yn diweddu 31 Gorffennaf 2022
ac wedi hynny cânt eu hail-fesur yn ôl eu gwerth teg ar y dyddiad adrodd. Caiff newidiadau yng ngwerth teg deilliadau ariannol eu cydnabod yn y Datganiad o Incwm Cynhwysfawr mewn costau cyllid neu incwm cyllid fel y bo’n briodol, oni bai eu bod wedi eu cynnwys mewn trefniant ymddiogelu.
I’r graddau y mae’r Brifysgol yn ymrwymo i flaen-gontractau cyfnewid tramor sy’n parhau i fod heb eu setlo ar y dyddiad adrodd, adolygir gwerth teg y contractau ar y dyddiad hwnnw. Mesurir y gwerth teg cychwynnol fel pris y trafodyn ar ddyddiad sefydlu’r contractau. Caiff prisiadau dilynol eu hystyried ar sail blaen-gyfraddau’r contractau hynny sydd heb eu setlo ar y dyddiad adrodd. Nid yw’r Brifysgol yn defnyddio cyfrifyddu ymddiogelu mewn perthynas â blaen-gontractau cyfnewid tramor a ddelir er mwyn rheoli achosion o amlygu llifoedd arian i drafodion arian tramor sy’n cael eu rhagweld.
Caiff rhwymedigaethau ariannol eu dad-gydnabod pan fydd y rhwymedigaeth yn cael ei rhyddhau, ei chanslo neu pan ddaw i ben.
22. Cronfeydd wrth gefn
Dosberthir cronfeydd yn rhai cyfyngedig neu anghyfyngedig. Mae cronfeydd gwaddol cyfyngedig yn cynnwys rhai balansau sydd, drwy waddol i’r Brifysgol, yn cael eu dal fel cronfa gyfyngedig barhaol y mae’n rhaid i’r Brifysgol ei dal yn fythol barhaus.
Mae cronfeydd cyfyngedig eraill yn cynnwys balansau lle mae’r rhoddwr wedi pennu diben penodol ac felly mae’r Brifysgol wedi ei chyfyngu o ran defnyddio’r cyllid hwn.
23. Barn gyfrifyddu gritigol a ffynonellau allweddol ansicrwydd amcangyfrif Wrth baratoi datganiadau ariannol y Brifysgol mae angen i’r rheolwyr ffurfio barn a gwneud amcangyfrifon a thybiaethau sy’n effeithio ar sut y defnyddir polisïau cyfrifo ac ar symiau asedau a rhwymedigaethau, incwm a threuliau yr adroddir amdanynt. Mae’r farn, yr amcangyfrifon a’r tybiaethau hyn yn seiliedig ar brofiad hanesyddol a ffactorau eraill, gan gynnwys disgwyliadau o ran digwyddiadau yn y dyfodol y credir eu bod yn rhesymol o dan yr amgylchiadau. Anaml, trwy ddiffiniad, y bydd yr amcangyfrifon cyfrifyddu a geir yn hafal i’r canlyniadau gwirioneddol cysylltiedig.
Mae’r rheolwyr o’r farn mai’r meysydd a nodir isod yw’r rhai lle cafodd barn gyfrifyddu gritigol ei defnyddio a gall yr amcangyfrifon a’r tybiaethau sy’n deillio o hynny arwain at addasiadau i symiau cario asedau a rhwymedigaethau yn y dyfodol:
Cydnabod incwm
Defnyddir barn wrth bennu gwerth ac amseriad rhai eitemau incwm sydd i’w cydnabod yn y datganiadau ariannol. Mae hyn yn cynnwys penderfynu pryd y mae amodau sy’n gysylltiedig â pherfformiad wedi cael eu bodloni, a phenderfynu ar y refeniw sy’n gysylltiedig â chyrsiau a hyfforddiant a gyflwynwyd yn rhannol pan nad yw’r gweithgareddau wedi’u cwblhau’n llawn ar y dyddiad adrodd.
Oes fuddiol eiddo, peirianwaith ac offer
Mae eiddo, peirianwaith ac offer yn cynrychioli cyfran sylweddol o gyfanswm asedau’r Brifysgol. Felly, gall amcangyfrif oes fuddiol gael effaith sylweddol ar y dibrisiad a godir ac ar y perfformiad y mae’r Brifysgol yn adrodd yn ei gylch. Pennir oes fuddiol pan gaiff ased ei chaffael a chaiff ei adolygu’n rheolaidd o ran priodoldeb. Mae’r oes yn seiliedig ar brofiad hanesyddol o ymwneud ag asedau tebyg yn ogystal â rhagweld digwyddiadau yn y dyfodol. Dangosir manylion gwerthoedd cario eiddo, peirianwaith ac offer yn Nodyn 11.
Adenilladwyedd dyledwyr
Mae’r ddarpariaeth ar gyfer dyledion amheus yn seiliedig ar amcangyfrif i ba raddau y gellir adennill y dyledion hynny. Mae’r ddarpariaeth yn seiliedig ar sefyllfa bresennol y cwsmer, proffil oedran y ddyled a natur y swm sy’n ddyledus.
Mae balans Symiau Masnach Derbyniadwy, Nodyn 17, y Brifysgol yn datgelu’r swm sy’n ddyledus i’r Brifysgol ac i’r Grŵp ar ôl didynnu’r ddarpariaeth drwgddyled o £3,225k (2021: £2,809k) a £3,225k (2021: £2,904k) yn y drefn honno. Mae’r ddarpariaeth drwgddyled yn ymwneud yn bennaf â ffioedd neuaddau a ffioedd dysgu sy’n ddyledus gan fyfyrwyr.
Mae’r rheolwyr wedi adolygu dyledion unigol ac wedi asesu i ba raddau y gellid eu hadennill gan ystyried oedran, statws y dyledwr, ac unrhyw wybodaeth berthnasol arall sy’n ymwneud â’r oedi wrth dalu. Cytundebau consesiwn gwasanaeth
Mae gan y Brifysgol ddau gytundeb consesiwn gwasanaeth ar ei Mantolen, sef cynlluniau Ffordd Ffriddoedd a’r Santes Fair (Nodyn 13). Cafwyd y rhwymedigaethau cyllid cysylltiedig drwy ddefnyddio offeryn modelu ar gyfer cytundebau consesiwn gwasanaeth dan gyfarwyddyd ymgynghorwyr proffesiynol y Brifysgol, gyda mewnbynnau’n deillio o’r modelau gweithredwyr a oedd yn sail i’r contractau a luniwyd â’r partneriaid o’r sector preifat. Mae gwerth yr asedau’n seiliedig ar gostau a gymerwyd o’r un modelau gweithredwyr, ac mae’r rhain yn cael eu hadolygu am amhariad bob blwyddyn. Ni chododd unrhyw amhariad yn 2020/21 (2019/20 - Dim).
Tybiwyd bod unrhyw wariant cylch oes yn refeniw yn ei natur yn seiliedig ar yr wybodaeth yn y modelau gweithredwyr.
Rhwymedigaethau buddion ymddeol
Darpariaeth pensiwn USS
Pennir cost cynlluniau pensiwn â buddion wedi’u diffinio yn defnyddio prisiadau actiwaraidd. Mae’r prisiad actiwaraidd yn golygu gwneud tybiaethau ynghylch cyfraddau disgowntio, codiadau cyflog yn y dyfodol, cyfraddau marwolaethau a chodiadau pensiwn yn y dyfodol. Oherwydd cymhlethdod y prisiad, y tybiaethau sylfaenol a natur tymor hir y cynlluniau hyn, mae ansicrwydd sylweddol yn gysylltiedig ag amcangyfrifon o’r fath. Rhoddir rhagor o fanylion yn Nodyn 29.
Mae’r rheolwyr yn fodlon bod Cynllun Pensiwn y Prifysgolion yn cyflawni’r diffiniad o gynllun aml-gyflogwr ac felly wedi cydnabod gwerth teg disgowntiedig y cyfraniadau contractol dan y cynllun ariannu sydd mewn bodolaeth ar ddyddiad cymeradwyo’r datganiadau ariannol.
Gan fod y Brifysgol yn rhwym o dan gontract i wneud taliadau adfer diffyg i’r USS, caiff hyn ei gydnabod fel rhwymedigaeth ar y fantolen. Ar hyn o bryd mae’r ddarpariaeth yn seiliedig ar gynllun adfer diffyg yr USS y cytunwyd arno ar ôl prisiad actiwaraidd 2017, sy’n diffinio’r taliad adfer diffyg sy’n ofynnol fel canran o gyflogau’r dyfodol tan 2034. Bydd y cyfraniadau hyn yn cael eu hailasesu ym mhrisiad y cynllun bob tair blynedd.
Mae’r ddarpariaeth yn seiliedig ar amcangyfrif y rheolwyr o chwyddiannau cyflog disgwyliedig yn y dyfodol, newidiadau yn nifer y staff a chyfradd gyffredinol y disgownt. Nodir manylion pellach yn Nodyn 29A.
Buddion ymddeol (BUPAS)
Mae sefyllfa’r rhwymedigaeth pensiwn, fel y ceir yn y cyfrifon, yn seiliedig ar nifer o asesiadau cymhleth ac ar farn yn ymwneud â chyfraddau disgowntio, codiadau cyflog rhagamcanol, newidiadau i oedrannau ymddeol, cyfraddau marwolaethau ac elw a ddisgwylir ar asedau’r cynllun. Mae’r Brifysgol yn cyflogi cwmni proffesiynol o actiwariaid i roi cyngor arbenigol ar y tybiaethau i’w gweithredu ac i gyfrifo rhwymedigaeth y cynllun.
Manylir ar y tybiaethau a ddefnyddir yn y flwyddyn gyfredol yn Nodyn 29B.
Mae’r cyfansymiau contractau a grantiau ymchwil yn cynnwys incwm a gydnabyddir yn llawn o £1.4m (2020/21 - £1.7m) a dderbyniwyd i grantiau cyfalaf lle mae amodau perfformiad wedi’u bodloni. Bydd yr offer cysylltiedig a brynwyd yn cael eu dibrisio dros 5 mlynedd yn unol â Pholisïau Cyfrifo’r Brifysgol.
Mae’r cyfansymiau contractau a grantiau ymchwil yn cynnwys incwm a gydnabyddir yn llawn o £1.4m (2020/21 - £1.7m) a dderbyniwyd i grantiau cyfalaf lle mae amodau perfformiad wedi’u bodloni. Bydd yr offer cysylltiedig a brynwyd yn cael eu dibrisio dros 5 mlynedd yn unol â Pholisïau Cyfrifo’r Brifysgol.
Nodiadau am y Datganiadau Ariannol (parhad)
Y flwyddyn yn diweddu 31 Gorffennaf 2022
Taliadau i’r Is-ganghellor 1 Awst 2021 i 31 Gorffennaf 2022:
Nodiadau am y Datganiadau Ariannol (parhad)
Y flwyddyn yn diweddu 31 Gorffennaf 2022
Staff rheoli allweddol
Staff rheoli allweddol yw’r bobl hynny sydd ag awdurdod a chyfrifoldeb dros gynllunio, cyfarwyddo a rheoli gweithgareddau’r Brifysgol. Mae costau staff yn cynnwys cyfraniadau’r cyflogwyr at bensiwn ac Yswiriant Gwladol.
Tâl yr Is-ganghellor fel cymhareb â chyflog yr holl weithwyr eraill ar
Dangosir taliadau i’r Is-ganghellor ar yr un sail â staff ar gyflogau uwch ond maent yn cynnwys cyfraniad y cyflogwr i gynllun adfer diffyg yr USS.
Penododd Cyngor y Brifysgol Is-ganghellor newydd o 1 Medi 2019 am gyfnod penodol o 5 mlynedd, y gellir ei adnewyddu, ac ar y sail mai £220,000 yw cyflog cychwynnol y swydd, heb unrhyw fuddion eraill y tu hwnt i’r rhai a dderbynnir gan aelodau eraill o’r staff. Wrth bennu cyflog yr Is-ganghellor, cymerodd y panel penodi Arolwg Cymdeithas Cyflogwyr y Prifysgolion a’r Colegau o Dâl Uwch Staff i ystyriaeth ynghyd ag Arolwg Pwyllgor Cadeiryddion Prifysgol o gyflogau Is-gangellorion.
Nid yw’r Is-ganghellor yn aelod o gynllun pensiwn yr USS ac felly ni wnaed unrhyw gyfraniadau cyflogwr yn y cyfnod hwn.
Caiff perfformiad yr Is-ganghellor ei fonitro trwy gydol y flwyddyn gan gynnwys gwerthusiadau perfformiad 1: 1 gyda Chadeirydd y Cyngor. Mae Cadeirydd y Cyngor yn gosod amcanion i’r Is-ganghellor yn unol â chyfeiriad strategol y Brifysgol.
Mae’r adolygiad blynyddol hefyd yn cynnwys adborth gan aelodau’r Cyngor a chan Bwyllgor Gweithredu’r Brifysgol. Y Pwyllgor Taliadau sy’n pennu ac yn adolygu tâl yr Is-ganghellor. Byddant yn ystyried fforddiadwyedd, gwybodaeth gymharol am daliadau yn y sector neu mewn mannau eraill, a metrigau perthnasol a data perfformiad. Bydd perfformiad uwch aelodau staff yn cael ei ystyried yn erbyn safonau a nodwyd.
Taliadau i staff ar gyflogau uwch, (ac eithrio’r Is-ganghellor a heb gynnwys cyfraniadau pensiwn y cyflogwr)
Cyfartaledd nifer staff fesul prif gategori: Rhif Rhif
yn ystod
Ar 31 Gorffennaf 2022 roedd 9 aelod o bersonél rheoli allweddol (20/21 - 9).
Aelodau’r Cyngor
Mae aelodau cyngor y Brifysgol yn ymddiriedolwyr i ddibenion cyfraith elusennol. Oherwydd natur gweithrediadau’r Brifysgol a chyfansoddiad y Cyngor, wedi eu tynnu o sefydliadau’r sector cyhoeddus a’r sector preifat yn lleol, mae’n anorfod y gwneir trafodion lle y gallai aelod o’r Cyngor fod â budd ynddynt.
Cynhelir yr holl drafodion yn ymwneud â sefydliadau y gall aelod o’r Cyngor fod â budd ynddynt o hyd braich ac yn unol â Rheoliadau Ariannol y Brifysgol a threfn caffael arferol. Nodir isod werth y trafodion hyn a adlewyrchir yn y cyfrifon am y flwyddyn yn diweddu 31 Gorffennaf 2022:
Sefydliad Enw Swydd Incwm Gwariant Dyledus oddi wrth/(i) ar
Mynegir niferoedd staff fel niferoedd cyfwerth ag amser llawn.
Ni thalwyd iawndal am golli swydd i unrhyw gyn weithiwr ar gyflog uwch o dan delerau cynllun diswyddo gwirfoddol safonol y Brifysgol (2020/21 talwyd 2 - £80,441).
Ni
unrhyw aelod lleyg o'r cyngor dâl gan y grŵp yn ystod y flwyddyn (2021 - dim).
Cyfanswm y treuliau a dalwyd i neu ar ran 3 aelod lleyg o'r Cyngor oedd £2,335 (2021 - 0). Mae hyn yn cynrychioli treuliau teithio wrth ddod i gyfarfodydd y Cyngor, ac i bwyllgorau a digwyddiadau eraill yn rhinwedd eu swydd.
Nodiadau am y Datganiadau Ariannol (parhad)
Y flwyddyn yn diweddu 31 Gorffennaf 2022
Nodiadau am y Datganiadau Ariannol (parhad)
Y flwyddyn yn diweddu 31 Gorffennaf 2022
Nodiadau am y Datganiadau Ariannol (parhad)
Y flwyddyn yn diweddu 31 Gorffennaf 2022
11 Eiddo, Peirianwaith ac Offer Tir ac Adeiladau Rhydd-ddaliol Gwelliannau Prydlesol Trefniant
Nodiadau am y Datganiadau Ariannol (parhad)
Y flwyddyn yn diweddu 31 Gorffennaf 2022
12 Asedau Treftadaeth
Mae gan y Brifysgol nifer o gasgliadau o Asedau Treftadaeth, yn cynnwys: Casgliadau Celf – oddeutu 600 o ddarluniau olew, dyfrlliw, printiau a lluniadau, yn ogystal â 9 o gerfluniau, yn dyddio o’r ail ganrif ar bymtheg i’r unfed ganrif ar hugain; Casgliad Cerameg - yn cynnwys oddeutu 500 o ddarnau sy’n cael eu harddangos ac wedi’u cadw; Casgliad Cerdd - oddeutu 600 o offerynnau cerdd ethnograffig, ynghyd â 325 o offerynnau clai cyn-Golumbaidd; Casgliad Daeareg - tua 8,000 o greigiau a 6,000 o ffosiliau o bob rhan o’r byd; Casgliad Astudiaethau Natur - yn cynnwys tua 40,000 o sbesimenau (gyda tua 500 yn cael eu harddangos); Casgliad Hynafiaethau Cymreig - a hynafiaethau eraill a arddangosir yn Amgueddfa ac Oriel Gelf Gwynedd; a Chasgliad Llawysgrifau - mae gan y Llyfrgell tua 16,500 o lyfrau prin neu o bwysigrwydd arbennig ac mae gan yr Adra– Archifau tua 80 o gasgliadau, y rhan fwyaf yn bapurau ystadau a theuluoedd o siroedd Gogledd Cymru, ynghyd â phapurau preifat unigolion amlwg a chasgliad amrywiol o gofnodion llenyddol, hanesyddol a hynafiaethol.
Mae Asedau Treftadaeth y Brifysgol yn cael eu cofnodi a chawsant eu prisio ar £12.3m at ddibenion yswiriant yn unig. Nid yw’r gwerth hwn yn cael ei adlewyrchu yn Natganiadau Ariannol y Brifysgol.
13 Trefniadau consesiwn gwasanaeth
Mae gan y Brifysgol ddau drefniant consesiwn gwasanaeth ar y Fantolen, sef safleoedd y Santes Fair a Ffordd Ffriddoedd, lle mae darparu gwasanaeth wedi dechrau.
Symudiad yn asedau trefniant consesiwn gwasanaeth
Gwerth ased y consesiynau gwasanaeth a gynhwysir ar y Fantolen ar 31 Gorffennaf 2022 yw £57,628k (1 Awst 2021 £59,093k). Mae’r gostyngiad o £1,465k yn deillio o daliadau dibrisiad yn ystod y flwyddyn.
Symudiad yn rhwymedigaethau trefniant consesiwn gwasanaeth
Cyfanswm y rhwymedigaethau’n ymwneud â’r consesiynau gwasanaeth a gynhwysir ar y Fantolen ar 31 Gorffennaf 2022 oedd £60,466k (1 Awst 2021 £61,885k). Mae’r gostyngiad o £ 1,419k yn deillio o ad-daliadau yn ystod y flwyddyn.
Ymrwymiadau yn y dyfodol
Mae’r tabl canlynol yn dadansoddi ymrwymiadau’r Brifysgol yn y dyfodol mewn perthynas â threfniadau consesiwn gwasanaeth.
2022, roedd tir ac adeiladau rhydd-ddaliad yn cynnwys £38.6m (2021 - £38.7m) mewn perthynas
â thir rhydd-ddaliad ac nid yw wedi’i ddibrisio.
Asedau ar brydles a gynhwyswyd uchod: Gwerth Net ar Bapur: £’000
Mae’r nodiadau isod yn rhoi rhagor o wybodaeth am drefniadau cyfredol consesiwn gwasanaeth y Brifysgol ar y Fantolen:
a) Cynllun Ffordd Ffriddoedd
Ar 6 Hydref 2006 llofnododd y Brifysgol gontract 29 mlynedd gyda darparwr trydydd parti i ddarparu a chynnal a chadw llety i 1,136 o fyfyrwyr.
Caiff yr asedau a’r rhwymedigaethau’n ymwneud â’r cynllun hwn eu cydnabod ar Fantolen y Brifysgol.
Dechreuodd y gwasanaeth ar 1 Hydref 2009 a bydd y contract yn gorffen ar 30 Medi 2038.
b) Cynllun y Santes Fair
Ar 23 Gorffennaf 2014 llofnododd y Brifysgol gontract 40 mlynedd gyda darparwr trydydd parti i ddarparu a chynnal a chadw llety i 602 o fyfyrwyr.
Caiff yr asedau a’r rhwymedigaethau’n ymwneud â’r cynllun hwn eu cydnabod ar Fantolen y Brifysgol.
Dechreuodd y gwasanaeth ar 25 Medi 2015 a bydd y contract yn gorffen ar 24 Medi 2055.
Nodiadau am y Datganiadau Ariannol (parhad)
Y flwyddyn yn diweddu 31 Gorffennaf 2022
14 Buddsoddiadau Anghyfredol Is-gwmnïau
28) Cwmnïau
Nodiadau am y Datganiadau Ariannol (parhad)
Y flwyddyn yn diweddu 31 Gorffennaf 2022
15)
15 Buddsoddiad mewn mentrau ar y cyd Mae gan y Brifysgol gyfran o 50% (50,000 o gyfrannau cyffredin £1) yn P.Madog Offshore Services Limited, sef cwmni wedi’i gofrestru yn Lloegr, sy’n ymgymryd â hurio’r llong ymchwil. Cwmni cyd-fentro yw hwn y mae’r Brifysgol ac O.S. Energy (UK) Limited yn berchnogion cyfartal arno. Caiff y trefniant ei drin fel menter ar y cyd a’i gyfrifo gan ddefnyddio’r dull ecwiti, fel bod 50% o asedau a rhwymedigaethau gros y cwmni’n cael eu hymgorffori ym mantolen gyfunol y Brifysgol a 50% o’i incwm net yn cael ei adrodd yn Natganiad Cyfunol o Incwm Cynhwysfawr y Brifysgol
incwm a gwariant
Nodir buddsoddiadau anghyfredol ar gost ac eithrio cronfeydd a reolir gan y Brifysgol a nodir ar werth y farchnad.
Delir cronfeydd a reolir gyda UBS Asset Management (UK) Limited sydd wedi eu trwyddedu gan yr Awdurdod Ymddygiad Ariannol.
Nodiadau am y Datganiadau Ariannol (parhad)
Y flwyddyn yn diweddu 31 Gorffennaf 2022
croniadau ac incwm gohiriedig mae’r eitemau incwm canlynol sydd wedi eu gohirio nes bod amodau penodol sy’n gysylltiedig â pherfformiad wedi cael eu cyflawni.
Nodiadau am y Datganiadau Ariannol (parhad)
Y flwyddyn yn diweddu 31 Gorffennaf 2022
20 Credydwyr: symiau sy’n ddyledus ar ôl mwy nag un flwyddyn
Nodiadau am y Datganiadau Ariannol (parhad)
Y flwyddyn yn diweddu 31 Gorffennaf 2022
21 Darpariaethau ar gyfer rhwymedigaethau
Nodiadau am y Datganiadau Ariannol (parhad)
Y flwyddyn yn diweddu 31 Gorffennaf 2022
Diffyg y cynllun lleol
Roedd rhwymedigaethau â buddion wedi’u diffinio ar 1 Awst 2021 yn ymwneud â’r rhwymedigaethau dan gynllun pensiwn BUPAS y Brifysgol. Rhoddir rhagor o fanylion yn Nodyn 29B.
Diffyg USS
Mae’r rhwymedigaeth i ariannu diffyg hanesyddol Cynllun Pensiwn y Prifysgolion (USS) yn deillio o’r ymrwymiad contract gyda’r USS i ariannu taliadau adfer diffyg yn unol â’r cynllun adfer diffyg. Wrth gyfrifo’r ddarpariaeth hon, mae’r rheolwyr wedi amcangyfrif lefelau staff yn y dyfodol o fewn cynllun yr USS trwy gydol yr ymrwymiad contract a chwyddiant cyflogau.
Ar ôl cwblhau prisiad actiwaraidd 2020, cytunwyd ar gynllun adfer diffyg newydd a cheir rhagor o wybodaeth amdano yn Nodyn 29A. Mae’r cynllun newydd hwn yn gofyn am daliadau adfer diffyg sydd yn 6.2% o gyflogau dros y cyfnod 1
Ebrill 2022 hyd 31 Mawrth 2024 a bryd hynny bydd y gyfradd yn cynyddu i 6.3%.
Caiff rhagdybiaethau allweddol o ran cyfrifo’r rhwymedigaeth eu hamlinellu isod a darperir gwybodaeth bellach yn Nodyn 29A.
Cyfradd ddisgowntio 3.31% 0.87%
Twf cyflogau 4.50% 4.50%
Dadansoddiad sensitifrwydd
Fel y nodir yn y polisïau cyfrifo, caiff barn feirniadol ei ffurfio wrth amcangyfrif y rhwymedigaeth ar gyfer ariannu diffyg yr USS. Nodir isod sensitifrwydd y prif dybiaethau a ddefnyddir i fesur darpariaeth diffyg yr USS:
Nodiadau am y Datganiadau Ariannol (parhad)
Y flwyddyn yn diweddu 31 Gorffennaf 2022
Cyfalaf ac ymrwymiadau eraill Nid yw darpariaeth wedi ei gwneud ar gyfer yr ymrwymiadau cyfalaf canlynol ar 31 Gorffennaf 2022:
Nodiadau am y Datganiadau Ariannol (parhad)
Y flwyddyn yn diweddu 31 Gorffennaf 2022
29 Cynlluniau Pensiwn
Roedd gwahanol gategorïau staff yn gymwys i ymuno ag un o’r cynlluniau a ganlyn:
• Cynllun Pensiwn y Prifysgolion (USS)
• Cynllun Pensiwn ac Yswiriant Prifysgol Bangor 1978 (BUPAS)
• Cynllun pensiwn gweithleoedd y Llywodraeth (NEST)
Mae nifer fechan o staff yn parhau mewn cynlluniau eraill nad ydynt yn agored i aelodau newydd.
29A Cynllun Pensiwn y Prifysgolion
Mae’r sefydliad yn rhan o Gynllun Pensiwn y Prifysgolion (USS) sef y prif gynllun i’r rhan fwyaf o staff academaidd ac academaidd-gysylltiedig. Mae’r Cynllun yn gynllun pensiwn hybrid, sy’n darparu buddion wedi’u diffinio (ar gyfer pob aelod), yn ogystal â buddion cyfraniadau wedi’u diffinio. Cedwir asedau’r cynllun mewn cronfa ar wahân a weinyddir gan ymddiriedolwyr.
Cynllun aml-gyflogwr yw’r USS a rhoddir cyfrif amdano fel y nodir yn y polisïau cyfrifo.
Cyfanswm y gost a dalwyd i’r Datganiad Cyfunol o Incwm Cynhwysfawr yw £9.498m (2021: £9.486m). Y cyfraniadau adfer diffyg sy’n ddyledus o fewn blwyddyn i’r Sefydliad yw £0.9m (2021 - £0.76m).
Gwnaed y prisiad actiwaraidd llawn diweddaraf o adran Adeiladu Incwm Ymddeol y Cynllun ar 31 Mawrth 2020 (y dyddiad prisio) gan ddefnyddio’r dull rhagamcanu unedau.
Prisiad 2020 oedd y chweched prisiad i’r USS dan y drefn gyllido cynllun-benodol a gyflwynwyd gan Ddeddf Pensiynau 2004. Dan y drefn hon mae angen gynlluniau fabwysiadu amcan cyllido statudol, sef bod ag asedau digonol a phriodol ar gyfer eu darpariaethau technegol. Ar y dyddiad prisio, roedd gwerth asedau’r cynllun yn £66.5 biliwn ac roedd gwerth darpariaethau technegol y cynllun yn £80.6 biliwn, gan ddynodi diffyg o £14.1 biliwn a chymhareb ariannu o 83%.
Disgrifir y tybiaethau ariannol allweddol a ddefnyddiwyd ym mhrisiad 2020 isod. Nodir rhagor o fanylion yn y Datganiad Egwyddorion Ariannu.
Statws Cyfalaf Cyfrannau a Ddelir
Gwlad y Cofrestriad Prif Weithgaredd
Codiadau pensiwn (yn amodol ar derfyn isaf o 0%) Tybiaeth o’r Mynegai Prisiau Defnyddwyr plws 0.05%
Canolfan Datblygu Rheolaeth
Gogledd Orllewin Cymru Cyf. 100% 1 Gyfran Gyffredin £1 Cymru Cyrsiau rheolaeth, cynadleddau a llety
Codiadau pensiwn (Mynegai Prisiau Defnyddwyr)
Cyfraddau tymor-ddibynnol yn unol â’r gwahaniaeth rhwng cromliniau cynnyrch Llog Sefydlog a rhai Mynegai Gysylltiedig, llai: 1.1% y flwyddyn hyd 2030, gan leihau yn llinol gan 0.1% y flwyddyn hyd at wahaniaeth hirdymor o 0.1% y flwyddyn o 2040
Parc Gwyddoniaeth Menai
Cyfyngedig 100% 1 Gyfran Gyffredin £1 Cymru Datblygu parc gwyddoniaeth
The Shellfish Centre - Cyfyngedig trwy warant Cymru Prosesu pysgod cregyn ac ymchwil
Naturiol Bangor Limited
Daliad wedi ei gaffael ar gost o £50,000
20% 20 Cyfrannau cyffredin £1 Cymru Ymchwil i ddeunyddiau naturiol
Nid yw’r datganiadau ariannol yn cynnwys Naturiol Bangor Limited na The Shellfish Centre gan nad ystyrir bod canlyniadau ac asedau a rhwymedigaethau’r cwmnïau hyn yn faterol berthnasol.
Roedd UNDEB (Trading) Cyfyngedig yn segur yn 2021/22 ac ers hynny mae wedi cael ei ddirwyn i ben.
Cyfradd ddisgowntio (blaen-gyfraddau)
Cromlin cynnyrch gilt llog sefydlog plws: Cyn-ymddeol: 2.75% y flwyddyn
Ôl-ymddeol: 1.00% y flwyddyn
Mae’r prif dybiaeth ddemograffig a ddefnyddir yn gysylltiedig â thybiaethau marwolaethau. Mae’r tybiaethau hyn yn seiliedig ar ddadansoddiad o brofiad y cynllun a wnaed fel rhan o brisiad actiwaraidd 2020. Mae’r tybiaethau marwolaethau a ddefnyddir yn y ffigyrau hyn fel a ganlyn:
Prisiad 2020
Tabl Sylfaen Marwolaethau 101% o S2PMA “AMC00 (hyd 0) yn achos dynion a 112% o AFC00 (hyd 0) yn achos merched.
Gwelliannau i’r sylfaen marwolaethau yn y dyfodol
CMI_2019 gyda pharamedr llyfnhau o 7.5, ac ychwanegiad cychwynnol o 0.5% y flwyddyn a chyfradd gwelliant tymor hir o 1.8% y flwyddyn yn achos dynion ac 1.6% y flwyddyn yn achos merched.
Y disgwyliadau oes ar hyn o bryd i rai’n ymddeol yn 65 yw:
Nodiadau am y Datganiadau Ariannol (parhad)
Y flwyddyn yn diweddu 31 Gorffennaf 2022
29A Cynllun Pensiwn y Prifysgolion (parhad)
Mae sefyllfa ariannu’r cynllun wedi’i diweddaru ers hynny ar sail FRS102. Rhoddwyd cynllun adfer diffyg newydd ar waith fel rhan o brisiad 2020, sy’n gofyn am dalu 6.2% o gyflogau dros y cyfnod rhwng 1 Ebrill 2022 a 31 Mawrth 2024 pryd y bydd y gyfradd yn cynyddu i 6.3%. Mae’r rhwymedigaeth adfer diffyg yn 2022 yn adlewyrchu’r cynllun hwn. Cynhyrchwyd ffigyrau’r rhwymedigaeth gan ddefnyddio’r tybiaethau canlynol: 2022 2021 Cyfradd ddisgowntio
Mae cyfraddau cyfraniadau’r cyflogwyr fel a ganlyn: Dyddiad y daw i rym
1 Hydref 2019 i 30 Medi 2021
1 Hydref 2021 i 31 Mawrth 2022
1 Ebrill 2022 i 31 Mawrth 2024
1 Ebrill 2024 i 30 Ebrill 2038
29B Cynllun Pensiwn ac Yswiriant Prifysgol Bangor 1978 (BUPAS)
Mae’r Brifysgol yn gweithredu cynllun pensiwn budd diffiniedig i staff ategol a chefnogi, sef Cynllun Pensiwn ac Yswiriant Prifysgol Bangor 1978 (BUPAS). Ariennir y cynllun yn allanol a chafodd ei all-gontractio o Ail Gynllun Pensiwn y Wladwriaeth (S2P) tan 31 Mawrth 2016.
Gwnaed y prisiad actiwaraidd diweddaraf ar 1 Awst 2020 ac fe’i diweddarwyd at ddibenion FRS102 Adran 28, Buddion Gweithwyr, hyd at 31 Gorffennaf 2022 gan actiwari cymwysedig proffesiynol.
Yn ystod y flwyddyn, talodd y Brifysgol gyfraniadau i’r cynllun pensiwn ar gyfradd o 21.5% (2021: 19.5%). Cyfanswm cost y cyfraniadau a dalwyd gan y Brifysgol oedd £1,856k (2021: £1,765k).
Mae safon gyfrifeg FRS102 yn ei gwneud yn ofynnol, gan nad oes gan y Brifysgol hawl awtomatig i gael ad-daliad gwarged, fod gwarged cyfredol y cynllun yn cael ei gydnabod i’r graddau y gall y Brifysgol gael gwerth economaidd o’r gwarged ar ffurf y potensial o gyfraniadau gostyngol posibl yn y dyfodol. Cyfrifir y gwerth economaidd y gall y Brifysgol ei gael o’r gwarged fel y gwahaniaeth rhwng gwerth presennol y cyfraniadau y mae’r Brifysgol wedi ymrwymo i’w talu yn y dyfodol o dan y ddogfennaeth sydd mewn grym ar y dyddiad adrodd a gwerth presennol y buddion y disgwylir iddynt gronni yn y dyfodol (dros hyd gyrfa’r aelodau gweithredol) o fesur hynny ar y sail gyfrifo ar y dyddiad adrodd. Ar y sail hon, cafodd gwarged o £15,742k ei chydnabod yn llawn ar gyfer 2021/22.
Tybiaethau
Y tybiaethau ariannol a ddefnyddiwyd i gyfrifo rhwymedigaethau’r cynllun dan FRS102 yn y flwyddyn yn diweddu 31 Gorffennaf yw:
Nodiadau am y Datganiadau Ariannol (parhad)
Y flwyddyn yn diweddu 31 Gorffennaf 2022
29B Cynllun Pensiwn ac Yswiriant Prifysgol Bangor 1978 (parhad) Roedd prif gategorïau asedau’r cynllun fel a ganlyn:
Y dybiaeth anariannol fwyaf arwyddocaol yw lefel dybiedig hirhoedledd. Mae’r tabl isod yn dangos y tybiaethau
oes a ddefnyddiwyd yn yr asesiadau cyfrifo ar gyfer y flwyddyn yn diweddu 31 Gorffennaf yn seiliedig ar
a benywaidd yn 65 oed.
oes gan y cynllun unrhyw fuddsoddiadau yn y Brifysgol neu mewn unrhyw eiddo
gan y Brifysgol.
Nodiadau am y Datganiadau Ariannol (parhad) Y flwyddyn yn diweddu 31 Gorffennaf 2022
30 Trafodion partïon cysylltiedig
Wedi eu cynnwys yn y datganiadau ariannol mae trafodion ariannol gyda’r partïon cysylltiedig canlynol lle nad oes gan y Brifysgol fudd rheolaethol. Cynhelir yr holl drafodion o hyd braich ac yn unol â Rheoliadau Ariannol y Brifysgol a threfn caffael arferol. Nodir isod werth y trafodion hyn a adlewyrchir yn y cyfrifon am y flwyddyn yn diweddu 31 Gorffennaf 2022.
Sefydliad Nodyn Incwm Gwariant Dyledus oddi wrth/(i) ar 31 Gorffennaf 2022
£’000 £’000 £’000
Undeb y Myfyrwyr Prifysgol Bangor 170 1,623 (12)
P.Madog Offshore Services Limited 15 0 802 0
Datgelir trafodion eraill â phartïon cysylltiedig sy’n ymwneud ag aelodau o Gyngor y Brifysgol o dan Nodyn 7
31 Bwrsariaethau
Y Brifysgol yw’r asiant talu ar ran y Gwasanaeth Iechyd Gwladol a Llywodraeth Cymru mewn perthynas â bwrsariaethau a threuliau sydd ar gael i fyfyrwyr sy’n astudio nyrsio a hyfforddiant athrawon. Y symiau a dalwyd yw:
Nodiadau am y Datganiadau Ariannol (parhad) Y flwyddyn yn diweddu 31 Gorffennaf 2022
32 Offerynnau Ariannol (parhad) Ceir crynodeb isod o’r incwm a’r gwariant mewn perthynas â’r offerynnau ariannol:
Mae’r bwrsariaethau a’r alldaliadau cysylltiedig wedi eu heithrio o’r Datganiad o Incwm Cynhwysfawr.
Mae’r Brifysgol yn ymgymryd yn bennaf â thrafodion nad ydynt yn gymhleth neu rai tymor byr gan olygu y defnyddir offerynnau ariannol sylfaenol. O’r herwydd, mae’r Brifysgol o’r farn bod y risg sy’n gysylltiedig â’r asedau a’r rhwymedigaethau a amlinellir uchod yn gymharol isel. Mae’r asedau ariannol a fesurir ar gost yn bennaf ar ffurf arian parod neu gywerthoedd arian parod a ddelir gyda sefydliadau ariannol ar adnau. Mae asedau ariannol a fesurir ar werth y farchnad yn agored i’r risg y bydd newid ym mhrisiau’r farchnad. Rheolir y rhain yn weithredol gan reolwyr cronfeydd proffesiynol yn unol â strategaeth fuddsoddi a bennwyd gan y Brifysgol.
I gael rhagor o fanylion ynglŷn â’r telerau a’r amodau sy’n gysylltiedig â benthyciadau, cyfeiriwch at Nodyn 20. .
wedi'i hamorteiddio:
Nodiadau am y Datganiadau Ariannol (parhad)
Y flwyddyn yn diweddu 31 Gorffennaf 2022
33 Atodlen Cyfrifoldeb Ariannol Adran Addysg yr Unol Daleithiau (parhad) Cyfrifiad y Brif Gymhareb Wrth Gefn (parhad)
Asedau
Nodiadau am y Datganiadau Ariannol (parhad)
Y flwyddyn yn diweddu 31 Gorffennaf 2022
33 Atodlen Cyfrifoldeb Ariannol Adran Addysg yr Unol Daleithiau (parhad)
Cyfrifiad y Brif Gymhareb Wrth Gefn (parhad)
Asedau Gwariadwy Net (parhad): Y flwyddyn yn diweddu 31 Gorffennaf 2022 Y flwyddyn yn diweddu 31 Gorffennaf 2021
Llinellau cyfrifon Disgrifiad Nodiadau £'000 £'000 £'000 £'000
Cyfanswm Treuliau a Cholledion(parhad):
Datganiad o Newidiadau
mewn Ecwiti - Colled ar
Fuddsoddiadau + Cyfran
o'r gwarged gweithredu
mewn menter ar y cyd + Symudiad yn y
Ddarpariaeth Pensiwn
llai Nodyn 5 Incwm
Buddsoddi
Datganiad o Weithgareddau _ Anweithredol (Adenillion ar fuddsoddiad wedi'i neilltuo ar gyfer gwariant), Buddsoddiadau, yn net o enillion gwariant blynyddol (colled), Elfennau eraill o gostau pensiwn cyfnodol net, Newidiadau cysylltiedig â phensiwn ac eithrio pensiwn cyfnodol net, Newid yng ngwerth cytundebau llog rhanedig ac Enillion eraill (colled)(Cyfanswm o'r Datganiad o Weithgareddau cyn addasiadau)
Nodyn 5 Incwm
Buddsoddi llai
Datganiad o Newidiadau
mewn Ecwiti - Colled ar Fuddsoddiadau
o Newidiadau mewn Ecwiti - Symudiad yn y Ddarpariaeth
Datganiad o Weithgareddau - (Adenillion ar fuddsoddiad wedi'i neilltuo ar gyfer gwariant) a Buddsoddiadau, net o wariant blynyddol, enillion (colled)
Datganiad o Weithgareddau - Newidiadau cysylltiedig
-, Cyfanswm y Treuliau
- (Cyfanswm o'r
o Weithgareddau cyn addasiadau)
Nodyn 17 - Llinellau o Fentrau ar y Cyd anghyfunol
Nodyn 17 - Llinellau o Fentrau ar y Cyd anghyfunol
Sefyllfa Ariannol - Ewyllys da
Datganiad Sefyllfa Ariannol - Symiau derbyniadwy parti cysylltiedig a datgeliad nodyn parti cysylltiedig
Datganiad Sefyllfa Ariannol - Symiau derbyniadwy parti cysylltiedig a datgeliad
Nodiadau am y Datganiadau Ariannol (parhad) Y flwyddyn yn diweddu 31 Gorffennaf 2022
Cyfrifoldeb Ariannol Adran Addysg yr Unol Daleithiau (parhad)
y Brif Gymhareb Wrth Gefn (parhad)
